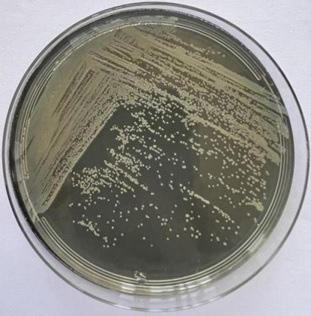
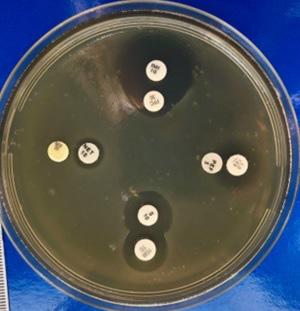
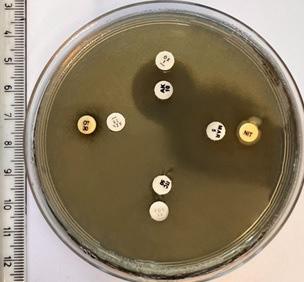

BDI INDEXED: "ROMANIAN JOURNAL OF VETERINARY MEDICINE & PHARMACOLOGY" PA FOST ÎNSCRISĂ ÎN CATALOGUL ROAD (HTTPS://ROAD.ISSN.ORG), CATALOG INTERNAȚIONAL AL PUBLICAȚIILOR ȘTIINȚIFICE OPEN-ACCESS, ADMINISTRAT DE CENTRUL INTERNAȚIONAL ISSN, SUB EGIDA UNESCO PÎNCEPÂND CU LUNA NOIEMBRIE 2021, A FOST INCLUSĂ ÎN EBSCO PUBLISHING DATABASE Romanian Journal of Veterinary Medicine & Pharmacology Anul VII / Vol. 7/ Nr. 37 (5) 2022 REVISTĂ EDITATĂ ÎN PARTENERIAT CU EDITURA Editura Etna este înscrisă în Societatea Editorilor Români. Acreditată de Consiliul Naţional al Cercetării Știinţifice din Învăţământul Superior (CNCSIS ) la poziția 241 şi de Colegiul Medicilor din România (CMR) CREDITATĂ DE www.rjvmf.innovationinhealth.ro 15 CREDITEEMC IMAGISTICA APARATULUI URINAR LACÂINE ȘIPISICĂ
n Casa Roka este o proprietate privata, amplasata in comuna Eselnita, Str. Teilor nr. 542a, judetul Mehedinti n Dispune de 3 camere cu o capacitate de cazare pentru 6 persoane. Fiecare camera este prevazuta cu pat matrimonial, baie proprie, uscator de par, TV cu ecran plat, WiFi gratuit, aer conditionat si terasa. Oaspetii beneficiaza de o bucatarie comuna, complet utilata. Casa Roka ofera facilitati de gratar, o curte si o terasa, WiFi, foisor acoperit pentru servit masa si este amplasata vizavi de Parculetul de joaca pentru copii. Parcare privata.







Se afla la o distanta de 6 km de Orsova, 28 km de Baile Herculane si la 5 km de Statuia lui Decebal. Puncte de atractie: se pot face excursii cu vaporul pe clisura Dunarii pentru a vizita Cazanele Dunarii si Pestera Ponicova, se pot vizita Manastirea Sfanta Ana, Manastirea Mraconia, Chipul lui Decebal.
La 100 m de proprietate se afla magazinul "La doi pasi", iar in Orsova (la 5 km de Eselnita) se afla magazinele Penny, Lidl si Carrefour.
Limbi vorbite: engleză, română Rezervarile pentru cazare la Casa Roka se fac pe minimum 2 sau 3 nopti.
Cafeaua este oferita gratuit, din partea casei, tuturor oaspetilor, pe parcursul intregului sejur.
Va
CAZARE!!! CASA ROKA OFERTA CAZARE!!! La achizitionarea a minimum 3 nopti de cazare, beneficiati de pretul redus de 150 de lei/1 noapte/1 camera. TELEFON REZERVARI: 0727 448 686 WEBSITE: https://casaroka.business.site/
asteptam cu drag! OFERTA
ATENȚIE LA BIOSECURITATEA DIN FERME ȘI DIN EXPLOATAȚIILE NONPROFESIONALE - NOI FOCARE DE PESTĂ PORCINĂ AFRICANĂ!
Autorității Naționale Sanitare Veterinare și pentru Siguranța Alimentelor (ANSVSA), în data de 02.11.2022 erau active, în România, 47 de focare de pestă porcină africană (PPA) la suine domestice. 44 erau în gospodăriile populației și 3 în exploatații comerciale mari (Timiș – 9; Iași – 6; Vâlcea – 5; Satu Mare și Teleorman – câte 3; Bihor, Galați, Gorj, Ialomița, Neamț și Suceava – câte 2; Buzău, Caraș-Severin, Constanța, Dolj, Maramueș, Olt, Prahova, Sălaj și Sibiu – câte 1).
Conform
O exploatație comercială este din județul Timiș (localitatea Parța), ce avea 39.191 de capete de porcine. Alte două sunt din județul Iași: cea din localitatea Belcești (fermă comercială de creștere și reproducție a suinelor plus abator) avea 19.983 de capete de porcine (conform site-ului ANSVSA) sau 19.967 capete porcine (conform comunicatului DSVSA Iași); cealaltă fermă ieșeană avea 3.566 de capete de porcine.
Boala a fost confirmată în luna octombrie, pentru toate cele 3 exploatații (dar în zile diferite; exploatația comercială din Timiș - 11.10.2022, prima exploatație comercială din Iași - 25.10.2022, a doua exploatație comercială din Iași - 27.10.2022), prin buletinele de analiză cu rezultat pozitiv pentru identificarea genomului virusului PPA emise de Laboratorul Național de Referință pentru PPA din cadrul Institutului de Diagnostic și Sănătate Animală București.
În raportul/comunicatul de presă ANSVSA (03.11.2022), publicat pe site, scrie clar pentru exploatația comercia-

EDITORIAL
Dragoș Marius CHIRIAC, Redactor-șef
lă din Timiș și pentru prima exploatație comercială din Iași: “Din datele preliminare ale anchetei epidemiologice, toate indiciile conduc la concluzia că cea mai probabilă cale de pătrundere a bolii este reprezentată de FACTORUL UMAN”. Pentru cea de-a doua exploatație comercială din Iași, raportul ANSVSA arată și mai clar situația: “Din datele anchetei epidemiologice, calea de pătrundere a bolii este reprezentată de popularea acestei ferme, în data de 23.10.2022, cu porcine provenite de la exploatația comercială din Iași confirmată cu PPA în data de 25.10.2022”.
De altfel, în Timiș au mai fost confirmate, în octombrie, focare în mai multe exploatații comerciale și nonprofesionale în Parța, Șag, Șandra, Dudeștii Vechi, Răuți (comuna Uivar), Murani (comuna Pișchia). Din unele comunicate de presă ale DSVSA Timiș reiese ideea că și în exploatațiile mai mici (profesionale ori nonprofesionale) tot factorul uman a fost cauza pătrunderii virusului.
De asemenea, ANSVSA arată, în același comunicat de presă, că mai sunt încă focare de PPA la mistreți.
Pentru toate cele trei ferme s-au luat măsurile ce se impuneau, conform Planului de Intervenție în Focar. Una din măsuri a fost, ca și la alte ferme ce s-au confruntat cu apariția PPA, eutanasierea întregului efectiv de animale. Deci mari pagube economice. Din păcate.
De la prima semnalare a prezenței virusului PPA în România, în data de 31 iulie 2017, și până în prezent se pare că unii medici veterinari, unii ingineri zootehniști, dar și unii manageri de mari exploatații comerciale de porcine sau de abatoare nu au înțeles ce înseamnă cu adevărat ca, într-o astfel de exploatație, să existe măsuri corecte de biosecuritate. De altfel, nu toți micii gospodari au înțeles pericolul reprezentat de PPA. Și în exploatațiile nonprofesionale de suine ale acestora nu sunt puse la punct măsurile de biosecuritate. De altfel, din informațiile pe care le dețin, veterinarii de circumscripții sanitare veterinare de asistență (CSVA) nu reușesc să îi convingă pe mulți gospodari (în special pe cei mai în vârstă) să respecte măsurile de biosecuritate.
Aș putea spune că nici în alte unități zootehnice (de ovine, caprine, bovine, aviare etc.) nu sunt puse la punct măsurile de biosecuritate. Și nici în abatoare. Informațiile despre biosecuritatea în fermele comerciale zootehnice ori în exploata-
EDITORIAL
țiile nonprofesionale de animale sunt pe site-urile ANSVSA și DSVSA. Este bine să fie transmise tuturor celor ce activează în sectorul zootehnic, dar și în sectoarele conexe. Ceea ce nu înțeleg deloc este faptul că, pe site-ul ANSVSA și pe site-urile DSVSA-urilor, nu sunt postate TOATE informațiile legate de fiecare boală descoperită la animale pe teritoriul României (pentru fiecare localitate în parte). Și nici pe site-urile prefecturilor nu există astfel de anunțuri/comunicate de presă. Comunicarea ANSVSA și a structurilor subordonate (DSVSA-uri) cu presa și cu cetățenii români (dar în special cu profesioniștii medici veterinari; ingineri zootehniști; manageri de ferme zootehnice; manageri de abatoare; manageri de firme de distribuție și de vânzare produse și subproduse de origine animală) nu este una corectă, adaptată situației. Am observat aceasta, mai ales începând din 31 iulie 2017 de când a fost confirmat primul caz de PPA în România. Încercam atunci (și încerc și acum) să aflu informații despre cazuri, dar informațiile erau (și sunt și acum) la un nivel minim. Nu înțeleg de ce, mai ales că ANSVSA raportează (este obligată) cazurile de boli la animale la Oficiul Internațional pentru Epizootii (World Organisation for Animal Health-OIE), informațiile fiind postate pe site-ul OIE. De altfel, informații sunt și pe site-ul Direcției Generale Sănătate și Siguranță Alimentară a Comisiei Europene (DG Sante), dar și pe site-urile unor autorități aflate în subordinea DG Sante. Informațiile despre bolile la animale de pe teritoriul național, dar și despre bolile la animale confirmate ca fiind prezente în zonele/țările apropiate României, trebuie centralizate pe site-ul ANSVSA, la secțiunea “Comunicate de presă”! Știu că ANSVSA este o instituție aflată în directa coordonare a primului-ministru, la fel ca și Ministerulul Agriculturii și Dezvoltării Rurale (MADR). Oare de ce cele două instituții nu colaborează pentru preluarea unor informații pentru ca unele comunicate de presă să fie postate pe site-urile ambelor instituții guvernamentale? Mă refer la comunicatele de presă ce indică prezența unor boli la animale în diverse localități din țară, dar și despre bolile la animale confirmate ca fiind prezente în zonele/țările apropiate României. Poate că, după publicarea acestui editorial, ANSVSA (și instituțiile subordonate) va colabora, în acest sens, cu MADR (și instituțiile subordonate). Poate!
EDITORIAL
EDITORIAL
ATENȚIE LA BIOSECURITATEA DIN FERME ȘI DIN EXPLOATAȚIILE NONPROFESIONALE - NOI FOCARE DE PESTĂ PORCINĂ AFRICANĂ!
Attention to biosecurity in farms and non-professional farmsnew outbreaks of African swine fever!
D.M. Chiriac
STUDY IMAGISTICA APARATULUI URINAR LA CÂINE ȘI PISICĂ – PARTEA III
Diagnostic imaging of the urinary system of dog and cats – Part III V. Vulpe

SENSIBILITATEA STENOTROPHOMONAS MALTOPHILIA ȘI PSEUDOMONAS AERUGINOSA LA DIFERITE ANTIBIOTICE ȘI COMBINAȚII DE ANTIBIOTICE
Susceptibility of Stenotrophomonas maltophilia and Pseudomonas aeruginosa to different antibiotics and combinations of antibiotics

Bianca-Maria Marcoci, S. Răpuntean
REVIEW
SUSCEPTIBILITATEA SPECIILOR DE ANIMALE DOMESTICE ȘI SĂLBATICE LA INFECȚIA CU SARS COV-2, ÎN CONDIȚII NATURALE (STUDIU BIBLIOGRAFIC)
Susceptibility of domestic and wild animal species to SARS CoV-2 naturally infection (review)
S. Răpuntean, Ghe. Răpuntean
COMPARAȚIE ÎNTRE REACȚIA SISTEMICĂ POST AGRESIVĂ ȘI SINDROMUL
GENERAL DE ADAPTARE
Comparison between the post aggressive systemic reaction and the general adaptation syndrome R.N. Mălăncuș
VET HISTORY - PERSONALITIES
PERSONALITĂȚI ALE PROFESIEI, ÎN DOSARELE SECURITĂȚII
Personalities, in Security's files
SECURITATEA ROMÂNĂ - Organul represiv prin care partidul comunist a impus dictatura în România [Partea a treia] C.V. Iosif
SUMAR 277 316 294 282 334 330
REDACTOR-ȘEF
Dragoș Marius CHIRIAC
SENIOR EDITORI
Prof. Univ. Dr. Viorel ANDRONIE Prof. Univ. Dr. Olimpia I ACOB Prof. Univ. Dr. Cornel IGNA Prof. Univ. Dr. Gheorghe RĂPUNTEAN Prof. Univ. Habil. Dr. Violeta-Elena SIMION Prof. Univ. Dr. Carmen SOLCAN Prof. Univ. Dr. Dr.H.C. Gheorghe SOLCAN Prof. Univ. Dr. Nicolae STARCIUC (REPUBLICA MOLDOVA)

Prof. Univ. Dr. Alexandru ȘONEA
Prof. Univ. Dr. Vasile VULPE Conf. Univ. Dr. Alexandru DIACONESCU Conf. Univ. Dr. Narcisa Geanina MEDERLE Conf. Univ. Dr. Aurelian PAȘCA Conf. Univ. Dr. Sorin RĂPUNTEAN Șef Lucr. Dr. Dan CRÎNGANU Șef Lucr. Dr. Daniel Constantin LESCAI Șef Lucr. Dr. Ciprian OBER
Anul VII/ Vol. 7 / Nr. 37 (5) 2022 www.rjvmf.innovationinhealth.ro
Romanian Journal of Veterinary Medicine & Pharmacology


Prof. Univ. Dr. Leonard Ionuț ATANASE Prof. Univ. Dr. Dănuț COSTIN Prof. Univ. Dr. Adrian GAL Prof. Univ. Dr. Dănuț TURCU Prof. Univ. Dr. Liviu OANA Prof. Univ. Dr. Ing. Dr.H.C. Marcel POPA Conf. Univ. Dr. Adriana AMFIM Conf. Univ. Dr. Luminița Diana HRIȚCU Conf. Univ. Dr. Geta PAVEL Conf. Univ. Dr. Monica PÂRVU Conf. Univ. Dr. Carmen Daniela P ETCU Conf. Univ. Dr. Robert PURDOIU Conf. Univ. Dr. Alexandru VIȚĂLARU Șef Lucr. Dr. Alina ANTON Șef Lucr. Dr. Diana BREZOVAN Șef Lucr. Dr. Victor CĂLIN Ș ef Lucr. Dr. Fiz.-Chim. Dr. Ec. Ioana Andreea MARINESCU Șef Lucr. Dr. Răzvan Nicolae MĂLĂNCUȘ Ș ef Lucr. Dr. Andreea MORARU Şef Lucr. Dr. Cristina Angela PREDA Șef Lucr. Dr. Eusebiu Viorel ȘINDILAR Lector univ. dr. Luiza BĂDIC Lect Univ. Dr. Ruxandra COSTEA Lect. Univ. Dr. Ing. Cicerone Nicolaie MARINESCU Lect. Univ. Dr. Arpad SALLAY Lect. Univ. Dr. Marian SOARE Lect. Univ. Dr. Teodoru SOARE Asist Univ. Dr. Florentina DARABAN-BOCĂNEȚI Asist. Univ. Dr. Mariana GRECU Asist. univ. dr. Iulian MIHĂILĂ A sist. Univ. Drd. Raluca MUNTEANU Asist. Univ. Dr. Jelena SAVICI A ssoc. Prof. PhD Faycal ZEROUAL D r. Alina Ioana ARDELEAN D r. Zoltan BACÎRCEA Dr. Gabriela BAIDAN (MIHĂILĂ) D r. Bogdan BĂLĂȘCĂU Dr. Cristina BÎJNEA Dr. Dragoș Lucian BÎRȚOIU
Dr. Manuela-Ramona BLĂNARU (OZTURK)
Dr. Miruna BUIUC
D r. Diana Alexandra-BUSUIOC
D r. Ruxandra Otilia CRISTEA
D r. Anca CRISTEA
Dr. Anda DIMA
D r. Alexandra DREANCĂ
Dr. Mădălina Florina DRAGOMIR D r. Elena GAVRILAȘ Dr. Andreea GAVRILUŢĂ (GOARŢĂ)
Dr. Dan Eugen GÎSCĂ
Dr. Gabriela GEORGESCU Dr. Ioana Mădălina GEORGESCU Dr. Mădălina Elena HENEA
Dr. Cristian Valentin IOSIF Dr. Irina Mihaela IORDĂCHESCU

Dr. Raluca Eugenia IORGA Dr. Adrian IURCENCO Dr Timea Andrea KOCIS Dr. Florin LECA D r. Klara MAGYARI D r. Bianca-Maria MARCOCI D r. Anisia-Alexandra MIHAI (NICA)
DVM, CVA, CVFT, CVCH, CVTP Lorena Lloret NADAL Dr. Raluca NEGREANU Dr. Anca RUSU Dr. Adriana STANCU Dr. Iordana STOICA Dr. Anamaria-Hortensia STRICHEA D r. A lina ȘTEFĂNESCU D r. Mădălina (BRĂTEANU) TELIBAN
Dr. Ana TUDOSE Dr. Andrei TUDOSE
Dr. Mihai Alexandru TURCITU Dr. Iosif VASIU Dr. Ovidiu Valentin ZVORIȘTEANU Biolog Mariana VASIU
PhD Laura-Mădălina LIXANDRU
Student Julie Marie Christine MOREAU
Copyright © 2022
Innovation in Health Center. Drepturile de autor pentru articolele și fotografiile publicate aparţin exclusiv Innovation in Health Center. Reproducerea, totală sau parţială, și sub orice formă, tipărită sau electronică, sau distribuţia materialelor publicate se face numai cu acordul scris al IHC.

ISSN: 2537 – 4095 ISSN-L: 2537 – 4095 ISSN (online): 2558 - 9318
Responsabilitatea asupra conţinutului original al materialelor aparţine în întregime autorilor. Persoanele intervievate răspund de conţinutul declaraţiilor lor, iar utilizatorii spaţiului publicitar, de informaţiile incluse în machete.

BDI INDEXED: ABONAMENTE ȘI PUBLICITATE INNOVATION IN HEALTH CENTER E-mail: redactia.ihc@gmail.com Web: www.innovationinhealth.ro COMITET EDITORIAL
Cite this article: V. Vulpe. Diagnostic imaging of the urinary system of dog and cats –Part III.
Rom J Vet Med Pharm. 2022; Vol. VII 37(5): 282-292.
IMAGISTICA APARATULUI URINAR LA CÂINE ȘI PISICĂ – PARTEA III
DIAGNOSTIC IMAGING OF THE URINARY SYSTEM OF DOG AND CATS – PART III
OPEN
Recieved: July 2022
Accepted: July 2022
REZUMAT
ACCES JOURNAL
Corresponding author: Vasile Vulpe, E-mail: vvulpe@uaiasi.ro
Aparatul urinar este verificat funcțional, dar mai ales fizic, prin examene imagistice clasice, ca cele radiologice, ecografice, sau prin examene imagistice avansate, ca cele computertomografice sau prin rezonanță magnetică. Imagistica rinichilor, a ureterelor, a vezicii urinare și a uretrei este necesară de realizat atunci când sunt suspiciuni că există diverse anomalii de formă, de volum, ale infecțiilor urinare sau alte procese inflamatorii, ale unor traumatisme sau a existenței unor fenomene de litiază, ale unor tumori. Există două mari categorii în care medicul trebuie să intervină, inclusiv prin examene imagistice: traume majore ale aparatului urinar, însoțite de hemoragii și de stări de șoc sau infecții/inflamații, acute sau cronice, ce trebuie diagnosticate fidel; în ambele situații examenul imagistic este obligatoriu de efectuat.
CUVINTE-CHEIE:
ABSTRACT
radiografie, ecografie, modificări
The urinary tract is verified functionally, but especially physically, by classical imaging examinations such as radiological, ultrasound or by advanced imaging examinations such as computed tomography or magnetic resonance imaging. Diagnostic imaging of the kidneys of the ureters, bladder and urethra is necessary when there are suspicions of various abnormalities in shape, volume, urinary tract infections or other inflammatory processes, trauma or the existence of lithiasis, tumors. There are two main categories in which the doctor must intervene, including imaging examinations: major urinary tract trauma accompanied by bleeding and shock or acute or chronic infections / inflammations that must be diagnosed accurately; in both cases the imaging examination is mandatory.
KEYWORDS:
radiography, ultrasound, modifications
EXAMENUL IMAGISTIC AL VEZICII
URINARE
Vezica urinară este un organ ovoid situat în regiunea caudală a abdomenului, parțial în bazin (la pisică este plasată în abdomen); forma, volumul și poziția ei se schimbă în raport cu pro -
cesul de acumulare și eliminare a urinii. Dorsal, se învecinează cu rectul și colonul descendent, anterior cu intestinul subțire, ventral (când este plină) cu peretele abdominal. Este menținută în poziție de două ligamente laterale și unul ventral. Trigonul vezical este regiunea situată
Vol VII - Nr. 37 (5) 2022 282
Prof. univ. dr. Vasile Vulpe Universitatea pentru Științele Vieții “Ion Ionescu de la Brad” din Iași, Facultatea de Medicină Veterinară, Serviciul de Radiologie și Imagistică
STUDY
cats – Part III
Diagnostic
imaging of the urinary system of dog
and
mai sus de gâtul vezicii, îmbrăcată muscular, și unde se inseră cele două uretere.
Examenul imagistic constă în examen radiologic (eventual cu mediu de contrast) și examen ecografic.
Examenul radiologic al vezicii urinare se realizează în incidență latero-laterală și ventro-dorsală. În radiografia laterală, vezica urinară (când este semiplină) este vizibilă datorită grăsimii din jurul ei. Uneori, este acoperită datorită anselor intestinale dilatate. Detalii suplimentare apar la cistografie (radiografia de contrast) care se poate realiza prin urografie intravenoasă - descendentă (rar aplicată pentru examenul vezicii) sau urografie ascendentă. Cistografia presupune realizarea sondajului și poate fi sub formă de cistografie pozitivă (soluție de contrast – fig. 1), cistografie cu dublu contrast (aer și soluție de contrast), pneumocistografie (aer) – fig. 2.



Figura 1. Câine, adult, radiografie abdomen LL; zona ovală de radiotrasparență urmărește forma vezicii urinare – pneumocistografie
completată prin palpație percutorie (balotare, realizată cu prudență), pentru a observa dacă o anumită modificare este ancorată de perete sau este detașabilă.
Figura 1. Pisică, adultă, M; radiografie abdomen, LL, stânga;, săgeata arată vezica plină cu soluție de contrast - cistografie (foto L. Corlat)
Ecografia vezicii urinare se realizează pe pacientul situat în decubit dorsal și, mai rar, în poziție patrupodală. Se folosesc sonde de 5 – 7,5 MHz (chiar și până la 10 MHz), preferându-se a se realiza examinarea asupra unei vezici semidestinse – se poate realiza instilarea de ser fiziologic prin cateterism (fără a introduce aer, care va da artefacte) sau se poate accentua diureza, medicamentos. Vezica urinară destinsă, respectiv peretele prea întins, comportă greutăți în vizualizarea clară a celor trei straturi ecografice ale peretelui (mucoasa ușor hiperecogenă, submucoasa hipoecogenă și seroasa hiperecogenă). Uneori, examinarea ecografică a vezicii poate fi
Figura 3. Imagine ecografică normală a vezicii urinare
Vezica se examinează mișcând sonda în plan sagital sau transversal, de la polul cranial spre zona caudală a organului. Conținutul lichid al vezicii conferă caracter anecogen, iar peretele acesteia hiperecogen și cu aspect neted. Grosimea peretelui variază în funcție de gradul de distensie (1 – 2 mm); zona trigonului și a gâtului vezicii dă un aspect ecogen mai intens; aici se mai observă o zonă hiperecogenă – papila

283 Vol VII - Nr. 37 (5) 2022 Romanian Journal of Veterinary Medicine & Pharmacology V. Vulpe
Figura 5.1.
ureterală. Aceasta reprezintă locul de intrare al ureterelor unde, ecografic, se observă jeturi ale urinii ce pătrund în vezică; se pot utiliza diuretice pentru evaluarea atentă a jeturilor și pentru diagnosticul diferențial privind ureterul ectopic. Examinatorul trebuie să aprecieze posibila apariție a artefactelor de reverberație conferite de colon (materii fecale, aer) și pliuri ale pielii care pot simula sediment sau mase în lumenul vezical. Pentru a evita aceste artefacte, se apelează și la examinarea în poziție patrupodală.

MODIFICĂRI IMAGISTICE
În cistita acută, semnele radiologice sunt reduse. Totuși, se poate observa creșterea în volum, uneori intensă, a vezicii (fig. 4). În cistita cronică, se poate observa creșterea radioopacității peretelui; zone de radioopacitate localizată mai pot fi produse ș i de mineralizări ale peretelui vezicii urinare asociate cu neoplaziile sau cistita cronică. Unele neregularități ale mucoasei, ulcerele și polipii, pot fi evidențiați mai bine prin pneumocistografie sau prin cistografie cu dublu contrast. Cu ajutorul acestor tehnici, se pot observa defecte de umplere ale vezicii urinare ce pot fi datorate proceselor inflamatorii, prezenţei calculilor, a cheagurilor de sânge, a bulelor de aer, a calculilor, proceselor tumorale ș i a polipilor. Procesele tumorale sunt cel mai des observate în zona gâtului vezicii urinare. Refluxul (cu retenţia de urină sau nu) apare în cazul refluxului vezico-ureteral, a anomaliilor uracale sau în cazul existenţei unui diverticul vezical post-traumatic. Anomaliile uracale includ prezenţa unui diverticul congenital sau dobândit, sau a chiștilor, dar și persistenţa deschiderii canalului uracal sau a ligamentului vezico-ombilical. Anomaliile uracale pot fi identificate prin examinarea cu substanţă de contrast sub aspectul unei extensii a vezicii urinare evidenţiată de mediul de contrast, cu margini netede. Modificările de poziţie ale vezicii urinare sunt des întâlnite, iar în acest caz este necesară și examinarea organelor adiacente locaţiei sale normale. Hernia vezicii urinare poate fi perineală, inghinală sau abdominală. Cistografia pozitivă

5.2.

Vol VII - Nr. 37 (5) 2022 284
Figura 4. Pisică, adultă; radiografie abdomen, LL. Radioopacitate intraabdominală oval-rotundă, bine circumscrisă - glob vezical
Câine, metis, 9 ani; radiografie abdomen caudal, LL, decubit lateral stânga. Imposibilitatea identificării siluetei vezicii urinare la nivel abdominal, prolaps rectal cu angajarea vezicii. Îngustare spaţiu intervertebral și reducere intensă la orificiul supravertebral L7-S1
Figura
Același pacient, uretrocistografie; soluția de contrast dezvăluie hernierea vezicii urinare
STUDY
– Part III
Diagnostic imaging of the urinary system of dog and
cats







285 Vol VII - Nr. 37 (5) 2022 Romanian Journal of Veterinary Medicine & Pharmacology
Figura 6. Câine, Bichon, 5 ani, M; cistografie ascendentă. Vezică urinară torsionată postoperator; soluția de contrast desenează uretra și se acumulează predominant în prima parte a vezicii
Figura 9. Cistografie, LL stânga; soluția de contrast se dispune neregulat în vezică – suspiciune carcinom vezical; se indică ecografie, endoscopie
Figura 10. Radiografie LL dreapta a vezicii urinare – calcul unic de mari dimensiuni (săgeata)
Figura 11. Radiografie abdomen, LL dreapta; calculi multipli în vezica urinară (săgeata albă), calcul renal (săgeata neagră)
Figura 7. Câine, Pekinez, 14 ani; M; radiografie abdomen, LL, decubit lateral stânga. Multiple bule de gaz în vezica urinară, prostata mărită, siluetă hepatică mărită
V.
Figura 8. Cistita emfizematoasă – imagine ecografică; se observă margine hipercogenă la suprafața mucoasei și conținut hiperecogen (aer) cu artefacte diverse
Vulpe
ascendentă pune în evidență schimbarea de poziție a vezicii. Totuși, uneori soluția nu poate pătrunde în vezică dacă uretra are lumenul închis (intens compresată, torsionată). În acest caz, se apelează la ecografie, care va demonstra globul vezical anecogen (corpul vezicii) ce este localizat eratic.
Modificările de volum pot fi fiziologice (la câinii de apartament), dar reversibile și patologice în sindromul de retenție urinară sau în parezia/ paralizia vezicii.
Modificările de formă ale vezicii urinare sunt observate mai rar și pot fi cauzate de mase
intraabdominale adiacente peretelui vezical, neoplasme localizate la nivelul peretelui, persistenţa ligamentului uracil, atonia vezicală.



Modificările de radiodensitate la nivelul ariei de proiecţie a vezicii urinare pot fi identificate ușor pe imaginea radiografică. Prezenţa gazului în interiorul vezicii urinare – formaţiuni rotunde, bine delimitate, radiotransparente - poate fi observată în urma cateterizării sau cistocentezei. Prezenţa gazului în lumenul vezical, în perete, și, ocazional, la nivelul ligamentelor vezicii urinare poate fi observată în cazul cistitei emfizematoase (fig. 7); este produsă de bacteriile ce fermentează glucoza și poate să apară în asociere cu diabetul.
Zonele cu radioopacitate crescută, observabile la nivelul vezicii urinare, pot să indice tumori care afectează peretele vezicii în asociere cu dispunerea soluției de contrast, mai ales spre gâtul vezicii urinare (posibil carcinom tranzițional) (fig. 9); examenul direct poate indica prezenţa unor uroliţi (fig. 10, 11), iar pentru identificarea lor certă este necesară realizarea unor imagini radiologice în incidenţă latero-laterală ș i ventro-dorsală. Din punct de vedere radiologic, calculii pot fi radioopaci (formați din fosfați, oxalați, carbonați de calciu fosfați amoniaco-magnezieni) sau radiotransparenți (cistină, urați); aceștia din urmă necesită cistografie de contrast.
Figura 12. Câine, metis, 6 ani, M; ecografie a vezicii urinare. În lumenul vezicii se observă o formațiune hiperreflectivă, convexă (săgeata). ce induce un con de umbră acustică; diagnostic compatibil cu litiaza vezicii urinare; de la nivelul calculului, se observă o formațiune hiperecogenă (stea) ce se întinde către peretele ventral al vezicii urinare (câmpul apropiat al imaginii) compatibil cu o bridă de coagul sanguin
Examenul ecografic pune în evidență calculii de dimensiuni mari și moderate – hiperecogeni, alături de efectul de umbră (artefact) (fig. 12, 13).
În cistită, tehnica ecografică pune în evidență îngroșarea peretelui, mai ales în zona cranio-ventrală a vezicii, eventual cu un aspect neregulat al mucoasei (fig. 14, 15, 17).
Vol VII - Nr. 37 (5) 2022 286
Figura 14. Cățea, metis, 10 ani; ecografie vezica urinară – imagine transversală a vezicii urinare; se observă îngroșarea mucoasei asociată cu un halou hipoecogen (edemul stratului muscular)
– Part III
Figura 13. Câine, adult; ecografie a vezicii urinare – calculi numeroși de dimensiuni mici și medii
STUDY
Diagnostic imaging of the urinary system of dog and
cats
Sedimentul format din calculi de mici dimensiuni (microcalculi, microlitiaza) poate fi examinat prin ecografie însoțită de balotare (fig. 16), moment în care apare aspectul hipercogen intraluminal; va fi urmat imediat de căderea și așezarea microcalculilor pe o linie orizontală ventrală hipercogenă.


Fluoroscopia se aplică pentru situațiile intervenționale, pentru diagnostic, pentru localizarea unor modificări (și în vederea recoltării de probe, endoscopic), dar și pentru remediere chirurgicală (fig. 18).



HEMORAGIA INTRAVEZICALĂ
Cistitele pot fi însoțite de hemoragii; traumatismele și tumorile sunt și ele însoțite de coaguli sanguini ce pot fi radioteransparenți și cu defect de umplere la cistografie de contrast (atenție la confuzia dintre tumori și coagul!). Chiagurile
de sânge au ecogenitate heterogenă, în funcție de cantitatea sîngelui, detritus amestecat și vechimea procesului hemoragic. Coagulii de
287 Vol VII - Nr. 37 (5) 2022 Romanian Journal of Veterinary Medicine & Pharmacology
Figura 15. Cățea, Bichon, 6 ani; ecografie vezica urinară. Imagine longitudinală a vezicii, cu pierderea stratificării și cu aspect neuniform al peretelui. Cistită cronică.
Figura 16. Ecografie a vezicii urinare; microlitiază – momentul balotării
Figura 17. Cistită subacută, posibil fond de microlitiază (se indică ex. sedimentului urinar); celularitate abundentă și prezența de detritus celular, proteinurie și coaguli.
V.
Figura 18. Ureterocistografie retrogradă – diagnostic diferențial al ureterului ectopic intramural (cazul din imagine) de cel extramural, în vederea intervenței endoscopice de remediere cu laser; (foto CECMIV București)
Vulpe
Figura 19. Vezică urinară cu conținut cu aspect ecogen mixt, fără con de umbră acustică, rezultat în urma unui traumatism (hemoragie intravezicală)
dimensiuni mari și organizați (mai vechi) au aspect dantelat (fig. 19). Coagulii atașați de perete sunt hipoecogeni, față de tumori care sunt cu ecogenitate mai crescută. În momentul ecografiei, se poate folosi balotarea (cu prudență), caz în care chiagurile se desprind; desprinderea și chiar eliminarea lor se mai poate realiza sub sondaj și spălarea lumenului intravezical cu urmărire ecografică. Și această manoperă se realizează cu prudență.
RUPTURA VEZICII
Fenomenul poate apărea în urma traumatismelor, în obstrucția urinară sau în urma unei parturiții dificile; existența micțiunii nu exclude ruptura vezicii. Uretrocistografia cu contrast pozitiv este metoda cea mai indicată pentru a evidenţia o eventuală scurgere de urină din vezica urinară în cavitatea peritoneală, în ţesuturile adiacente. Într-o primă fază, soluția determină pierderea detaliilor seroaselor (reducerea netității), apoi se identifică ca atare. Nu se realizează pneumocistografie, pentru a se evita fenomenul de embolie.
Scurgerea substanţei de contrast la nivelul structurilor viscerale adiacente poate fi observată în cazul existenţei unei fistule congenitale sau dobândite, organele afectate, de regulă, fiind rectul sau vaginul; scurgerea substanţei de contrast la nivel peritoneal sau în ţesuturile adiacente tractului urinar apare radiologic ca un contur cu margini neregulate ș i poate fi observată, de regulă, simultan cu introducerea mediului de contrast la nivel vezical. În cazul fisurilor gâtului vezical de dimensiuni reduse, scurgerea substanţei poate fi lentă, evidenţiind
Figura 20. Motan, Europeană, 6 ani; ecografie abdomen. Vezica urinară în stare de golire; se observă în punctul cranial (săgeată) o zonă hiperecogenă, cu suspiciune de formare hematom în urma unei fisuri/rupturi a peretelui. Cranial vezicii urinare, se observă o zonă anecogenă (stea) ce corespunde lichidului liber în abdomen. La puncția abdominală, a fost extras lichid urinos și cu caracter sangvinolent
linii fine radioopace în afara vezicii urinare (fig. 20) - radiografiile trebuie repetate la 5 – 10 minute.


Ecografia pune în evidență prezența de lichid (urina) în cavitatea peritoneală. Este dificilă identificarea breșei în peretele vezicii, dar se poate realiza sondajul și introducerea de ser fiziologic în vezică, observându-se ecografic jetul de lichid ce trece dincolo de vezică, în abdomen.
EXAMENUL IMAGISTIC AL URETREI
Elemente de anatomie
Uretra este conductul care conduce urina de la vezică către exterior. Uretra la mascul este lungă și cuprinde trei porțiuni: uretra prostatică (fig. 21), uretra membranoasă și uretra peniană; uretra se curbează pe lângă ischium și ajunge în zona ventrală a penisului. La motan, este îndreptată direct caudal. Uretra la femelă este scurtă, orificiul uretral situându-se caudal de joncțiunea vestibulo-vaginală.
Imaginea normală
Radiografia directă nu vizualizează uretra. Ca tehnică, notăm că, la cîinele mascul, incidența latero-laterală se realizează în două radiografii, una cu membrele trase cranial și una cu membrele trase caudal; se permite, astfel, examinarea uretrei prostatice și, respectiv, a celei extrapelvine.
Uretrocistografia constă în introducere de soluție de contrast iodinată pe tot traiectul uretrei
Vol VII - Nr. 37 (5) 2022 288
STUDY
cats – Part III
Diagnostic imaging of the urinary system of dog and
până la vezica urinară. Poate fi folosită tehnica de fluoroscopie (radiologie intervențională) în cazul intervențiilor ca sondaj, dilatare uretră (fig. 22), stentare.




Ecografic, uretra este vizualizată la plecarea din vezică, iar, la mascul, în zona prostatei cu un caracter hipoecogen. Aici poate să apară un halou ecogen, conferit de țesutul fibros periu -
retral; uretra mai poate fi verificată ecografic în zona curburii ischiatice.
Modificări imagistice

Calculii uretrali pot fi vizualizaţi pe imaginea radiologică nativă doar în cazul în care au o compoziţie minerală (fosfați, oxalați, struviți). La masculi, aceștia pot fi localizaţi mai ales în zonele fiziologice de îngustare – la nivelul arcului ischiatic ș i anterior de intrarea în zona osului penian.
Uretrografia este metoda de elecţie utilizată pentru confirmarea prezenţei calculilor uretrali ce pot fi vizualizaţi în imaginea radiologică ca defecte de umplere, localizate sau multiple, care modifică lumenul uretrei. De regulă, forma lor este neregulată, iar marginile sunt neclare.
289 Vol VII - Nr. 37 (5) 2022 Romanian Journal of Veterinary Medicine & Pharmacology
Figura 22. Motan cu strictură uretrală; sub examenul fluoroscopic, se realizează introducerea de balon pneumatic pentru dilatarea uretrei (foto CECMIV București)
Figura 23. Câine, adult, M; ecografie uretra peniană. În imaginea sagitală de la nivelul osului penian, se observă o formațiune (stea) cu un perete hiperecogen și con de umbră acustică prezent, compatibil cu diagnosticul de calcul uretral
V. Vulpe
Figura 21. Câine, adult, M; uretrografie. Se observă prostatomegalie intensă; soluția de contrast pătrunde cu greu în uretra prostatică, fără să ajungă în vezica urinară; săgețile albe marchează marginea prostatei, săgețile negre marchează soluția de contrast, inclusiv de la nivelul uretrei peniene
Figura 24. Motan, Scottishfold, 2 ani. La nivelul uretrei intra-
tranziţionale sau carcinomul prostatic, fie sunt papiloame sau alte tumori (rare ca frecvență) locale uretrale. Uretrita granulomatoasă este o afecţiune inflamatorie infiltrativă ce afectează femelele. Pe imaginile radiografice, realizate în cursul uretrografiei, poate fi vizualizată marginea neregulată a peretelui uretral ș i numeroase defecte de umplere. Ecografia (transabdominală, dar și cea transrectală) aduce date pertinente




Bulele de aer introduse în uretră pe parcursul cateterizării pot fi u ș or diferenţiate de calculii uretrali, datorită formei rotunjite, cu margini netede, care nu modifică lumenul uretral ș i care dispar în urma unei noi administrări de substanţă de contrast.
Pe anumite trasee ale uretrei, calculii pot fi identificați ecografic – sunt hiperecogeni, de multe ori de formă oval rotundă sau alungiți (fig. 23, 24).
Neoplaziile sunt întâlnite destul de rar și fie sunt procese extinse de la nivelul vezicii urinare sau prostatei, cum ar fi carcinomul cu celule
Figura
Vol VII - Nr. 37 (5) 2022 290
pelvine, caudal de gâtul vezicii urinare, se observă o formațiune cu perete hiperecogen și con de umbră acustică prezentă, compatibil cu diagnosticul de litiază urinară
Figura 26. Câine, Pekinez, vârstă incertă; uretrografie, LL. Uretra torsionată, stenozată (săgeți); soluția de contrast se oprește la intrare în bazinul fracturat; prostatomegalie, glob vezical
27. Câine, adult, M; radiografie abdomen, LL, uretrografie: fractură de bazin (săgeți); soluția de contrast dilată uretra (cap săgeată), apoi urmează o zonă stenozată – o mică parte din soluție ajunge în vezică (stea)
STUDY
– Part III
Figura 25. Câine, adult, M; radiografie abdomen, uretrocistografie, LL; există leziune majoră a uretrei în regiunea bazinului, soluția de contrast difuzează în cavitatea abdominală
Diagnostic imaging of the urinary system of dog and
cats
asupra tumorilor gîtului vezicii urinare și care se poate extinde și la o porțiune din uretră.
Ruperea uretrei poate fi diagnosticată în urma traumatismelor zonei pelvine sau a penisului ș i poate fi evidențiată prin utilizarea soluțiilor de contrast, vizualizând semnele extravazării mediului de contrast la nivelul zonei lezionate. În funcţie de localizarea fisurii sau leziunii, substanţa de contrast poate ajunge în spaţiul peritoneal (fig. 25), în ţesutul cavernos al penisului sau în ţesuturile moi adiacente uretrei.
Stricturile uretrale pot să apară secundar unor traume sau obstrucţii la nivel uretral ș i pot fi observate ca o îngustare abruptă, localizată, a lumenului. Pentru a diferenţia strictura uretrală de distensia insuficientă sau de spasmul uretral, este necesară identificarea ei în mai multe imagini radiologice realizate în timpul introducerii substanţei de contrast, când pot fi observate ș i eventualele margini neregulate ș i
Bibliografie
1. Barr F., O’Brien, R., BSAVA Manual of Canine and Feline Abdominal Imaging, BSAVA, 2009.
2. Bertoni G., Brunetti A., Pozzi L., Meomartino L., Radiologia Veterinaria, Idelson-Gnocchi, 2005.
3. Brown J.C., The Urethra, în Thrall, D.E., Textbook of Veterinary Diagnostic Radiology. Sixth Edition, Elsevier Saunders, 2013, p.744748.
4. Burk, R.L., Feeney D.A., Small Animal Radiology and Ultrasonography, Saunders, 2003.
5. Corlat L.: Cercetări privind etiopatogenia, diagnosticul clinicoimagistic ş i de laborator al afecțiunilor însoțite de disurie, la câine, Facultatea de Medicină Veterinară Ia ş i, martie 2018.
6. Coulson A., Lewis N., An Atlas of Interpretative Radiographic Anatomy of the Dog and Cat, Blackwell Science, 2002.
7. Kealy, K.J., McAllister, H., Diagnostic Radiology & Ultrasonography of the Dog and Cat, Elsevier Saunders, 2005.
8. Marolf A.J., Park R.D., The Urinary Bladder, în Thrall, D.E., Textbook of Veterinary Diagnostic Radiology. Sixth Edition, Elsevier Saunders, 2013, p.726-743.
9. McConnell, J.F., Abdominal Radiography, în Barr F., O’Brien, R., BSAVA Manual of Canine and Feline Abdominal Imaging, BSAVA, 2009, p.5-17.
10. Meeson R., Corr S., 2011: Management of Pelvic Trauma: Neurological damage, urinary tract disruption and pelvic fractures. Journal of Feline Medicine & Surgery, vol. 13, iss.5, pag. 347 – 361.
11. Meomartino L., L’addome dei piccoli animali: tubo digerente,
dilatarea luminală proximal de leziune. Formaţiunile extraluminale cu originea în ţesuturile moi adiacente uretrei pot cauza compresiuni la nivelul lumenului sau chiar modificarea poziţiei topografice a uretrei.
Fistulele uretrale pot fi evidenţiate urmărind cursul substanţei de contrast ce iese din lumenul uretrei ș i ajunge la nivelul altui organ cavitar –rect sau vagin. La pacienţii tineri, aceste leziuni pot fi congenitale, dar ele pot fi identificate la orice vârstă, ca urmare a ruperii uretrei în urma unui traumatism sau manopere incorecte.
NOTĂ
CECMIV București = Centrul de Endoscopie și Chirurgie Minim Invazivă Veterinară București.
This work is licensed under a Creative Commons Attribution-NonCommercialNoDerivatives 4.0 International License.

pancreas, apparato urinario, surreni, în Bertoni G., Brunetti A., Pozzi L., Meomartino L., Radiologia Veterinaria, Idelson-Gnocchi, 2005, p.337-380.
12. Muhlbauer, M.C., Kneller, S.K., Radiography of the dog and cat: Guide to Making and Interpreting Radiographs, First edition, WileyBlackwell, 2013.
13. Owens, J.M., Biery, D.N., Radiographic Interpretation for the Small Animal Clinician, Ralston Purina Company, 1982.
14. Petite A., Busoni V., Heinen M.P., Billen F., Snaps F., 2005: Radiographic and ultrasonographic findings of emphysematous cystitis in four nondiabetic female dogs. https://doi.org/10.1111/ j.1740-8261.2005.00112.x, Veterinary Radiology & Ultrasound.
15. Seiler G.S., The Kidney and Ureters, în Thrall, D.E., Textbook of Veterinary Diagnostic Radiology. Sixth Edition, Elsevier Saunders, 2013, p.705-725.
16. Thrall, E.D., Robertson, D.I., Atlas of Normal Radiographic Anatomy and Anatomic Variants in the Dog and Cat, Elsevier, 2010.
17. Thrall, E.D., Textbook of Veterinary Diagnostic Radiology, Sixth Edition, Elsevier, 2013.
18. Tudor N., Georgescu G., Vlăgioiu C., 2009: Retrospective study on imagistic evaluation of urinary tract in dog. http://journals.usamvcluj. ro/index.php/veterinary/article/view/4163, vol 66, no. 2.

19. Vulpe V. ş i colab., 2014: Manual practic de radiologie veterinară –Ghid de radiografie la câine ş i pisică. Edit. “Performantica”, Ia ş i.
20. Wilfried M., Guide Pratique de Radiographie Canine et Feline, Paris, Med’Com, 2003.
291 Vol VII - Nr. 37 (5) 2022
Romanian Journal of Veterinary Medicine & Pharmacology
V. Vulpe
Prof univ. dr. Vasile VULPE
STUDII UNIVERSITARE Universitatea pentru Științele Vieții “Ion Ionescu de la Brad” din Iași, Facultatea de Medicină Veterinară, Serviciul de Radiologie și Imagistică, promoția 1989
ACTIVITĂȚI PROFESIONALE: 1989 – 1990, medic epizootolog, AEI Poiana, jud. Iași 1990 – 1993, medic ihtiopatolog, Stațiunea de Cercetări Piscicole Iași 1993 – în prezent, asistent universitar (1993), șef de lucrări (2001), conferențiar univ. (2005), profesor univ. (2008)
ALTE TITLURI OBȚINUTE: - doctor în științe, domeniul Medicină veterinară, 2002 - conducător de doctorat, domeniul Medicină veterinară, specializarea Semiologie și patologie medicală, 2009

REALIZĂRI PROFESIONALE: - 24 de cărți publicate, din care 14 unic autor - 245 lucrări științifice din care 145 indexate in baze de date internationale, 12 lucrări ISI publicate în reviste de specialitate (prim autor și coautor), 13 lucrări ISI publicate in rezumat. - 46 de manifestări științifice ale asociției ARDIV, organizate în mod direct
APARTENENȚA LA ASOCIAȚII PROFESIONALE:
-Președinte al Asociației Române de Diagnostic Imagistic Veterinar -Membru al Colegiului Medicilor Veterinari
-Membru al Asociației Generale a Medicilor Veterinari -Membru al European Fish Pathologist Association
-Membru al World Aquatic Veterinary Medicine Association -Membru al Asociaţiei Române de Patologia Animalelor Sălbatice -Membru al Asociației Absolvenților Facultății de Medicină Veterinară Iași
-Membru al Asociației ProMedVita -Membru al Societății de Neurologie, Neurochirurgie și Medicină Comportamentală
Vol VII - Nr. 37 (5) 2022 292 CV
STUDY
of dog and cats – Part III
Diagnostic imaging of the urinary system










293 Vol VII - Nr. 37 (5) 2022 Romanian Journal of Veterinary Medicine & Pharmacology Romanian Journal of Veterinary Orthopedics & Imagistic www.rjvoi.innovationinhealth.ro PUBLICAŢIE CREDITATĂ DE COLEGIUL MEDICILOR VETERINARI DIN ROMÂNIA SUB EGIDA 2 NUMERE PE AN, ÎN FORMAT DIGITAL ȘI ONLINE
Cite this article: Bianca-Maria Marcoci, S. Răpuntean. Susceptibility of Stenotrophomonas maltophilia and Pseudomonas aeruginosa to different antibiotics and combinations of antibiotics.
Rom J Vet Med Pharm. 2022; Vol. VII 37(5):294-314.
SENSIBILITATEA STENOTROPHOMONAS MALTOPHILIA ȘI PSEUDOMONAS AERUGINOSA LA DIFERITE ANTIBIOTICE ȘI COMBINAȚII DE ANTIBIOTICE
SUSCEPTIBILITY OF STENOTROPHOMONAS MALTOPHILIA AND PSEUDOMONAS AERUGINOSA TO DIFFERENT ANTIBIOTICS AND COMBINATIONS OF ANTIBIOTICS
OPEN ACCES JOURNAL
Corresponding author: Sorin Răpuntean, E-mail sorin.rapuntean@gmail.com
Recieved: November 2022
Accepted: November 2022
REZUMAT
Acest studiu are ca obiectiv analizarea reacției pe care o au două tulpini puternic antibiorezistente atunci când intră în contact cu o serie diversă și diferită de antibiotice atât unice, cât și în diferite combinații. Cele două tulpini folosite sunt reprezentate de Pseudomonas aeruginosa (P. aeruginosa) și Stenotrophomonas maltophilia (S. maltophilia). În cadrul studiului prezent, a fost utilizat un total de 56 de antibiotice, în trei serii diferite, a câte 10 plăci per serie. Astfel, prin măsurarea zonelor de inhibiție din jurul fiecărui microcomprimat, a fost determinat nivelul efectului inhibitor al antibioticelor utilizate. S-a constatat că P. aeruginosa și S. maltophilia au un nivel înalt de sensibilitate față de antibioticele individuale, acestea prezentând o zonă de inhibiție care depășește 17 mm. În schimb, în cazul asocierilor de antibiotice, eficacitatea variază pentru ambele tulpini bacteriene, respectiv S. maltophilia prezintă zone de inhibiție care se încadrează între 8 și 35 mm, iar în cazul P. aeruginosa, zona variază între 8 și 26 mm.
CUVINTE-CHEIE:
antibiorezistența, Pseudomonas aeruginosa, Stenotrophomonas maltophilia
294 STUDY
Vol VII - Nr. 37 (5) 2022
Dr. Bianca-Maria Marcoci*, Conf. univ. dr. Sorin Răpuntean** * SC Terra Vet, Bacău; ** Universitatea de Științe Agricole și Medicină Veterinară din Cluj-Napoca, Str. Mănăștur nr. 3-5, 400372, Cluj-Napoca, România
Susceptibility of Stenotrophomonas maltophilia and Pseudomonas aeruginosa to different antibiotics and combinations of antibiotics
ABSTRACT
The main purpose of this study is to analyze the reaction of two highly antibiotic-resistant strains when they come into contact with a diverse and different series of antibiotics, both single and in different combinations. The two strains used are represented by Pseudomonas aeruginosa (P. aeruginosa) and Stenotrophomonas maltophilia (S. maltophilia). In the present study, 56 antibiotics were used, in three different series, of 10 Petri plates each. Thus, the zone of inhibition around each microtablet determines the level of inhibitory effect of the antibiotics used. It is noteworthy that P. aeruginosa and S. maltophilia have a high level of sensitivity to individual antibiotics, showing an inhibition zone that exceeds 17 mm. In contrast, in the case of antibiotic combinations, the efficacy varies for both bacterial strains, as S. maltophilia shows zones of inhibition that fall between 8 and 35 mm, and in the case of P. aeruginosa, the zone varies between 8 and 26 mm.
KEYWORDS: antibiotic resistance, Pseudomonas aeruginosa, Stenotrophomonas maltophilia

INTRODUCERE ȘI SCOPUL LUCRĂRII
Combinațiile de antibiotice reprezintă cea mai eficientă abordare, la momentul actual, în tratarea infecțiilor bacteriene, în detrimentul folosirii antibioticelor unice. Antibiorezistența reprezintă o problemă care ia o amploare tot mai mare, pe zi ce trece. Astfel, rezistența anti-microbiană atinge peste 700.000 de victime anual, cu posibilitate de extindere la milioane, într-un interval foarte scurt de timp. Bacteriile dezvoltă antibiorezistență mai rapid decât este capabilă industria farmaceutică să producă și dezvolte noi produse farmaceutice, cu efect antibiotic.
Antibiorezistența reprezintă capacitatea naturală sau dobândită a unui microorganism de a rezista efectelor unuia sau mai multor antibiotice. Astfel, o singură bacterie deține capacitatea de a deveni rezistentă la peste douăzeci de antibiotice diferite, într-un timp foarte scurt. P. aeruginosa se găsește frecvent în mediul înconjurător (sol sau apă). Specia care cauzează cel mai adesea infecții la animale și om este P. aeruginosa (bacilul piocianic). Astfel, în cadrul acestei lucrări, am urmărit stadiul de adaptare și rezistență pe care cele două tulpini l-au atins, la momentul actual, raportat la expunerea foarte mare la diferite tipuri și clase de antibiotice.
1.1. PSEUDOMONAS AERUGINOSA
1.1.1 Istoric și precizări taxonomice
Familia Pseudomonadaceae , aflată într-o continuă dezvoltare, grupează, la momentul actual, peste 500 de specii descrise. P. aeruginosa sau “bacilul pioceanic” este o sintagmă care își are originea în limba latină ( verdigris = rugină de cupru) ce face referire la specificitatea cromatică
a culturilor, albastru-verde. Acest pigment este o combinație dintre doi metaboliți: piocianina (albastru) și pioverdina (verde) (1)
1.1.2 Ecologie P. aeruginosa este o bacterie oportunistă (evoluție galopantă la pacienți imunocompromiși sau pe fondul altor afecțiuni preexistente, în special arsuri extinse sau fibroză chistică). Tratamentul infecțiilor este dificil de susținut din cauza rezistenței naturale la antibiotice (un tratament cu diferite combinații și asocieri de antibiotice putând determina alte efecte adverse), cât și din cauza substratului imunocompromis al pacientului (2)
1.1.3. Morfologie, caractere culturale și proprietăți biochimice
Este un bacil Gram negativ, drept sau ușor încurbat, nesporulat, necapsulat, anaerob și prezintă, la unul dintre poli, un cil care îi conferă mobilitate. Mediile pe care se dezvoltă P. aeruginosa sunt diverse, fiind un germen nepretențios. Pot fi utilizate atât medii lichide, cât și solide. Bulionul nutritiv prezintă turbiditate accentuată, formându-se o peliculă și un pigment verde, specific. Frecvent, se poate observa un inel alb, mucos, aderent de pereții eprubetei. Pe mediu solid, cultura are o suprafață iridescentă, fiind evidențiat un luciu metalic și plaje de autoliză (3)
1.1.4. Patogeneza și infecția naturală
P. aeruginosa codifică factori variați de virulență, care îi permit să inducă diferite infecții animale și umane. Tulpinile de P. aeruginosa (Fig. 1 a, b) produc două tipuri distincte de antigene: O (O-Ag), un antigen polizaharid co -
295 Vol VII - Nr. 37 (5) 2022 Romanian Journal of Veterinary Medicine & Pharmacology
Bianca-Maria Marcoci, S. Răpuntean
mun (bandă A) și un antigen O-specific (bandă B). Lipopolizaharidele (LPS) de P. aeruginosa sunt mai puțin toxice decât cele specifice altor bacili Gram-negativi facilitând, astfel, cronicizarea infecțiilor, prin declanșarea unui răspuns inflamator sistemic scăzut (4) Instalarea procesului infecțios presupune mai multe stadii diferențiate: colonizarea, invazia, diseminarea și difuzia toxinelor în organismul infectat. Colonizarea se realizează cu ajutorul adezinelor și al fimbriilor, acestea reprezentând punți prin intermediul cărora bacilul se leagă de celulele epiteliale ale tegumentului și mucoaselor. Invazia este asigurată de acțiunea: proteazei, elastazei și a exotoxinei A, care au rolul de a altera țesutul, distrugând complementul, fibronectina si imunoglobulinele. În faza de diseminare, endotoxina si exotoxina A determină, în cele din urmă, șocul septic (4)
1.3 STENOTROPOHOMONAS MALTOPHILIA
1.3.1. Istoric și precizări taxonomice
S. maltophilia (Fig. 2 a, b), o specie relativ nouă, care este parte constituentă a familiei Xanthomonadaceae , familie care grupează peste 25 de genuri. Denumirea genului provine din cuvinte grecești ( stenos = îngust; trophe = hrană și monas = o unitate). Ulterior, au fost identificate și alte specii: S. acidaminiphila, S. nitrireducens, S. africana, S. rhizophila etc. (5)
1.3.2.
Ecologie
S. maltophilia este un germen comensal, omniprezent în mediu, în special în cele apoase și sol. La pacienții imunocompromi ș i, poate
bgenera infecţii nosocomiale. Este un patogen emergent, asociat cu infecții oportuniste la pacienții imunosupresați (HIV, fibroză chistică și cancer). Recent, s-a observat aderarea acestui microorganism la suprafețele abiotice, precum dezinfectante întâlnite atât în spitale veterinare, cât și umane, catetere, sisteme de ventilație etc. Poate contamina produse alimentare refrigerate, leguminoase, liniile de procesare a laptelui etc. S. maltophilia a fost izolat, alături de alți germeni, chiar și după proceduri de igienizare (5)
1.3.3. Morfologie, caractere culturale și proprietăți biochimice
S. maltophilia este o bacterie Gram negativă, uniformă morfologic, care apare sub forma unui bacil scurt, subțire, drept sau curbat, cu dispunere izolată sau în perechi, non-fermentativ. Prezintă mobilitate datorită a doi sau mai mulți flageli polari. Cultivarea se face în condiții aerobe. Temperatura optimă de creștere este de 35°C. Coloniile sunt netede, cu contur regulat și de culoare albă-cenușie sau galben pal. Culoarea se poate intensifica la o temperatură mai ridicată de 42°C. Are o capacitate nutrițională restrânsă (5)
1.3.4. Patogeneză și infecția naturală
Infecția este facilitată de prezența unui substrat protetic (plastic sau metal). S. maltophilia secretă vezicule membranare exterioare (OMV) care induc un răspuns inflamator sistemic. OMV-urile de la S. maltophilia , ATCC 13637, s-au dovedit a fi citotoxice pentru celulele epiteliale pulmonare animale stimulînd expresia citokinelor pro-inflamatorii și a chemokinelor, inclusiv interleukina


Vol VII - Nr. 37 (5) 2022 296 STUDY
aFigura 1 (a, b). Colonii de P. aeruginosa pe mediu Mueller-Hinton (foto original)
Susceptibility of Stenotrophomonas maltophilia and Pseudomonas aeruginosa to different antibiotics and combinations of antibiotics
(IL)-1 β , IL-6, IL-8, factorul de necroză tumorală- α și proteina chemoatractantă a monocitelor (6)
1.4. MATERIALE NECESARE
Cercetările au fost realizate în laboratorul de microbiologie de la Facultatea de Medicină Veterinară din Cluj-Napoca în perioada noiembrie 2021 - iunie 2022.

Materiale necesare: bec de gaz, pipete Pasteur, plăci Petri, șablon, microcomprimate standardizate cu diferite antibiotice (56), pensetă curbată, eprubete, șubler, riglă, incubator, anse de diferite dimensiuni.
Substanțe: ser fiziologic (clorură de sodiu 0.9%), Muller-Hinton Agar, microcomprima -




te cu antibiotice, bulioane nutritive, tulpini specifice.
Cele 56 de antibiotice au fost alese atât randomizat, cât și conform sugestiilor studiilor de specialitate.
Tulpina S. maltophilia a fost izolată din apă florală utilizată în industria cosmetică, iar tulpina de P. aeruginosa din cavitatea bucală a unui șarpe (cobra imperială) cu bronșită recurentă.
2.3 REZULTATE
Plăcile din toate seriile au fost incubate timp de 24 de ore, la 37 °C, după care s-a efectuat citirea (măsurarea) și interpretarea rezultatelor.
297 Vol VII - Nr. 37 (5) 2022 Romanian Journal of Veterinary Medicine & Pharmacology
Figura 2 (a, b). S. maltophilia pe mediul Mueller-Hinton și detaliu (foto original)
a
Figura 3 (a, b). S. maltophilia, placa 1, seria 1, antibiotice individuale (foto originale)
a
b b
Bianca-Maria Marcoci, S. Răpuntean
Susceptibility of Stenotrophomonas maltophilia and Pseudomonas aeruginosa to different antibiotics and combinations of antibiotics
2.3.1. SERIA 1
Pentru placa 1 cu S. maltophilia (Fig. 3), din cadrul primei serii, s-au dovedit active următoarele antibiotice, în ordinea descrescătoare a eficacității: Marbofloxacina, Kanamicina, Ofloxacina, Lincocin forte, Rifampicina și Neomicina. Pentru Spiramicină și Penicilină s-a constatat fenomenul de antibiorezistență.
Tabelul 1. Zonele de inhibiție a plăcii 1, seria 1, S. maltophilia
Tabelul 2. Zonele de inhibiție a plăcii 1, seria 1, P. aeruginosa
Nr. crt. Antibiotic Zonă de inhibiție
Neomicină 8 mm

Marbofloxacină R
Lincocin forte 15 mm
Spiramicină R
Rifampicină R
Penicilină R
Ofloxacină R

Kanamicină 18 mm Nr. crt. Antibiotic Zonă de inhibiție 1 Neomicină 10 mm 2 Marbofloxacină 21 mm 3 Lincocin forte 18 mm 4 Spiramicină R 5 Rifampicină 15 mm 6 Penicilină R 7 Ofloxacină 18 mm 8 Kanamicină 20 mm
toarele antibiotice, în ordinea descrescătoare a eficacității: Minocyclina, Tobramicina și Netilmicina, Lincocin, Pefloxacina, Streptomicina și Metropenem. Pentru Rifampicină s-a constatat fenomenul de antibiorezistență.
Tabelul 3. Zonele de inhibiție a plăcii 2, seria 2, S. maltophilia
Pentru placa 1 cu P. aeruginosa (Fig. 4), din cadrul primei serii, s-au dovedit active următoarele antibiotice, în ordinea descrescătoare a eficacității: Kanamicină, Lincocin forte, Marbofloxacină și Neomicină. Pentru Spiramicină, Rifampicină, Ofloxacină și Penicilină s-a constatat fenomenul de antibiorezistență.
Pentru placa 2 cu S. maltophilia (Fig. 5), din cadrul primei serii, s-au dovedit active urmă -
Nr. crt Antibiotic Zonă de inhibiție 1 Tobramicină 22 mm 2 Streptomicină 14 mm 3 Rifampicină R 4 Pefloxacină 17 mm 5 Netilmicină 22 mm 6 Minocyclină 23 mm 7 Lincocin 18 mm 8 Meropenem 8 mm
Figura 4 (a, b). P. aeruginosa, placa 1, seria 1, antibiotice individuale (foto original)
Vol VII - Nr. 37 (5) 2022 298 STUDY
1
2
3
4
5
6
7
8
a
b
Figura


Pentru placa 2 cu P. aeruginosa (Fig. 6), din cadrul primei serii, s-au dovedit active următoarele antibiotice, în ordinea descrescătoare a eficacității: Tobramicină și Lincocină (aceeași zonă de inhibiție), Streptomicină, Netilmicină, Meropenem. Pentru Rifampicină, Pefloxacină și Minocyclină s-a constatat fenomenul de antibiorezistență.


Pentru placa 3, cu S. maltophilia (Fig. 7), din cadrul primei serii, a funcționat numai Tetraciclina. Pentru Ticarcilină cu acid clavulanic, Piperaciclină, Novobiocină, Linezolid, Meticilină, Pristinamicină și Metronidazol s-a constatat fenomenul de antibiorezistență.

299 Vol VII - Nr. 37 (5) 2022 Romanian Journal of Veterinary Medicine & Pharmacology
Tabelul 4. Zonele de inhibiție a plăcii 2, seria 2, P. aeruginosa
5 (a, b). S. maltophilia, placa 2, seria 1, antibiotice individuale (foto original)
antibioticele
a a b b Nr. crt Antibiotic Zonă de inhibiție 1 Tobramicină 14 mm 2 Streptomicină 13 mm 3 Rifampicină R 4 Pefloxacin R 5 Netilmicin 9 mm 6 Minocyclin R 7 Lincocin 14 mm 8 Meropenem 8 mm
Figura 6 (a, b). P. aeruginosa, placa 2, seria 1, cu
individuale (foto original)
Bianca-Maria Marcoci, S. Răpuntean
Pentru placa 3 cu P. aeruginosa (Fig. 8), din cadrul primei serii, s-au dovedit active următoarele antibiotice, în ordinea descrescătoare a eficacității: Piperacilină și Ticarcilină cu acid clavulanic. Pentru Tetraciclină, Novobiocină, Linezolid, Meticilină, Pristinamicină și Metronidazol s-a constatat fenomenul de antibiorezistență.

Pentru placa 4 cu S. maltophilia (Fig. 9), din cadrul primei serii, au funcționat următoarele antibiotice, în ordine descrescătoare a eficacității: Florfenicol, Amikacină, Kanamicină, Doxiciclină. Pentru Bacitracină, Clindamicină, Cefquinome și Eritromicină s-a constatat fenomenul de antibiorezistență.


Vol VII - Nr. 37 (5) 2022 300 STUDY
Figura 8. P. aeruginosa, placa 3, seria
antibiotice individuale
a b Tabelul 5. Zonele
inhibiție a plăcii 3, seria
Tabelul 6. Zonele de inhibiție a plăcii 3, seria
Nr. crt. Antibiotic Zonă de inhibiție 1 Tetraciclină 16 mm 2 Ticarcilin + acid clavulanic R 3 Piperaciclin R 4 Novobiocină R 5 Linezolid R 6 Meticilin R 7 Pristinamicin R 8 Metronidazol R Nr. crt. Antibiotic Zonă de inhibiție 1 Tetraciclină R 2 Ticarcilin + acid clavulanic 8 mm 3 Piperacilin 14 mm 4 Novobiocină R 5 Linezolid R 6 Meticilin R 7 Pristinamicin R 8 Metronidazol R Susceptibility of Stenotrophomonas maltophilia and Pseudomonas aeruginosa to different antibiotics and combinations of antibiotics
Figura 7 (a, b). S. maltophilia, placa 3, seria 1, antibiotice individuale (foto original)
1,
(foto original)
de
1, S. maltophilia
1, P. aeruginosa
Pentru placa 4 cu P. aeruginosa (Fig. 10), din cadrul primei serii, a funcționat doar Amikacina. Pentru Bacitracină, Kanamicină, Clindamicină, Cefquinome, Doxiciclină, Eritromicină și Florfenicol s-a constatat fenomenul de antibiorezistență.


Pentru placa 5 cu S. maltophilia (Fig. 11), din cadrul primei serii, s-au dovedit active următoarele antibiotice, în ordinea descrescătoare a eficacității: Ciprofloxacina, Gentamicina, Clorfenicol. Pentru Imipenem, Flucytosin, Ampicilină, Amoxicilină și Cefatoxim s-a constatat fenomenul de antibiorezistență.



301 Vol VII - Nr. 37 (5) 2022 Romanian Journal of Veterinary Medicine & Pharmacology
Tabelul 7. Zonele de inhibiție a plăcii 4, seria 1, S. maltophilia Figura 9 (a, b). S. maltophilia, placa 4, seria 1, antibiotice individuale (foto
Figura 10 (a, b). P. aeruginosa, placa 4, seria 1, antibiotice individuale (foto original) a a
b Nr. crt. Antibiotic Zonă de inhibiție 1 Amikacină 17 mm 2 Bacitracin R 3 Kanamicină 16 mm 4 Clindamicină R 5 Cefquinome R 6 Doxiciclină 15 mm 7 Eritromicină R 8 Florfenicol 33 mm
original)
b
Bianca-Maria Marcoci, S. Răpuntean
Pentru placa 5 cu P. aeruginosa (Fig. 12), din cadrul primei serii, s-au dovedit active următoarele antibiotice, în ordinea descrescătoare a eficacității: Imipenem, Cefatoxim și Gentamicină. Pentru Flucytosin, Clorfenicol, Ciprofloxacină, Ampicilină și Amoxicilină s-a constatat fenomenul de antibiorezistență.
Așadar, considerăm ca P. aeruginosa este sensibilă la antibioticele care au realizat o zonă de inhibiție mai mare de 17 mm (Imipenem și Kanamicină), are sensibilitate intermediară la cele cu o zonă de inhibiție aflată intre 10 și 17 mm (Gentamicină, Streptomicină, Cefatoxim, Marbofloxacină, Lincocină, Tobramicină, Piperacilină, Amikacină, Lincocin forte și Tetraciclină) și


Vol VII - Nr. 37 (5) 2022 302 STUDY
Nr. crt. Antibiotic Zonă de inhibiție 1 Amikacină 14 mm 2 Bacitracin R 3 Kanamicină R 4 Clindamicină R 5 Cefquinome R 6 Doxiciclină, R 7 Eritromicină R 8 Florfenicol R Nr. crt. Antibiotic Zonă de inhibiție 1 Imipenem R 2 Gentamicină 21 mm 3 Flucytosin R 4 Clorfenicol 19 mm 5 Ciprofloxacină 23 mm 6 Ampicilină R 7 Amoxicilină R 8 Cefatoxim R Tabelul 8. Zonele de inhibiție a plăcii 4, seria 1, P. aeruginosa Tabelul 9. Zonele de inhibiție a plăcii 4, seria 1, S. maltophilia Tabelul 10. Zonele de inhibiție a plăcii 5, seria 1, P. aeruginosa Figura 11 (a, b). S. maltophilia, placa 5, seria 1, antibiotice individuale (foto original) a b Nr. crt. Antibiotic Zonă de inhibiție 1 Imipenem 22 mm 2 Gentamicină 11 mm 3 Flucytosin R 4 Clorfenicol R 5 Ciprofloxacină R 6 Ampicilină R 7 Amoxicilină R 8 Cefatoxim 13 mm Susceptibility of Stenotrophomonas maltophilia and Pseudomonas aeruginosa to different antibiotics and combinations of antibiotics
este considerată rezistentă la antibioticele cu o zonă de inhibiție mai mică de 10 mm (Neomicină, Meropenem și Ticarcilină cu acid clavulanic).



S. maltophilia este sensibilă la antibioticele care au realizat o zonă de inhibiție mai mare de 17 mm (Amikacină, Pefloxacină, Lincocină, Lincocin forte, Ofloxacină, Cloramfenicol, Kanamicină, Gentamicină, Marbofloxacină, Tobramicină, Netilmicină, Ciprofloxacină, Minocyclină și Florfenicol), are sensibilitate intermediară la cele cu o zonă de inhibiție aflată intre 10 și 17 mm (Neomicină, Streptomicină, Doxiciclină,
Rifampicină, Tetraciclină) și este considerată rezistentă la antibioticele cu o zonă de inhibiție mai mică de 10 mm (Meropenem).
2.3.2. SERIA 2

În cadrul celei de a doua serii de plăci, au fost folosite combinații a câte două antibiotice. Acestea au fost alese atât raportat la rezultatele obținute în prima serie, cât și în funcție de diferite studii de specialitate și recomandări clinice.
La nivelul plăcii 1, cu S. maltophilia (Fig. 13), din cadrul celei de a doua serii, s-au dovedit active următoarele combinații de antibiotice, în ordinea descrescătoare a eficacității: Tobramicină + Lincocin, Florfenicol + Neomicină, Kanamicină + Lincocin forte și Florfenicol + Piperacilină. Nu s-au constatat fenomene de antibiorezistență.
303 Vol VII - Nr. 37 (5) 2022 Romanian Journal of Veterinary Medicine & Pharmacology
Tabelul 11. Zonele de inhibiție a plăcii
seria 2,
maltophilia, asocieri
antibiotice
1,
S.
de
Figura 12 (a, b). P. aeruginosa, placa 5, seria 1, antibiotice individuale (foto original)
a b Nr. crt. Antibiotic Zonă de inhibiție 1 Tobramicină + Lincocin 34 mm 2 Florfenicol + Neomicină 35 mm 3 Kanamicină + Lincocin forte 30 mm 4 Florfenicol + Piperacilină 35 mm
Figura 13. S. maltophilia, placa 1, seria 2, asocieri de antibiotice (foto original)
Bianca-Maria Marcoci, S. Răpuntean
La nivelul plăcii 1, cu P. aeruginosa (Fig. 14), din cadrul celei de a doua serii, s-au dovedit active următoarele combinații de antibiotice, în ordinea descrescătoare a eficacității: Tobramicină + Lincocin, Florfenicol + Neomicină, Kanamicină +Lincocin forte, Piperacilină + Florfenicol. Nu s-au constatat fenomene de antibiorezistență.


În cadrul acestei plăci, nu au avut loc fenomene de stimulare a efectului, dar nici a creșterii, în urma combinațiilor de antibiotice pe care le-am utilizat.
Figura 15. S. maltophilia, placa 2,
La nivelul plăcii 2, cu S. maltophilia (Fig. 15), din cadrul celei de a doua serii, s-au dovedit active următoarele combinații de antibiotice, în ordinea descrescătoare a eficacității: Lincocin forte + Ciprofloxacină, Imipenem + Monocyclină, Ciprofloxacină + Monocyclină, Neomicină + Amikacină. Nu s-au constatat fenomene de antibiorezistență.
Vol VII - Nr. 37 (5) 2022 304 STUDY
Figura 14. P. aeruginosa, placa 1, seria 2, asocieri de antibiotice (foto original)
Tabelul 12. Zonele de inhibiție a plăcii 1, seria 2, P. aeruginosa, asocieri de antibiotice Tabelul 13. Zonele de inhibiție a plăcii 2, seria 2, S. maltophilia, asocieri de antibiotice Nr. crt. Antibiotic Zonă de inhibiție 1 Tobramicină + Lincocin 22 mm 2 Florfenicol + Neomicină 8 mm 3 Kanamicină + Lincocin forte 23 mm 4 Piperacilină + Florfenicol 18 mm Nr. crt. Antibiotic Zonă de inhibiție 1 Imipenem + Minocyclină 29mm 2 Lincocin forte + Ciprofloxacină 31 mm 3 Ciprofloxacină + Minocyclină 29 mm 4 Neomicină + Amikacină 26 mm Susceptibility of Stenotrophomonas maltophilia and Pseudomonas aeruginosa to different antibiotics and combinations of antibiotics
seria 2, asocieri de antibiotice (foto original)
Figura 16. P. aeruginosa, placa 2, seria 2, asocieri de antibiotice (foto
La nivelul plăcii 2, cu P. aeruginosa (Fig. 16), din cadrul celei de a doua serii, s-au dovedit active următoarele combinații de antibiotice, în ordinea descrescătoare a eficacității: Imipenem + Mynociclină, Lincocin forte + Ciprofloxacină și Neomicină + Amikacină. Minocyclina a prezentat fenomenul de antibiorezistență.
Tabelul 14. Zonele de inhibiție a plăcii 2, seria 2, P. aeruginosa, asocieri de antibiotice

Figura 17. S. maltophilia, placa 3, seria 2, asocieri de antibiotice (foto original)
Tobramicină + Streptomicină și Pefloxacină + Lincocin forte. Nu s-au constatat fenomene de antibiorezistență.


Tabelul 15. Zonele de inhibiție a plăcii 3, seria 2, S. maltophilia, asocieri de antibiotice Nr. crt. Antibiotic Zonă de inhibiție
La nivelul plăcii 3, cu S. maltophilia (Fig. 17), din cadrul celei de a doua serii, s-au dovedit active următoarele combinații de antibiotice, în ordinea descrescătoare a eficacității: Imipenem + Florfenicol, Minocyclină + Netilmicină,
Pentru placa 3, cu P. aeruginosa (Fig. 18), din cadrul celei de a doua serii, s-au dovedit active următoarele combinații de antibiotice, în ordinea descrescătoare a eficacității: Imipenem + Florfenicol, Tobramicină + Streptomicină și Lincocină + Pefloxacină. Netilmicina a avut o zonă
305 Vol VII - Nr. 37 (5) 2022 Romanian Journal of Veterinary Medicine & Pharmacology
original)
1 Imipenem + Minocyclină 12 mm 2 Lincocin forte + Ciprofloxacină 8 mm 3 Ciprofloxacină + Minocyclină R 4 Neomicină + Amikacină 11 mm Nr. crt. Antibiotic Zonă de inhibiție 1 Imipenem + Florfenicol 27 mm 2 Netilmicină + Minocyclină 28 mm 3 Tobramicină + Streptomicină 25 mm 4 Pefloxacin + Lincocin forte 19 mm
Bianca-Maria Marcoci, S. Răpuntean
Figura 18. P. aeruginosa, placa 3, seria 2, asocieri de antibiotice (foto original)
redusă de inhibiție iar Minocyclina și Pefloxacina au prezentat fenomen de antibiorezistență.


Figura 19. S. maltophilia, placa 4, seria 2, asocieri de antibiotice (foto original)
cină, Amikacină + Eritromicină și Tobramicină + Eritromicină. Nu s-au constatat fenomene de antibiorezistență.
Tabelul 16. Zonele de inhibiție a plăcii 3, seria 2, P. aeruginosa, asocieri de antibiotice Tabelul 17. Zonele de inhibiție a plăcii 4, seria 2, S. maltophilia, asocieri de antibiotice
La nivelul plăcii 4, cu S. maltophilia (Fig. 19), din cadrul celei de a doua serii, s-au dovedit active următoarele combinații de antibiotice, în ordinea descrescătoare a eficacității: Imipenem + Eritromicină, Florfenicol + Eritromi-
La nivelul plăcii 4, cu P. aeruginosa (Fig. 20), din cadrul celei de a doua serii, au funcționat doar antibioticele individuale, în ordine des -
Vol VII - Nr. 37 (5) 2022 306 STUDY
Nr.
1 Imipenem
25
2 Lincocină +
13
3 Tobramicină + Streptomicină 18
4 Netilmicină + Minocyclină 8
Nr.
Antibiotic Zonă
1 Imipenem +
8
2 Florfenicol + Eritromicină 28
3 Amikacină + Eritromicină 23
4 Tobramicină + Eritromicină 26
Susceptibility of Stenotrophomonas maltophilia and Pseudomonas aeruginosa to different antibiotics and combinations of antibiotics
crt. Antibiotic Zonă de inhibiție
+ Florfenicol
mm
Pefloxacină
mm
mm
mm
crt.
de inhibiție
Eritromicină
mm
mm
mm
mm
Figura 20. P. aeruginosa, placa 4, seria 2, asocieri de antibiotice (foto original)
crescătoare a eficacității: Imipenem, Florfenicol, Amikacina și Tobramicina. Eritromicina a prezentat fenomen de antibiorezistență, în toate cele patru combinații.


Tabelul 18. Zonele de inhibiție a plăcii 4, seria 2, P. aeruginosa, asocieri de antibiotice

Figura 21. S. maltophilia, placa 5, seria 2, asocieri de antibiotice (foto original)
kacină + Florfenicol, Kanamicină + Neomicină și Ciprofloxacină + Eritromicină. Combinația Clorfenicol + Lincocin a prezentat fenomene de antibiorezistență.
Tabelul 19. Zonele de inhibiție a plăcii 3, seria 2, S. maltophilia, asocieri de antibiotice
La nivelul plăcii 5, cu S. maltophilia (Fig. 21), din cadrul celei de a doua serii, s-au dovedit active următoarele combinații de antibiotice, în ordinea descrescătoare a eficacității: Ami -
La nivelul plăcii 5, cu P. aeruginosa (Fig. 22), din cadrul celei de a doua serii, s-au dovedit active doar două antibiotice individuale: Amikacina și Kanamicina. Celelalte
307 Vol VII - Nr. 37 (5) 2022 Romanian Journal of Veterinary Medicine & Pharmacology
1
3
4
Nr.
1
2
3
4
Nr. crt. Antibiotic Zonă de inhibiție
Imipenem (+ Eritromicină) 23 mm 2 Florfenicol (+ Eritromicină) 8 mm
Amikacină (+ Eritromicină) 21 mm
Tobramicină (+ Eritromicină) 18 mm
crt. Antibiotic Zonă de inhibiție
Amikacină + Florfenicol 33 mm
Clorfenicol + Lincocin R
Kanamicină + Neomicină 27 mm
Ciprofloxacină + Eritromicină 17 mm
Bianca-Maria Marcoci, S. Răpuntean
antibiotice au prezentat fenomene de antibiorezistență.


2.3.3. SERIA 3
În a treia serie de plăci au fost folosite tot combinații de câte două antibiotice atât
Figura 23. S. maltophilia, placa 1, seria 3, asocieri de antibiotice (foto original)
Antibioticele vor fi descrise în sensul acelor de ceas.
La nivelul plăcii 1, cu S. maltophilia (Fig. 23), din cadrul celei de a treia serii, au funcționat următoarele combinații de antibiotice, în ordine descrescătoare a eficacității: Penicilină + Florfenicol, Penicilină + Lincocin forte. Mecillinam + Penicilină și Penicilină + Neomicină au prezentat fenomene de antibiorezistență.
în funcție de rezultatele obținute în prima și a doua serie, cât și în funcție de diferite studii de specialitate și recomandări clinice.
nivelul plăcii 1, cu P. aeruginosa (Fig. 24), din cadrul seriei trei, nu a funcționat nici o com -
Vol VII - Nr. 37 (5) 2022 308 STUDY
La
Tabelul 20. Zonele de inhibiție a plăcii 5, seria 2, P. aeruginosa, asocieri de antibiotice Tabelul 21. Zonele de inhibiție a plăcii 1, seria 3, S. maltophilia, asocieri de antibiotice Nr. crt. Antibiotic Zonă de inhibiție 1 Amikacină + Florfenicol 16 mm 2 Clorfenicol + Lincocin R 3 Kanamicină + Neomicină 21 mm 4 Ciprofloxacină + Eritromicină R Nr. crt. Antibiotic Zonă de inhibiție 1 Penicilină + Mecillinam R 2 Penicilina + Florfenicol 23 mm 3 Penicilină + Neomicină R 4 Penicilină + Lincocin forte 20 mm Susceptibility of Stenotrophomonas maltophilia and Pseudomonas aeruginosa to different antibiotics and combinations of antibiotics
Figura 22. P. aeruginosa, placa 5, seria 2, asocieri de antibiotice (foto original)
Figura 24. P. aeruginosa, placa 1, seria 3, asocieri de antibiotice (foto original)
binație de antibiotice, Lincocin forte fiind singurul eficient. Restul antibioticelor au prezentat fenomene de antibiorezistență.


Figura 25. S. maltophilia, placa 2, seria 3, asocieri de antibiotice (foto original)
micină + Cefatoxim și Neomicină + Kanamicină au prezentat fenomene de antibiorezistență.

La nivelul plăcii 2, cu S. maltophilia (Fig. 25), din cadrul seriei trei, s-au dovedit active următoarele combinații de antibiotice, în ordinea descrescătoare a eficacității: Spiramicină + Ofloxacină, Doxiciclină + Lincocin forte. Spira -
În placa 2, cu P. aeruginosa (Fig. 26), din cadrul seriei trei, a fost activ doar Lincocin forte. Restul antibioticelor au prezentat fenomene de antibiorezistență.
La nivelul plăcii 3, cu S. maltophilia (Fig. 27), din cadrul celei de a treia serii, s-au dovedit active următoarele combinații de antibiotice,
309
Romanian Journal of Veterinary Medicine & Pharmacology
Vol VII - Nr. 37 (5) 2022
asocieri de antibiotice Nr. crt. Antibiotic Zonă de inhibiție 1 Penicilină + Lincocin forte 11 mm 2 Mecillinam + Penicilină R 3 Penicilină + Florfenicol R 4 Penicilină + Neomicină R
Nr.
1 Spiramicină + Ofloxacină 20 mm 2 Spiramicină + Cefatoxim R 3 Doxiciclină + Lincocin forte 20 mm 4 Neomicină + Kanamicină R
Tabelul 22. Zonele de inhibiție a plăcii 1, seria 3, P. aeruginosa,
Tabelul 23. Zonele de inhibiție a plăcii 2, seria 3, S. maltophilia, asocieri de antibiotice
crt. Antibiotic Zonă de inhibiție
Bianca-Maria Marcoci, S. Răpuntean
Figura 26. P. aeruginosa, placa 2, seria 3, asocieri de antibiotice (foto original)
Tabelul 24. Zonele de inhibiție a plăcii 2, seria 3, P. aeruginosa, asocieri de antibiotice
Nr. crt. Antibiotic Zonă de inhibiție 1
Spiramicină + Ofloxacină R 2 Spiramicină + Cefatoxim R 3
Doxiciclină + Lincocin forte 16 mm 4
Neomicină + Kanamicină R
în ordinea descrescătoare a eficacității: Florfenicol + Flucytosin și Imipenem + Amikacină. Ticarcilină/acid clavulanic + Oxacilină și Imipenem + Cefuroxim au prezentat fenomene de antibiorezistență.


În cadrul plăcii 3, cu P. aeruginosa (Fig. 28), din seria trei, s-au dovedit active următoarele combinații de antibiotice, în ordinea descrescătoare a eficacității: Imipenem + Amikacină și Imipenem + Amikacină. Ticarcilina/acid clavulanic + Oxacilină și Florfenicol + Flucytosin au prezentat fenomene de antibiorezistență.
Figura 27. S. maltophilia, placa 3, seria 3, asocieri de antibiotice (foto original)
Tabelul 25. Zonele de inhibiție a plăcii 3, seria 3, S. maltophilia, asocieri de antibiotice
Nr. crt. Antibiotic Zonă de inhibiție 1
Ticarcilină/acid clavulanic + Oxacilină R 2 Imipenem + Amikacină 20 mm 3 Florfenicol + Flucytosin 24 mm 4
Imipenem + Cefuroxim R
La nivelul plăcii 4, cu S. maltophilia (Fig. 29), din cadrul celei de a treia serii, au funcționat următoarele combinații de antibiotice, în ordine descrescătoare a eficacității: Marbofloxacin + Nitrocefin*, Oxacilin + Amikacină și Azocilină + Oxitetracilină. Isepamicim + Fosfomycină au prezentat fenomene de antibiorezistență.
Vol VII - Nr. 37 (5) 2022 310 STUDY
Susceptibility of Stenotrophomonas maltophilia and Pseudomonas aeruginosa to different antibiotics and combinations of antibiotics
În cadrul acestei plăci, nu au avut loc fenomene de stimulare a efectului, în urma combinațiilor de antibiotice pe care le-am utilizat, dar a fost stimulată creșterea, în cazul microcomprimatului de Nitrocefin* (singurul antibiotic, utilizat în acest studiu, care a determinat o astfel de reacție).

La nivelul plăcii 4, cu P. aeruginosa (Fig. 30), din cadrul celei de a treia serii, nu a funcționat nicio combinație de antibiotice. Amikacina a avut o zonă de inhibiție de 16 mm, iar restul asocierilor (Marbofloxacină + Nitro -

Tabelul 26. Zonele de inhibiție a plăcii 3, seria 3, P. aeruginosa, asocieri de antibiotice
Nr. crt. Antibiotic Zonă de inhibiție
Ticarcilin și acid clavulanic + Oxacilină R 2 Imipenem + Amikacină 26 mm 3 Florfenicol + Flucytosin R 4 Imipenem + Cefuroxim 20 mm
1

Tabelul 27. Zonele de inhibiție a plăcii 4, seria 3, S. maltophilia, asocieri de antibiotice
Nr. crt. Antibiotic Zonă de inhibiție
1 Oxacilină + Amikacină 21 mm 2 Marbofloxacină + Nitrocefin* 28 mm 3 Isepamicim + Fosfomycină R 4 Azocilină + Oxitetraciclină 8 mm

311 Vol VII - Nr. 37 (5) 2022 Romanian Journal of Veterinary Medicine & Pharmacology
Figura 28. P. aeruginosa, placa 3, seria 3, asocieri de antibiotice (foto original)
a
Figura 29 (a, b). S. maltophilia, placa 4, seria 3, asocieri de antibiotice și detaliu (foto original)
b
Bianca-Maria Marcoci, S. Răpuntean
Figura 30. P. aeruginosa, placa 4, seria 3, asocieri de antibiotice (foto original).
Tabelul 28. Zonele de inhibiție a plăcii 4, seria 3, P. aeruginosa, asocieri de antibiotice
Figura 31. S. maltophilia, placa 5, seria 3, asocieri de antibiotice (foto original)
Tabelul 29. Zonele de inhibiție a plăcii 5, seria 3, S. maltophilia, asocieri de antibiotice
cefin, Isepamicim + Fosfomycin și Azocilină + Oxitetraciclină) au prezentat fenomene de antibiorezistență.
La nivelul plăcii 5, cu S. maltophilia (Fig. 31), din cadrul seriei trei, s-au dovedit active următoarele combinații de antibiotice, în ordinea descrescătoare a eficacității: Amphotericină B + Ceftazidim și Cefuroxim + Ceftazidim. Kanamicina a prezentat antibiorezistență.
La nivelul plăcii 5, cu P. aeruginosa (Fig. 32), din cadrul seriei trei, nu a funcționat nici o combinație de antibiotice, cu excepția Ceftazidim.
DISCUȚII ȘI CONCLUZII
Antibiorezistența a fost și va rămâne, în continuare, un subiect emergent atât al medicinei veterinare, cât și umane, reprezentand, tot mai mult, un motiv de îngrijorare pe scară largă. Momentan, asocierile de antibiotice reprezintă speranța și soluția actuală a terapiei anti-microbiene.
Pentru P. aeruginosa , în cadrul antibioticelor individuale, Imipenemul și Kanamicina au fost antibioticele individuale care au avut eficacitatea


Vol VII - Nr. 37 (5) 2022 312 STUDY
1 Oxacillin +Amikacină
2 Marbofloxacină + Nitrocefin R 3 Isepamicim + Fosfomycin R 4 Azocilin + Oxitetraciclină R Nr.
1
2
3
+
17
4
+
R
Nr. crt. Antibiotic Zonă de inhibiție
16 mm
crt. Antibiotic Zonă de inhibiție
Kanamicină + Oxacillin R
Cefuroxim + Ceftazidim 15 mm
Amphotericin B
Ceftazidim
mm
Cefazolim
Cefepim
Susceptibility of Stenotrophomonas maltophilia and Pseudomonas aeruginosa to different antibiotics and combinations of antibiotics
cea mai mare, realizând câte o zonă de inhibiție de 22 mm. Ca și combinații de antibiotice, seriile care au funcționat cel mai bine au fost Imipenem + Amikacină, fiecare marcând câte o zonă de inhibiție egală cu 26 de mm.
Pentru S. maltophilia , antibioticul individual care a avut eficacitatea cea mai mare a fost Florfenicol, cu o zonă de inhibiție de 33 de mm. Florfenicol + Piperacilină au fost perechile de antibiotice care au funcționat cel mai bine, cu o zonă de inhibiție de 35 mm.
Tabelul 30. Zonele de inhibiție a plăcii 5, seria 3, P. aeruginosa, asocieri de antibiotice
Nr. crt. Antibiotic Zonă de inhibiție 1
Kanamicină + Oxacillin 0 mm
Cefuroxim + Ceftazidim 0 mm 3
Amphotericin B + Ceftazidim 13 mm 4
Cefazolim + Cefepim 0 mm
Efectele antibiotice obținute în studiul actual au fost variabile.
DISCLAIMER
Prezenta lucrare a fost editată în baza cercetărilor efectuate de către cei doi autori, în cadrul studiului pentru lucrarea de Licență a domnișoarei Bianca-Maria MARCOCI, susținută public în cursul anului 2022, și conține pasaje și imagini originale din respectiva teză.
This work is licensed under a Creative Commons Attribution-NonCommercialNoDerivatives 4.0 International License.

Bibliografie
1. Henry R. (2012). “Etymologia: Pseudomonas”. Emerging Infectious Diseases;
2. Funke G. (2016). Microbiology: An Introduction (12th ed.). Pearson Education. p. 54;
3. Jennifer Rattray, Ryan Walden, Pedro Marquez Zacarias, Evgeniya Molotkova, Gabriel Perron, Claudia Solis-Lemus, Daniel Pimentel Alarcon, Sam P. Brown (2022). Machine learning identification of Pseudomonas aeruginosa strains from colony image data, doi: https://doi.org/10.1101/2022.09.02.506375;
4. Hahn H.P. (1997). The type-4 pilus is the major virulence-
associated adhesin of Pseudomonas aeruginosa--a review. Gene. 1997 Jun 11;192(1):99-108. doi: 10.1016/s0378-1119(97)001169. PMID: 9224879.
5. Răpuntean S., Răpuntean Ghe. (2021). Stenotrophomonas maltophilia, an emerging pathogen with multiple antibiotic resistance, Rom J Vet Med Pharm.; Vol. VI 32(6):260-271;

6. Kim YJ, Jeon H, Na SH, Kwon HI, Selasi GN, Nicholas A. (2016). Carbonetti N (ed.). „Stenotrophomonas maltophilia outer membrane vesicles elicit a potent inflammatory response in vitro and in vivo”.

313 Vol VII - Nr. 37 (5) 2022 Romanian Journal of Veterinary Medicine & Pharmacology
Figura 32. P. aeruginosa, placa 5, seria 3, asocieri de antibiotice (foto original)
2
Bianca-Maria Marcoci, S. Răpuntean
EDUCAȚIE
Dr. Bianca-Maria MARCOCI

Octombrie 2016 - iulie 2022. Studentă la Universitatea de Științe Agricole și Medicină Veterinară din Cluj-Napoca, Facultatea de Medicină Veterinară.
CURSURI
Decembrie 2017. “The 66th IVSA Symposium in South Africa”. Facultatea de Medicină Veterinară din Pretoria (Africa de Sud).
August 2018. “The 66th IVSA Congress in Poland”. Facultatea de Medicină Veterinară din Krakow (Republica Polonă). Noiembrie 2019. Schimb de experiență în Scoția. Facultatea de Medicină Veterinară din Edinburgh.
Decembrie 2020. Schimb de experiență în Țările de Jos (Olanda). Facultatea de Medicină Veterinară din Utrecht.
Octombrie 2018. Junior Vet “How to save a life”. Universitatea de Științe Agricole și Medicină Veterinară din Cluj-Napoca, Facultatea de Medicină Veterinară.
EXPERIENȚĂ PROFESIONALĂ
Octombrie 2022 – Prezent. Medic Veterinar la “Terra Vet” Bacău, județul Bacău.
Vol VII - Nr. 37 (5) 2022 314 STUDY CV
Susceptibility of Stenotrophomonas maltophilia and Pseudomonas aeruginosa to different antibiotics and combinations of antibiotics




S. Răpuntean, Ghe. Răpuntean N. Starciuc, R. Antoci R.N. Malancus SUBMITTING ARTICLES! For submitting scientific articles, please read & respect the instructions for authors. The instructions for authors can be found at http://www.rjvmf.innovationinhealth.ro/instructions-for-authors/ You can send your articles together with pictures, tables or graphics at redactia.ihc@gmail.com. www.rjvmf.innovationinhealth.ro Romanian Journal of Veterinary Medicine & Pharmacology
Cite this article: S. Răpuntean, Ghe. Răpuntean Susceptibility of domestic and wild animal species to SARS CoV-2 naturally infection (review). Rom J Vet Med Pharm. 2022; Vol. VII 37(5):316-328.
SUSCEPTIBILITATEA SPECIILOR DE ANIMALE DOMESTICE ȘI SĂLBATICE LA INFECȚIA CU SARS COV-2, ÎN CONDIȚII NATURALE (STUDIU BIBLIOGRAFIC)
SUSCEPTIBILITY OF DOMESTIC AND WILD ANIMAL SPECIES TO SARS COV-2 NATURALLY INFECTION (REVIEW)
Conf. Univ. Dr. Sorin Răpuntean, Prof. Univ. Dr. Gheorghe Răpuntean University of Agriculture Sciences and Veterinary Medicine, Cluj-Napoca, Romania. Faculty of Veterinary Medicine, 3-5 Mănăștur Street, 400372
Recieved: October 2022 Accepted: October 2022
REZUMAT
OPEN ACCES JOURNAL
Corresponding author: Sorin Răpuntean, E-mail sorin.rapuntean@gmail.com
Sindromul respirator acut sever Coronavirus (SARS-CoV-2), agentul cauzal al actualei pandemii de COVID-19, a evoluat pentru a avea o gamă largă de gazde, inclusiv primate non-umane, animale sălbatice și domestice. Determinarea susceptibilității diferitelor specii de animale la infecția cu SARS-CoV-2 și a rolului animalelor în epidemiologia bolii va fi esențială pentru conceperea răspunsurilor adecvate de sănătate publică umană și veterinară la această pandemie. O mai bună înțelegere a susceptibilității speciilor de animale la SARS-CoV-2 poate ajuta la clarificarea mecanismelor de transmitere și la identificarea potențialelor rezervoare și surse de infecție care sunt importante atât pentru sănătatea animală, cât și pentru cea umană. Actuala pandemie produsă de SARS CoV-2 și variantele sale reprezintă un exemplu al conceptului unic de sănătate (One Health) în care oamenii și animalele sunt componente ale aceluiași lanț epidemiologic. În prezenta lucrare, vor fi trecute în revistă numai infecțiile naturale constatate la diferite specii de animale, conform datelor din literatură, fiind făcute precizări privind specia de animale afectată, modul de transmitere (om-animal, animal-om), aspecte clinice, metodele de confirmare a diagnosticului și o succintă prezentare a posibilităților de prevenire prin vaccinare.
CUVINTE-CHEIE:
SARS-CoV-2, animale, infecții
naturale
Vol VII - Nr. 37 (5) 2022 316
REVIEW
(review)
Susceptibility of domestic and wild animal species to SARS CoV-2 naturally
infection
ABSTRACT
Severe acute respiratory syndrome coronavirus (SARS-CoV-2), the causative agent of the current COVID-19 pandemic, has evolved to have a wide range of hosts, including non-human primates, wild and domestic animals. Determining the susceptibility of different animal species to SARS-CoV-2 infection and the role of animals in the epidemiology of the disease will be critical to designing appropriate human and veterinary public health responses to this pandemic. A better understanding of the susceptibility of animal species to SARS-CoV-2 may help clarify transmission mechanisms and identify potential reservoirs and sources of infection that are important for both animal and human health. The current pandemic produced by SARS CoV-2 and its variants represents an example of the unique concept of health (One Health) in which humans and animals are components of the same epidemiological chain. In this paper, only the natural infections found in different animals species will be reviewed, according to literature data, regarding the species of affected animals, the transmission patterns (human-animal, animal-human), clinical aspects, diagnosis confirmation and a brief presentation of the prevention possibilities through vaccination.
KEYWORDS: SARS-CoV-2, animals, natural infections
INTRODUCERE
SARS-CoV-2 are o răspândire globală, cu o transmitere rapidă de la om la om, producând cea mai mare pandemie începând din decembrie 2019, devenind o urgență de sănătate publică la nivel mondial. În acest context epidemiologic, s-a constatat capacitatea acestui virus de a infecta multiple specii de animale, cu încadrare în următoarele familii: Canidae, Cebidae, Cercopithecidae, Cervidae, Cricetidae, Callitrichidae, Felidae, Hominidae, Hyaenidae, Mustelidae, Procynoidae, Viverridae, Hippopotamidae, Myrmecophagidae (1)(2)(3)(4). Cu toate acestea, nu toate speciile par a fi susceptibile la SARS-CoV-2. S-a constatat că acest virus, în condiții naturale, are potențial de a se propaga de la o specie la alta și, în rare ocazii, s-a evidențiat răspândirea de la animale la oameni, fiind menționată transmiterea de la nurcă la om și de la hamster la om (5), ca și transmiterea de la nurcă la nurcă și de la nurcă la pisică (6)(7). Țări și teritorii care au raportat cazuri la animale, în baza cercetărilor virusologice, sunt în număr de 39, până la data de 7 septembrie 2022 (3) (4). În prezent, la nivel global au fost raportate 675 de focare la animale, care afectează 23 de specii (3)(4). S-a demonstrat că, în condiții naturale, mai multe specii de animale pot fi infectate cu SARS-CoV-2, fiind raportate infecții naturale la animale domestice, captive și sălbatice, când sunt în contact strâns cu oameni infectați (8) (6). Animalele non-umane sunt susceptibile la virus, inclusiv mamiferele marine (9). Fiind un virus zoonotic, afectează o gamă largă de ani -
male, ce pot servi drept rezervoare potențiale, care vor facilita evoluția virală și apariția unor noi variante (10). Transmiterea SARS-CoV-2 de la om la animale poate conduce la stabilirea de noi rezervoare și la evoluția de noi variante cu potențial de a declanșa noi focare la oameni (11) . Ca virus zoonotic, implicațiile pentru populațiile de animale și amploarea infecțiilor naturale sunt în mare parte necunoscute și necesită, în continuare, să fie monitorizate (12)(13)(6)(7). Se consideră că infecțiile naturale și rolurile epidemiologice ale animalelor de companie în transmiterea SARS-CoV-2 nu sunt pe deplin înțelese (14). Deși au fost raportate multe cazuri de transmitere a SARS-CoV-2 la animale, se impune efectuarea de studii suplimentare pentru o mai bună înțelegere a dinamicii bolii în mediu, la oameni și animale, iar interfața animale-om ar putea ajuta la formularea și implementarea măsurilor de preventive și de combatere (15)
Determinarea susceptibilității diferitelor specii de animale la infecția cu SARS-CoV-2 și a rolului animalelor în epidemiologia bolii va fi esențială pentru conceperea răspunsurilor adecvate de sănătate publică umană și veterinară la această pandemie. Având în vedere milioanele de cazuri de COVID-19 din întreaga lume și potențialul continuu de transmitere virală zoonotică și antroponotică, în continuare sunt necesare activități de cercetare și supraveghere suplimentare pentru a determina definitiv rolul animalelor în transmiterea comunitară a SARS-CoV-2 (16) O mai bună înțelegere a susceptibilității speciilor de animale la SARS-CoV-2 poate ajuta la

317
Romanian Journal of Veterinary Medicine & Pharmacology
Vol VII - Nr. 37 (5) 2022
S. Răpuntean, Ghe. Răpuntean
clarificarea mecanismelor de transmitere și la identificarea potențialelor rezervoare și surse de infecție care sunt importante atât pentru sănătatea animală, cât și pentru cea umană (17) Datorită originii sale zoonotice, SARS-CoV-2 poate fi relevant și pentru animale (18). Natura pandemică a SARS-CoV-2 crește probabilitatea transmiterii infecției de la oameni la specii de animale sensibile care, astfel, ar putea deveni gazde virale secundare și chiar rezervoare ale virusului (19). Se subliniază că o abordare One Health este importantă pentru prevenirea și controlul transmiterii SARS-CoV-2 (14)(20). Actuala pandemie produsă de SARS CoV-2 și variantele sale reprezintă un exemplu al conceptului unic de sănătate, în care oamenii și animalele sunt componente ale aceluiași lanț epidemiologic (21). Animalele prezintă riscuri diferite și necunoscute încât trebuie încă să învățăm despre SARS-CoV-2 la animale și este crucial să aflăm dacă vreo specie ar putea deveni rezervor pentru virus (22)(23) .
În prezenta lucrare, vor fi trecute în revistă numai infecțiile naturale constatate la diferite specii de animale: domestice, captive (grădini zoologice sau rezervații) și sălbatice.
CARACTERE GENERALE
Familia Coronaviridae grupează numeroase virusuri cu încadrare în următoarele genuri: Alfacoronavirus, Betacoronavirus (divizat în 4 subgrupe A, B, C, D), Gammacoronavirus și Deltacoronavirus (24). În cadrul familiei, respectiv a genurilor, sunt grupate mai mult de 60 de specii, cu izolare de la oameni, bovine, porcine, canine, feline, murine, iepuri, păsări, șoareci, șobolani, lilieci. Se evidențiază identificarea a numeroase noi coronavirusuri și tendința membrilor acestei familii de virusuri de a trece barierele speciilor (25). Se consideră că SARS-CoV-2 se reproduce slab la câini, porci, găini și rațe, dar dihorii și pisicile sunt permisive la infecție (26) . Nevertebratele, păsările, reptilele și amfibienii nu sunt susceptibile la infecția cu SARS-CoV-2 (20). Coronavirusul sindromului respirator acut sever (SARS-CoV-2), agentul cauzal al actualei pandemii de COVID-19, a evoluat pentru a avea o gamă largă de gazde, inclusiv primate non-umane, animale sălbatice și domestice (27) Sunt virusuri cu dimensiuni de 80-220 nm, sferice sau ovoidale, anvelopate, cu proeminențe pedunculate ce au extremitățile rotunjite și dispuse în coroană, ceea ce le-a atras denumirea de coronavirusuri. Nucleocapsida este helicală, genomul fiind alcătuit din ARNmc, monopartit, linear, sens pozitiv, mărimea 26,4-31,7 kb (24). S-au identificat patru proteine structurale: spike (S), membranară (M), anvelopei (E) și nuclecapsidei
(N). Sunt virusuri larg răspândite în natură, provocând îmbolnăviri la un număr variat de gazde naturale, cu manifestări clinice sau cu evoluție asimptomatică. Diversitatea coronavirusurilor este rezultatul “infidelității” ARN polimerazei ARN dependente, a înaltei frecvențe a recombinărilor ARN omolog și a mărimii genomului, acesta fiind cel mai mare din toate genomurile virale cu ARN (28). Genomul mare a oferit acestei familii de virusuri o plasticitate suplimentară în acomodarea și modificarea genelor (24). Modificările genetice ce se produc sub influența a diferiți factori se clasifică astfel: linii, recombinanți, mutații și variante (Alfa, Beta, Gamma, Delta, Omicron) (29)
Între toate gazdele, diversitatea coronvirusurilor este cea mai evidentă la lilieci și păsări, care poate fi rezultatul diversității speciilor respective, a capacității lor de a zbura și viețuirea în grupuri, colonii sau stoluri mari. O dată cu creșterea numărului de coronavirusuri, au fost observate înrudiri mai mult sau mai puțin distanțate, care ar fi rezultatul unor recente “salturi” și care ar putea fi cauza unor dezastruoase izbucniri de boli zoonotice (28)(8). O gamă largă de specii de mamifere poate fi susceptibilă la infecția cu SARSCoV-2. Cu toate acestea, se subliniază faptul că gazdele originale și intermediare ale virusului rămân necunoscute (26)(6)(7). Este menționată și o posibilă transmitere virală între specii, ceea ce creează și mai multe dificultăți în studierea lor (30). Ar fi important să se cunoască, mai ales, dacă unele animale sunt gazde amplificatoare. Sunt necesare studii suplimentare pentru a urmări variantele și mutațiile și pentru a înțelege modul în care SARS-CoV-2 se răspândește între oameni și animale (20). În consecință, populațiile de animale sensibile, în contact strâns cu oamenii, ar trebui monitorizate îndeaproape (6). Locurile primare de multiplicare a coronavirusurilor sunt celulele epiteliale din aparatul respirator și/sau din tubul digestiv, dar pot fi atinse și alte țesuturi, inclusiv cele neuronale. Pătrunderea în celule este mult influențată de prezența receptorului ACE2 (angitensin-converting-enzyme2) (31)(30)
Spectrul clinic al bolilor pentru virusul SARSCoV-2 rămâne în mare parte nedefinit la animale. Cele de companie pot prezenta manifestări clinice respiratorii sau gastrointestinale, asemănătoare altor infecții cu coronavirusuri întâlnite mai frecvent la animale, precum și a celor emergente, inclusiv infecția cu SARS-CoV-1. Semnele clinice susceptibile de a fi compatibile cu infecția cu SARS-CoV-2 la animalele mamifere pot include o combinație dintre următoarele: febră, tuse, respirație dificilă sau dificultăți de respirație, letargie, strănut, scurgeri nazale, scurgeri oculare, vărsături, diaree (32)(33). Ca și la om, este
Vol VII - Nr. 37 (5) 2022 318
REVIEW
Susceptibility of domestic and wild animal species to SARS CoV-2 naturally infection (review)
posibil să apară infecții ușoare sau asimptomatice, care ar trebui luate în considerare investigațiile epidemiologice (33). În declarația comună din 7 martie 2022, Oficiul Internațional pentru Epizootii (OIE), Organizația Mondială a Sănătății (OMS) și Organizația pentru Alimentație și Agricultură a Națiunilor Unite (FAO) subliniază riscul prezentat de rezervorul animal al SARS-CoV-2 și rolul său potențial în apariția de noi variante prin mutație sau recombinare (34) .
INFECȚII NATURALE LA ANIMALE DOMESTICE DE COMPANIE
Infecția cu SARS-CoV-2 la animalele domestice este legată de contactul strâns cu oamenii diagnosticați cu COVID-19. În ciuda contactului frecvent întâlnit dintre animale și om, se știe puțin despre predispoziția animalelor de companie la SARS-CoV-2 (35). Conform literaturii disponibile (anul 2021), peste 598 de infecții naturale cu SARS-CoV-2 au fost detectate la 14 specii diferite de animale, inclusiv pisici, câini, feline mari, gorile, nurci și căprioare (10). Se menționează, totuși, că sunt disponibile puține informații privind susceptibilitatea animalelor de companie la SARS-CoV-2 în condiții naturale (36) .

Detectarea sporadică a cazurilor naturale la animale ridică întrebări cu privire la susceptibilitatea acestora în condiții naturale de proprietate a animalelor de companie. Un studiu efectuat în Italia, pe 919 animale de companie, eșantionate la un moment în funcție de infecție umană frecventă, arată că niciun animal nu a fost testat pozitiv prin PCR pentru SARS-CoV-2, însă serologic s-au detectat anticorpi neutralizanți la 3,3% din câini (numărul fiind mai mare la cei din gospodăriile pozitive) și 5,8% din pisici (37)
Infecțiile cu SARS-CoV-2 care apar în mod natural la animale par neobișnuite și se presupune, în majoritatea cazurilor, că infecția s-a produs prin contactul apropiat cu pacienți cu COVID-19. Ele evoluează, de obicei, asimptomatic la câini, cu manifestări clinice respiratorii și/sau gastrointestinale ușoare până la moderate la feline și severe până la fatale la nurci (16)
I NFECȚII NATURALE LA PISICI ȘI CÂINI
Câinii și pisicile domestice sunt animalele de companie cel mai frecvent expuse infecției cu SARS-CoV-2, în multe situații având un contact strâns cu stăpânii sau proprietarii lor. Studiile emergente au arătat că infecția naturală cu SARS-CoV-2 a câinilor și pisicilor de companie este posibilă, dar prevalența acesteia nu este pe deplin înțeleasă. Cu aproximativ 470 milioane de câini de companie și 370 de milioane de pisici, care coabitează cu stăpânii lor în întreaga lume, descoperirea infecției naturale cu SARS-CoV-2
la aceste animale de companie are implicații importante pentru potențiale evenimente de transmitere zoonotică (38) Pisica domestică ( Felis catus ). Studiile de susceptibilitate la SARS-CoV-2 la pisici arată că virusul se poate replica la aceste animale de companie și se poate transmite altor pisici, chiar altor feline, ele fiind susceptibile și la transmiterea prin aer (26). Se descrie infecția la o pisică domestică la care s-au constatat clinic semne clare de pneumonie; din probă de tampon nazal, se confirmă infecția cu SARS-CoV-2, utilizând RT-qPCR și se subliniază posibilul rol al animalelor de companie ca rezervor viral (35). O pisică a dezvoltat un sindrom respirator sever la o săptămână după ce proprietarul a fost testat pozitiv cu SARS-CoV-2; se precizează că ARNul viral a fost detectat în probe recoltate de la pisică (tampoan nazofaringian, lichid de vomă și fecale), fiind suspectată transmiterea de la om la pisică (39). Un alt caz este descris la o pisică de interior care prezenta semne respiratorii (leziuni de pneumonie confirmate radiologic) și un sindrom gastrointestinal, apărute după ce proprietarii au fost diagnosticați pozitiv cu COVID-19; tampoane nazale și orofaringiene recoltate de la pisică au fost pozitive pentru virus prin RT-qPCR (Real Time - quantitative Polymerase Chain Reaction), menținându-se pozitive după 31 de zile. La examenul serologic s-au evidențiat anticorpi specifici prin ELISA, electrochimioluminiscență și test de neutralizare, titrul menținându-se ridicată după 31 de zile. Studiul sugerează că expunerea de SARS-CoV-2 ar putea duce la o infecție naturală cu pneumonie la pisici, cu o posibilă persistență prelungită a virusului în căile respiratorii superioare (40)
Se menționează, în acest sens, un studiu în care pisici, infectate experimental pe cale intranazală și orală, au transmis virusul la două pisici santinelă (toate pisicile au fost clinic asimptomatice); ARN viral a fost detectat tranzitoriu în tampoane nazale, orofaringiene și rectale, ca și în lichid de lavaj bronhoalveolar și în diferite țesuturi la pisicile infectate, iar la examenul serologic s-a constatat că ambele categorii (infectate și santinele) au dezvoltat anticorpi împotriva SARS-CoV-2. Se apreciază că pisica este o gazdă susceptibilă în mod natural la infecția cu SARSCoV-2 (41). Transmiterea între pisici inoculate cu SARS-CoV-2 și pisici fără infecție, găzduite împreună cu cele infectate, este menționată în o altă lucrare, precizându-se că este necesar să se investigheze în continuare lanțul potențial de transmitere om-pisică-om (42). În urma testării a 50 de pisici (probe respiratorii și de fecale) din gospodării cu proprietari bolnavi de SARSCoV-2 sau în care au existat contacte strânse,
Vol VII - Nr. 37 (5) 2022
Romanian Journal of Veterinary Medicine & Pharmacology
319
S. Răpuntean, Ghe. Răpuntean
s-au constatat 6 cazuri de transmitere aparentă de om la pisică, aspect confirmat prin secvențiere genomică, constatându-se identitatea dintre o pisică și proprietarul acesteia (43). Un caz pozitiv la SARS-CoV-2 este descris și în Spania, la o pisică ce a prezentat tulburări respiratorii severe pe un fond de cardiomiopatie hipertrofică, ARN-ul viral SARS-CoV-2 fiind detectat în tampoan nazal, cornetele nazale și limfonodul mezenteric; unii membrii ai familiei erau afectați de COVID-19 (44). Un alt caz de transmitere de la om este raportat la un motan de 11 ani, cu viață exclusiv în interior, împreună cu proprietarii care au fost testați pozitiv prin RT-PCR pentru SARS-CoV-2; proba rectală colectată de la pisică a fost pozitivă pentru SARS-CoV-2 prin RT-PCR, iar secvențele de genom viral din probe de la oameni și pisică au arătat o identitate de 99,4%, fiind dovedită, astfel, transmiterea (45). Pisicile domestice și sălbatice pot să acționeze ca un rezervor uman, transmițând, ulterior, virusul ființelor umane (46). Deși cazurile de contaminare a pisicilor de către oameni sunt sporadice, constituirea unui rezervor de virus la pisicile nomade este posibilă din cauza contactului acestora cu fauna sălbatică și a sensibilității felinelor la diferite variante de SARS-CoV-2, aspecte care încă sunt puțin studiate (34)
Câinele ( Canis familiaris ). Sunt mai multe rapoarte care descriu îmbolnăviri la câini de companie. În Hong Kong, SARS-CoV-2 a fost izolat, din tampoane nazale și orale, la 2 din 15 câini, din gospodării cu cazuri umane confirmate cu COVID-19, iar prin examen serologic s-au evidențiat, la ambii câini, anticorpi prin test de neutralizare în placă (plaque-reduction-neutralization-tests/PRNT). Se arată că secvențele genetice virale ale virusurilor de la cei doi câini au fost identice cu cele ale virusului detectat la cazurile umane respective, confirmând, astfel, transmiterea de la om la câini. Virusul a fost izolat în cultură pe celule VeroE6, după un pasaj orb la 6 zile (47). Un alt caz este raportat în Franța, la un câine de 13 ani, ce trăia în contact strâns cu proprietarii, diagnosticați cu COVID-19; de la câine (clinic prezenta rinită) s-au prelevat tampoane nazale ce au fost analizate prin RT-qPCR (qantitative Polymerase Chain Reaction), rezultatul fiind pozitiv. În ser, s-au evidențiat anticorpi specifici prin test ELISA (Enzyme-linked immunosorbent assay) și Western Blot, care au persistat cel puțin 5 luni. Secvențele întregului genom de la câine și de la proprietarii săi au fost identice 99-100% și au corespuns variantei B.1.160 (varianta Marsilia) cea mai răspândită în Franța (48)
Transmiterea de la om la câine a fost demonstrată și în alte cazuri, cu varianta B.1.625 a SARS-
CoV-2 (27). Câinii par să aibă o susceptibilitate limitată la SARS-CoV-2 (16) .
Într-un sondaj efectuat pe câini și pisici domestice (13 câini și 34 pisici), aparținătoare unor pacienți confirmați pozitiv cu COVID-19, s-a constatat o sero-prevalență ridicată a anticorpilor SARS-CoV-2, variind de la 21% până la 53%, în funcție de criteriile de pozitivitate alese; se precizează că sero-pozitivitatea a fost semnificativ mai ridicată în rândul animalelor de companie din gospodăriile pozitive la COVID-19, comparativ cu cele a căror proprietari au statut necunoscut (toate animalele erau clinic sănătoase în momentul recoltării de probe) (49) . Într-un studiu efectuat în Brazilia, pe 39 animale de companie (29 câini și 10 pisici) din gospodării infectate sau seropozitive pentru SARS-CoV-2, se evidențiază că 9 câini (31%) și 4 pisici (40%) au fost infectate cu SARS-CoV-2 sau seropozitive, fiind identificați anticorpi neutralizanți la un câine (3,4%) și la două pisici (20%), unele animale prezentând semne ușoare, dar reversibile (50). Un alt studiu brazilian, pe 96 animale (46 pisici și 40 câini), unele dintre acestea fiind fără stăpân, de la care s-au recoltat probe orofaringiene, rectale și probe de ser, arată că toate probele recoltate pe tampoane au fost negative pentru ARN SARS-CoV-2, însă în probele de ser s-au evidențiat anticorpi neutralizanți la o pisică și un câine, din categoria animalelor fără stăpân, subliniindu-se că și acestea trebuie avute în atenție, fiind mai ușor expuse infecției (51)
Un studiu longitudinal asupra câinilor și pisicilor care au fost găzduite cu cel puțin un om infectat cu SARS-CoV-2 evidențiază că 47,1 % din 17 pisici și 15,3 % din 59 de câini, au fost pozitivi pentru SARS-CoV-2, prin RT-PCR, secvențierea genomului sau aveau anticorpi neutralizanți; se arată că majoritatea (82,4%) dintre animalele de companie infectate au fost asimptomatice (14)
O investigație făcută în Franța, pe 22 pisici și 11 câini, (proprietarii erau suspecți sau anterior infectați cu SARS-CoV-2), de la care s-au prelevat tampoane nazo-faringiene și rectale (examinate prin RT-qPCR) și probe de ser (examinate pentru prezența anticorpilor), a evidențiat rezultate negative la toți câinii; la o pisică ce a prezentat semne respiratorii și digestive ușoare, ca urmare a infecției naturale, s-au evidențiat anticorpi împotriva SARS-CoV-2 (52) .
Un sondaj serologic făcut în Marea Britanie pe 688 de seruri (454 canine și 234 feline), colectate în trei etape ale pandemiei, respectiv pre-COVID-19, în timpul primului val și în timpul celui de al 2-lea val, urmărindu-se detectarea anticorpilor neutralizanți anti SARS-CoV-2, se arată că s-au înregistrat rezultate pozitive la un număr redus de animale (4 câini și 2 pisici) și numai la probele
Vol VII - Nr. 37 (5) 2022 320
REVIEW
(review)
Susceptibility of domestic and wild animal species to SARS CoV-2 naturally infection
recoltate în cel de al doilea val de COVID-19 (53) Sub raportul dinamicii epidemice, se apreciază că, în mediul domestic, transmiterea virală este autolimitată, însă în mediile cu densitate populațională mare a animalelor se poate realiza o transmitere susținută între animale (16) .
Descrieri suplimentare ale animalelor de companie infectate natural cu SARS-CoV-2, ale managementului lor medical și ale diagnosticului ar putea fi utile pentru a îmbunătăți cunoștințele despre SARS-CoV-2 la animalele susceptibile (40)
INFECȚII NATURALE LA ALTE ANIMALE DE COMPANIE
Iepure ( Lepus domesticus ). Se raportează testarea unui număr de 144 iepuri de companie pentru anticorpi împotriva SARS-CoV-2, prin un test imunologic cu microsfere (MIA/microsphere immunoassay), înregistrându-se o seroprevalență scăzută între 0,7 și 1,4%, fiind primele dovezi ale unei infecții naturale cu SARS-CoV-2 la iepuri domestici (54) .
Dihor ( Mustela putorius furo). De la 127 dihori ținuți în gospodărie din Spania, s-au recoltat probe de ser pentru identificarea anticorpilor anti SARS-CoV-2, prin o metodă ELISA; se arată că doi dihori (1,57%) au fost testați pozitiv, la unul dintre aceștia, anticorpii anti-RBD (Receptor Binding Domain Spike protein) SARS-CoV-2 au persistat la niveluri decelabile până la 129 de zile (36)
Hamster sirian ( Mesocricetus auratus ). Un studiu de caz din Hong Kong menționează îmbolnăvirea unui lucrător al unui magazin de animale de companie. Se arată că opt (50%) din 16 hamsteri sirieni testați individual din magazinul respectiv și șapte (58%) din 12 hamsteri din depozitul corespunzător au fost pozitivi pentru infecția cu SARS-CoV-2 la testele RT-qPCR sau serologice. Se arată că genomurile găsite la cazurile umane și hamsteri aparțineau variantei Delta. Alte animale din focarul prezentat, respectiv hamsteri pitici, iepuri, cobai, chinchila și șoareci, nu au fost confirmați pozitiv pentru SARS-CoV-2, în urma testării prin RT-qPCR. Se concluzionează că hamsterii pot fi infectați în mod natural cu SARS-CoV-2 și pot transmite infecția la oameni (5)
INFECȚII NATURALE LA ANIMALE DE FERMĂ/CRESCĂTORIE
În literatura consultată sunt puține date care fac referiri la astfel de infecții naturale, cu toate că, aceste animale, în condițiile epidemiologice actuale, au putut ajunge la un contact strâns cu oameni afectați de COVID-19 atât în condiții de fermă, cât și în gospodării particulare.
Bovine. Un studiu s-a efectuat în Italia, într-o fermă de bovine în care, înainte de investiga -
ție, mai mulți muncitori au fost diagnosticați cu SARS-CoV-2. De la un număr de 24 vaci care alăptau sau prelevat probe pe tampoane nazale, rectale și probe de lapte (pentru detectare de ARN, SARS-CoV-2) și probe de ser (pentru detectare de anticorpi). Se arată că probele pentru detectare de ARN SARS-CoV-2, prin RT-qPCR au fost negative, în schimb s-au evidențiat diferite tipuri de anticorpi (11/24 anticorpi împotriva proteinei nucleocapsidale; 14/24 anticorpi împotriva proteinei spike, 13/24 anticorpi neutralizanți). Se mai precizează că toate probele au fost negative pentru Coronavirusul Bovin (BCoV) un alt Betacoronavirus, ce se întâlnește la bovine. Se consideră că rolul bovinelor în infecția și transmiterea SARS-CoV-2 pare a fi neglijabil (55). Cu toate acestea, se apreciază că bovinele posedă o cantitate sporită din enzima de conversie ACE2 (angiotensin-converting-enzyme 2), receptorul pentru SARS-CoV-2, inclusiv în glanda mamară, ceea ce ar explica această susceptibilitate și se consideră că bovinele ar putea îndeplini rolul de gazde intermediare (31) Ovine. Pentru a verifica susceptibilitatea oilor la infecția cu SARS-CoV-2, s-a efectuat un studiu pe 8 oi ce au fost provocate cu un amestec de tulpină originală SARS-CoV-2 și varianta alfa (B.1.1.7), pe cale nazală și orală, simultan. După o zi de la provocare, două oi naive, neinfectate, au fost amestecate cu oile infectate, pentru a se studia transmiterea virală, de la animal la animal. După o perioadă de 21 de zile de la provocare, se arată că nici unul din animale nu au dezvoltat febră sau alte manifestări clinice. Pentru a verifica prezența ARN viral și a virusului infecțios, s-au colectat probe nazale, orale și rectale atât de la animalele infectate, cât și de la contactele acestora. Se arată că ARN viral a fost detectat numai în probe nazale colectate de la oile infectate și nu în probele rectale. Virusul infecțios a fost absent în toate probele. Nu a fost detectat ARN viral sau virus infecțios în probele provenite de la cele două animale naive în timpul perioadei de studiu de 21 de zile. Se concluzionează că oile sunt puțin susceptibile la infecția cu SARSCoV-2 și dezvoltă doar o infecție subclinică, care poate fi transmisă altor oi amestecate, însă posibilitatea de a dezvolta o infecție secundară productivă este foarte scăzută (10)
Cabaline. Informațiile privind susceptibilitatea cabalinelor la infecția cu SARS-CoV-2 sunt limitate. Caii sunt aparent sensibili la infecția cu SARS-CoV-2 pe baza omologiei dintre receptorul ACE-2 uman și ecvin. Examinarea unui număr de 587 probe de sânge, provenite de la cai pursânge de curse, clinic sănătoși din California (SUA), a dus la constatarea că 35 (5,9%) aveau anticorpi detectabili la SARS-CoV-2; se
321 Vol VII - Nr. 37 (5) 2022

Romanian Journal of Veterinary Medicine & Pharmacology
S. Răpuntean, Ghe. Răpuntean
precizează că personalul de pistă testat prin qPCR a fost pozitiv pentru SARS-CoV-2 și ar reprezenta sursa infecției pentru cai (56). Este raportat cazul a doi cai, infectați cu SARS-CoV-2 de la o persoană diagnosticată cu COVID-19, varianta Delta, care a fost zilnic în contact cu cei doi cai atât înaint,e cât și în timpul dezvoltării bolii clinice. Se precizează că niciunul din cei doi cai nu au prezentat semne clinice. SARSCoV-2 nu a fost identificat prin RT-qPCR, prin analiza efectuată din sânge, secreția nazală sau fecale, însă unul din cai a prezentat seroconversie temporară, demonstrată prin ELISA și test de neutralizare în placă. Se concluzionează că specia cabalină se poate infecta cu SARS-CoV-2, fiind gazde accidentale și pot exprima o infecție tăcută în urma unui contact strâns cu oameni infectați (57)(56) .
Porcii. Nu sunt raportate cazuri de infecții naturale. Determinarea susceptibilității porcilor la SARS-CoV-2 este esențială, mai ales că organele de la porcii sunt folosite pentru xenotransplanturi (58)
Nurci. Nurcile de crescătorie sunt foarte sensibile la infecția cu SARS-CoV-2 și, în unele cazuri, au transmis virusul înapoi la oameni, considerându-se că acest fenomen ar putea avea implicații importante pentru sănătatea publică (6). În iunie-noiembrie 2020, nurcile infectate cu SARS-CoV-2 au fost identificate în 290 din 1147 de ferme de nurci daneze și s-a precizat că 30% dintre persoanele găsite contacte la fermele de nurci au fost testate pozitiv la SARSCoV-2, îmbolnăvirile fiind asociate cu nurcile; se precizează că nurca de crescătorie constituie un potențial rezervor de virus (59). Este descrisă infecția cu SARS-CoV-2 în două ferme de nurci, infectate natural (Grecia), la care s-au înregistrat și manifestări clinice, respectiv anorexie, depresie ușoară, până la semne respiratorii de intensitate diferită, cu evidențierea la examenul histologic de leziuni de bronhopneumonie interstițială și vasculită, induse de SARS-CoV-2. La examinarea a două nurci, un mascul și o femelă, prin tehnici de biologie moleculară, s-a evidențiat o încărcătură virală mai mare în organele masculului, comparativ cu femela. Se precizează că cel puțin la una din crescătorii fermierii infectați au fost responsabili pentru infecția nurcilor, transmiterea de la om la nurcă fiind foarte eficientă, respectiv la 229 din 1.000 de nurci manipulate în faza inițială, menționându-se, de asemenea, răspândirea masivă a virusului printre nurci, din cauza transmiterii prin aer (60) . Prin infecții naturale, a devenit evident că nurcile americane ( Neovision vison ) din fermele de blană (din Țările de Jos și Danemarca) sunt foarte sensibile la infecția cu SARS-CoV-2 (18) .
În urma transmiterii rapide a SARS-CoV-2 în cadrul populației de nurci, a apărut o nouă variantă SARS-CoV-2 asociată nurcii, care a fost identificată atât la oameni, cât și la nurci (46). Se consideră ca eforturile de supraveghere ar trebui să se concentreze, în principal, pe mustelide (nurci, dihori și altele) pentru detectarea precoce a infecției (61)
INFECȚII NATURALE LA ANIMALE CAPTIVE (GRĂDINI ZOOLOGICE, REZERVAȚII)
În luna septembrie 2021, la un număr de 12 animale, întreținute în o grădină zoologică din Chicago (SUA), au fost observate îmbolnăviri cu semne clinice variabile, la care s-a detectat varianta Delta a SARS-CoV-2, în probe de fecale și tampoane nazale, prin qRT-PCR, fiind prima detectare la animale din familiile Procyonidae și Viverridae ; se arată că șase specii de animale diferite erau infectate, virusul fiind identificat la trei specii noi, respectiv Prionailurus viverrinus, Arctictis binturong și Nasua nasua și se sugerează potențiale evenimente de transmitere de la om la animale (1). Infecția la coati ( Nasua nasua ) cu COVID-19, a fost raportată și la un exemplar din grădina zoologică din Ilinois (SUA), confirmat de NVSL (The National Veterinary Services Laboratories) (22)
Este menționată îmbolnăvirea a patru tigrii și trei lei de la grădina zoologică din Bronx (New York, SUA), care au dezvoltat semne respiratorii ușoare, anormale, fiind detectat ARN SARSCoV-2 în secrețiile respiratorii și/sau fecale la toate cele 7 animale; se arată că tigrii și leii au fost infectați cu genomuri diferite, datele epidemiologice și genomice au indicat transmiterea de la om la tigru (17)
Infecția cu SARS-CoV-2 a fost confirmată la trei gorile ( Gorilla gorilla ), din Zoo Park Safari, San Diego California (SUA), infecția fiind câștigată de la personalul asimptomatic infectat cu COVID-19 (23)(62) .
Într-o unitate din Texas (SUA) care expunea animale sălbatice, s-a constatat tuse și respirație dificilă la unii indivizi. În urma testării pentru infecția cu SARS-CoV-2, s-a obținut rezultat pozitiv la o pumă (Puma concalor) și un tigru ( Panthera tigris ) și se menționează că animalele au contractat virusul de la un lucrător care a fost testat pozitiv pentru COVID-19 (63). Infecția este raportată la trei leoparzi de zăpadă ( Pantera uncia ) la o grădină zoologică din Kentuky (SUA), evidențiindu-se prin secvențierea tulpinii SARS-Co-2, filiații corelate cu tulpinile umane; unul din leoparzi a eliminat virusul prin fecale până la 4 săptămâni (64). La grădina zoologică din Pennsilvania (SUA), la un râs de Canada ( Lynx canadensis ) care, clinic, a prezentat tuse
Vol VII - Nr. 37 (5) 2022 322
REVIEW
Susceptibility of domestic and wild animal species to SARS CoV-2 naturally infection (review)
și stare de letargie, infecția cu SARS-CoV-2 a fost confirmată în Statele Unite ale Americii (SUA) de către NVSL (65). La o grădină zoologică din Colorado (SUA), s-au îmbolnăvit mai multe animale, infecția cu SARS-CoV-2 fiind confirmată la două hiene pătate ( Crocuta crocuta) , 11 lei și 2 tigrii, confirmarea fiind făcută de NVSL (23)(66)
La un acvariu din Georgia, Statele Unite ale Americii, infecția este raportată la vidrele asiatice (Aonyx cinereus), probele fiind prelevate de la animale care au prezentat și manifestări clinice (strănut, secreții nazale, tuse, letargie ușoară), infecția cu SARS-CoV-2 fiind confirmată de NVSL; se menționează că vidrele au dobândit infecția de un îngrijitor de animale, asimptomatic (67) Infecția a fost raportată și la doi hipopotami (Hippopotamus amphibius) aparținând grădinii zoologice din Belgia care, din punct de vedere clinic, au prezentat scurgeri nazale, ambii fiind testați pozitiv pentru coronavirus, dar nu s-a putut stabili cum s-au infectat cu varianta Beta (68)
O altă cercetare raportează infecția cu SARSCoV-2, varianta Delta, la trei lei asiatici (Panthera leo ) în două locații diferite și se apreciază ca interesant faptul că nici o altă felină închisă în grădina zoologică nu a fost afectată (69) .
INFECȚII NATURALE LA DIFERITE SPECII DE ANIMALE SĂLBATICE
OIE a elaborat linii directoare pentru persoanele angajate în activitățile cu animale sălbatice pe teren pentru a minimiza riscul de transmitere a SARS-CoV-2 (6)
Cerb cu coada albă ( Odocoileus virginianus ). Conform mai multor rapoarte, această specie este considerată ca foarte susceptibilă la infecția cu SARS-CoV-2. S-a demonstrat că un exemplar din această specie, infectată intranazal cu SARS-CoV-2, a transmis virusul la căprioare de contact neinoculate, ARN-ul viral fiind detectat în mai multe țesuturi la 21 zile după infecție; toate animalele inoculate și de contact indirect au realizat seroconversie, dezvoltând anticorpi neutralizanți încă din ziua a 7-a. Se mai subliniază că enzima de conversie a angiotensinei 2 (ACE2/receptorul SARS-CoV-2) are un nivel ridicat de conservare și prezintă un grad ridicat de similitudine cu oamenii, ceea ce ar explica susceptibilitatea ridicată la infecție a acestor animale (70). La această specie de animale, s-a identificat o linie nouă și foarte divergentă de SARS-CoV-2 și s-a demonstrat transmiterea de la cerb la om (71). O cercetare efectuată pe 131 probe prelevate de la cerbi cu coada albă (Staten Island, New York, SUA) evidențiază prezența de anticorpi neutralizanți la 19 (14,5%), iar din tampoane nazale se identifică acidul nucleic SARS-CoV-2 la 7 din 68 (10,29%). Un singur
Vol VII - Nr. 37 (5) 2022
cerb a fost pozitiv pentru ARN viral și a avut un nivel ridicat de anticorpi neutralizanți. Analizele genetice au dezvăluit secvențe ale variantei Omicron, identificate și la oameni infectați. Se consideră că virusul se transmite de la oameni la căprioarele care trăiesc liber (72). În America de Nord, cerbul cu coada albă ar putea constitui un rezervor animal al SARS-CoV-2, iar în Pennsylvania (SUA), unde populația de căprioare cu coada albă este cea mai densă, varianta Alfa a circulat simultan cu varianta Delta (34)
Caprioara catâr/Mule deer ( Odocoileus hemionus ). Se descrie infecția cu SARS-CoV-2, varianta Delta, la două căprioare care aveau anticorpi în sânge, din care una elimina activ virusul, infecția fiind confirmată din o probă de tampon nazal; nu s-a putut clarifica cum au fost expuse animalele la această variantă virală (73) .
Rumegătoare sălbatice. O cercetare serologică efectuată în Germania a analizat, prin o metodă ELISA, 493 probe recoltate în perioada 2021-2022, provenite de la următoarele specii: cerb lopătar, cerb roșu, căprior, muflon și bizon european, urmărind depistarea anticorpilor anti SARS-CoV-2 și a altor patru virusuri ce afectează aceste rumegătoare. Folosind un test ELISA bazat pe domeniul de legare BDR, pe probe recoltate în 2021/2022, se arată că 25 din cele 493 (5,1%) au fost pozitive pentru SARS-CoV-2, însă acestea nu au fost confirmate prin test de neutralizare foarte specific. Se consideră că sero-reactivitatea SARS-CoV-2 a fost cel mai probabil indusă de un alt virus al cerbului, necunoscut până acum, aparținând subgenului Sarbecovirus din grupa Betacoronavirus (74)
Vidra eurasiatică ( Lutra lutra ). Virusul a fost detectat la o vidră care trăia în apropierea unui rezervor de apă din Spania. ARN-ul viral extras din tampon nazofaringian, țesut pulmonar și omogenizat de limfonoduli mediastinali și analizat prin RT-qPCR, a fost pozitiv pentru SARSCoV-2. Se subliniază necesitatea supravegherii mustelidelor sălbatice pentru a evalua riscul ca aceste animale să devină rezervoare de SARSCoV-2 (19)
Nurca ( Neovision vison). Este raportată infecția cu SARS-CoV-2 la două nurci sălbatice americane, cu detectarea de ARN viral în probe de limfonodulii mezenterici, prin RT-PCR, nurcile respective neavând nici o legătură cu fermele de nurci infectate, fiind primul exemplu de animal sălbatic detectat cu SARS-CoV-2 (75)
Armandillo ( Chaetophractus villosus ). Este menționată detectarea variantei Gamma a SARS CoV-2 la 4 exemplare din specia menționată în Argentina; se arată că, pe lângă descoperirea unei specii noi de faună sălbatică sensibilă la infecția cu SARS CoV-2, se aduce în atenție

Romanian Journal of Veterinary Medicine & Pharmacology
323
S. Răpuntean, Ghe. Răpuntean
problema potențialelor rezervoare virale neidentificate (21) .
Antillean manatees ( Trichechus manatus manatus ). Probe provenite de la 19 lamantini din Antile (ca origine a speciei) au fost analizate prin RT-PCR și RT-LAMP-PCR și s-a constatat că la doi dintre aceștia s-au obținut reacții pozitive pentru SARS-CoV-2 (9). Se subliniază, în acest contex, suceptibilitatea la virus a mamiferelor marine. Cercetările au fost efectuate de un institut din Brazilia. În Antile, se dorește protejarea speciei pentru o eventuală reintroducere în apele braziliene, Antillean manatees fiind considerată o specie pe cale de dispariție (supravegherea acestor mamifere este în sarcina institutului de cercetări din Brazilia).
Furnicar uriaș ( Myrmecophaga tridactyla ). Exemplar găsit rănit este testat prin RT-PCR, fiind identificat acidul nucleic SARS-CoV-2, fără a se putea identifica sursa infecției (3)
Marmosetă ( Mico melanurus ). Este raportat cazul unei femele adulte de maimuță cu coada neagră (zona urbană Cuiabá, Brazilia), găsită după o coliziune cu un autovehicul, infecția cu SARS-Co-2 fiind confirmată prin detectarea de ARN viral din tampoane nazo- și orofaringiene, ca și din ficat, dar și prin test imunohistochimic din mai multe organe, fiind identificat inclusiv antigenul proteinei spike în țesutul pulmonar; se subliniază că speciile de platyrrhine (maimuțe din lumea nouă/New World monkey) ar trebui incluse ca gazde potențiale ale infecției naturale cu SARS-Co-2 (2)
Leopard ( Panthera pardus fusca ). Cazul a fost depistat în India, în timpul screening-ului de rutină la un leopard sălbatic, la care s-a constatat histologic pneumonie interstițială. Genomul viral cu SARS-CoV-2 a putut fi detectat în diferite organe (creier, pulmon, splină și limfonoduli) prin RT-PCR, iar secvențierea întergului genom a confirmat infecția cu lineajul Pango B.1.617.2, varianta Delta. Se menționează omologia înaltă a secvenței de nucleotide găsite, cu virusurile predominante la om, și se sugerează o propagare a infecție la animal. Se subliniază necesitatea unui screening intensiv al animalelor sălbatice pentru a se urmări evoluția virusului și dezvoltarea stării de purtător al SARS-CoV-2 în rândul speciilor sălbatice (76)
Șobolan ( Rhatus norvegicus ). De la șobolani norvegieni care trăiesc în sistemul de canalizare din Anvers (Belgia), s-au colectat probe pe tampoane orale, fecale și țesuturi, care au fost testate prin RT-qPCR pentru prezența ARN SARS-CoV-2, fiind negative, iar probele de ser analizate prin un test imunologic cu microsfere Luminex (cele considerate pozitive au fost verificate pentru anticorpi neutralizanți utilizând
un test convențional de neutralizare virală) au fost, de asemenea, negative; s-a concluzionat că eșantionul de șobolani analizat nu a fost niciodată infectat cu SARS- CoV-2, dar se recomandă continuarea monitorizării din cauza apariției de noi variante predispuse să infecteze rozătoarele din familia Muridae (11)
Un alt studiu efectuat pe șobolani norvegieni (Ontario, Canada) arată că ARN SARS-CoV-2 nu a fost detectat în nicio probă din 224 examinate, însă la două din 11 s-au identificat anticorpi neutralizanți prin test de seroneutralizare în placă și recomandă includerea supravegherii șobolanilor și a altor specii relevante de animale sălbatice, deoarece variante noi continuă să apară (77)
INVESTIGAȚII PE SPECII DE INSECTE
Insecte individuale din familiile Diptera și Blattodea , în număr de 1345, separate în 243 grupuri, colectate din capcane lipicioase și capcane lichide, din 40 case de locuit (Texas, SUA), unde cel puțin un caz uman a fost testat pozitiv pentru SARS-CoV-2, au fost analizate prin RT-qPCR pentru identificarea ARN SARSCoV-2. Toate probele obținute de la grupele de insecte (omogenizate) au fost negative. Se consideră puțin probabil ca aceste insecte să contribuie la transmiterea mecanică a virusului SARS-CoV-2 (78)
APRECIERI PRIVIND METODELE DE DIAGNOSTIC
Probele pentru efectuarea analizelor de laborator, de regulă, includ: de la animale în viață tampoane nazale, orofaringiene și rectale, probe de sânge, iar în cazul cadavrelor se prelevează și probe din organele interne (plămâni, limfonoduli mediastinali, splină, ficat). În funcție de dotarea existentă, se pot efectua: examen electronomicroscopic, cultivarea pe culturi celulare, teste de biologie moleculară (RT-qPCR), RT-PCR și RT-LAMP-PCR (9) metode de secvențiere a ARN, examene serologice pentru decelarea anticorpilor: ELISA (diferite variante), Western blot, seroneutralizare, test imunologic cu microsfere Luminex (11)(54) electrochimioluminiscență (40), test imunohistochimic (2). Deși testele umane ar putea funcționa pe animale, medicii veterinari preferă teste specifice speciilor de animale și, în acest sens, mai multe laboratoare au dezvoltat teste SARS-CoV-2 pentru animale (79). Este menționată o metodă bazată pe bioinformatică care prezice susceptibilitatea la infecția cu SARS-CoV-2 la animalele domestice și sălbatice, respectiv omologia receptorului ACE2 de intrare în celula gazdă virală, metoda putând fi utilizată ca instrument screening pentru ghidarea testării pentru ARN viral (30). A fost dezvoltat un sistem
Vol VII - Nr. 37 (5) 2022 324
REVIEW
(review)
Susceptibility of domestic and wild animal species to SARS CoV-2 naturally infection
ELISA indirect, bazat pe domeniul de legare a receptorilor RBD. Testul este versatil și fiabil, permițând detectarea de anticorpi într-o gamă largă de specii de animale, fiind validat pe 59 seruri provenite de la animale infectate sau vaccinate și 220 seruri negative, incluzând dihori, ratoni, hamsteri, iepuri, găini, vite și o pisică (13). WADDL (Washington Animal Disease Diagnostic Laboratory) a anunțat că a dezvoltat un test COVID-19 pentru animale, care este similar testului la om, ce folosește PCR pentru amplificarea ARN-ului viral (79). Este menționată o tehnică ELISA cu dublu antigen (kit format) pentru detectarea de anticorpi direcționați împotriva nucleocapsidei SARS-CoV-2 din ser, plasmă sau sânge integral al animalului. Acest test poate fi utilizat pe probe individuale provenite de la nurci, dihori, pisici, câini, vite, oi, capre, cai, și alte specii sensibile (80). În Coreea de Sud se depun eforturi pentru a reduce răspândirea COVID-19 în rândul populației de animale de companie și se oferă teste pentru câini și pisici. Introducerea testelor la animale trebuie să țină seama de situația epidemiologică - atât la om, cât și la animale - și trebuie să se lucreze cu oficialii veterinari pentru a dezvolta un plan pentru testarea animalelor de companie (79). Testarea de rutină a animalelor nu este recomandată, întrucât riscul ca animalele să răspândească virusul la oameni este considerat a fi scăzut (22) (33). Rezultatul investigațiilor de laborator și epidemiologice de teren pot oferi dovezi pentru a evalua mai bine implicațiile infecțiilor umane cu SARS-CoV-2 pentru sănătatea și bunăstarea animalelor, sănătatea publică veterinară și conservarea faunei sălbatice (33)
APRECIERI PRIVIND VACCINAREA
LA ANIMALE
Compania Zoetis din Statele Unite ale Americii a produs un vaccin inactivat pentru animale, fiind folosit de multiple grădini zoologice la animale din multe specii: maimuțe mari (great apes), tigri, gheparzi, leoparzi de zăpadă, lei de munte (puma/cougar), dihori, urși negri și grizli. La o grădina zoologică din Canada, s-a folosit vaccin Zoetis la 150 de animale, incluzând primate, feline mari, porci, lilieci și mustelide. Un studiu experimental de vaccinare a fost efectuat la pisici tinere folosind un vaccin SARS-CoV-2 pe bază de subunități de proteine spike. Cele două formule de vaccin cu adjuvant au protejat pisicile tinere împotriva eliminării virusului din tractul respirator superior și a replicării virale în căile respiratorii inferioare și a inimii. În Suedia, a fost produs Furovac vaccine, folosit la imunizarea nurcilor din ferme (4). Serviciul Federal de Supraveghere Veterinară și Fitosanitară din Rusia
a dezvoltat un vaccin inactivat prin mijloace chimice, căldură și radiații (Carnivac-Cov), cu recomandare pentru pisici, câini, nurci și vulpi; după inoculare, determină răspuns imun umoral și mediat celular, imunitatea instalată durează cel puțin 6 luni și se apreciază că vaccinul nu numai că va proteja animalele de infecție, dar poate ajuta și la prevenirea transmiterii mutantelor virale (81). Vaccinarea animalelor domestice poate preveni posibila introducere a SARS-CoV-2 în populația sălbatică și transmiterea ulterioară la fauna sălbatică (8)
CONCLUZII, RECOMANDĂRI
Infecțiile cu SARS-CoV-2 care apar în mod natural la animale par neobișnuite și se presupune, în majoritatea cazurilor, că infecția s-a produs prin contactul apropiat sau strâns cu persoane diagnosticate cu COVID-19.
Dintre animalele de companie, infecții naturale sunt descrise mai frecvent la pisici (foarte susceptibile) și câini, și mai rar alte animale (iepuri, dihori, hamsteri).
Dintre animalele de fermă/crescătorie, infecții naturale sunt raportate la bovine (vaci lactante) cabaline și ovine, dar se consideră că rolul lor în transmiterea SARS-CoV-2 este redus; o semnificație deosebită o au nurcile, care sunt foarte sensibile, infecția transmițându-se de la om la nurci, dar și între nurci.

În cazul animalelor din grădini zoologice, infecția naturală cu SARS-CoV-2 a fost raportată la mai multe specii de feline (tigrii, lei, pume, râs, pisica pescar), binturong/bearcat, hiene, gorile, coati/nasua, vidre, hipopotami.
La animale ce trăiesc în sălbăticie, infecții au fost raportate la specii foarte diferite, din care sunt menționte următoarele: nurci, vidre, armandillo, lamantini, furnicari, marmosete, leoparzi și specii de cervidee (cerb cu coada albă și căprioara catâr).
Prezența infecției clinice sau asimptomatice s-a stabilit cel mai frecvent prin teste de biologie moleculară pentru evidențierea unor structuri virale și/sau decelarea anticorpilor specifici prin teste imunologice.
Pe baza informațiilor disponibile, riscul ca animalele să răspândească virusul la oameni este considerat a fi scăzut, exceptând nurcile.
Persoanele cu COVID-19, suspecte sau confirmate, trebuie să evite contactul strâns cu animalele de companie, de fermă, captive și sălbatice, pentru a le proteja de o posibilă infecție (22) (50) (27)(6)(20) .
Proprietarii nu ar trebui să-și abandoneze animalele de companie sau să le compromită bunăstarea în caz de suspectare sau infectare cu SARS-CoV-2 (52) .
Vol VII - Nr. 37 (5) 2022
Romanian Journal of Veterinary Medicine & Pharmacology
325
S. Răpuntean, Ghe. Răpuntean
Susceptibility of domestic and wild animal species to SARS CoV-2 naturally infection
Se recomandă o supraveghere cuprinzătoare a speciilor de animale sensibile (domestice și sălbatice) pentru a identifica rețelele ecologice de transmitere (72)
Ținerea animalelor de companie departe de animalele sălbatice este o altă recomandare importantă (73)
Măsuri generale de igienă ar trebui luate când se vizitează piețe unde se vând animale vii, carne crudă sau produse de origine animală (6) .
Pentru anumite exploatații de animale (ex. nurci) și grădini zoologice, vaccinarea ar constitui o metodă de prevenire eficace (81)
Colaborarea strânsă între autoritățile de sănătate animală și cea publică, conform con -
Bibliografie
1. Allender M.C., Adkesson M.J., Langan J.N., Delk K.W., Meehan T., AitkenPalmer C., McEntire M.M., Killian M.L., Torchetti M., Morales S.A., Austin C., Fredrickson R., Olmstead C., Ke R., Smith R., Hostnik E.T., Terio K., Wang L., (2022) Multi-species outbreak of SARS-CoV-2 Delta variant in a zoological institution, with the detection in two new families of carnivores. Transbound. Emerg. Dis., 10.1111/tbed.14662. doi: 10.1111/tbed.14662.
2. Pereira A.H.B., Vasconcelos A.L., Silva V.L.B., Nogueira B.S., Silva A.C.P., Pacheco R.C., Souza M.A., Colodel E.M., Ubiali D.G., Biondo A.W., Nakazato L., Dutra V., (2022) Natural SARS-CoV-2 Infection in a Free-Ranging Black-Tailed Marmoset (Mico melanurus) from an Urban Area in Mid-West Brazil. J. Comp. Pathol., 194: 22–27.
3. SARS CoV-2 IN ANIMALS – Situation REPORT 12. Update (01/04/2022 – 30/04/2022). www.woah.org/app/uploads/2022/05/sars-cov-2-situationreport-12.pdf
4. SARS-CoV-2 in animals situation update (7 sept. 2022). www.fao.org/ animal-healthy/situation-updates/sars-cov-2-in-animals/en
5. Yen H-L, Sit T.H.C., Brackman C.J., Chuk S.S.Y., Gu H., Tam K.W.S., Law P.Y.T., Leung G.M., Peiris M., Poon L.L.M., H.K.U-S.P.H., (2022) Transmission of SARSCoV-2 delta variant (AY.127) from pet hamsters to humans, leading to onward human-to-human transmission: a case study. Lancet. 399(10329):1070-1078. doi: 10.1016/S0140-6736(22)00326-9.
6. OIE. What are implication of animal infections with SARS-CoV-2? https:// www.woah.org/fileadmin/Home/eng/Our_scientific_expertise/docs/pdf/COV19/A_Factsheet_SARS-CoV-2.pdf
7. World Organization for Animal Health. Questions and Answers on COVID-19 (last updated: 27/11/2020). Available at: https://www.oie.int/scientificexpertise/specific-information-and-recommendations/questions-and-answerson-2019novel-coronavirus/
8. Sharunc K., Tiwari R., Saied Abdul Rahman A., Dhama K., (2021) SARS-CoV-2 vaccine for domestic and captive animals: An effort to counter COVID-19 pandemic at the human-animal interface. Vaccine, 39(49): 7119–7122. doi: 10.1016/j.vaccine.2021.10.053.
9. Melo F.L., Luna F.O., Barragan N.A.N., Arcoverde R.M.L., Umeed R., Lucchini K., Attademo F.L.N., (2022) Coronavirus (SARS-CoV-2) in Antillean Manatees (Trichechus Manatusmanatus). Research Square, p. 1-9. https://doi. org/10.21203/rs-1065379/v1
10. Dutta Sanchari Sinha (2021) Sheep at low-risk for infection with SARSCoV-2 www.news-medical.net/new/20211121/Sheep-at-low-risk-infectionwith-SARS-Co-2.aspx
11. Colombo V.C., Sluydts V., Marien J., Broecke B.V., Van Houtte N., Leirs W., Jacobs L., Iserbyt A., Hubert M., Heyndrickx L:, Goris H., Delputte P., De Roeck N., Elst J., Arien K.K., Leirs H., Gryseels S., (2021) SARS‐CoV‐2 surveillance in Norway rats (Rattus norvegicus) from Antwerp sewer system, Belgium. Transbound. Emerg. Dis., 10.1111/tbed.14219.
12. Bosco-Lauth A.M., Hartwig A.E., Porter S.M., Gordy P.W., Nehring M., Byas A.D., et al. Experimental infection of domestic dogs and cats with SARS-CoV-2: Pathogenesis, transmission, and response to reexposure in cats (2020).
Proceedings of the National Academy of Sciences of the United States of America. 117(42):26382–8. PMID: 32994343; PubMed Central PMCID: PMC7585007.
13. Wernike K., Aebischer A., Michelitsch A., Hoffmann D., Freuling C., Balkema-Buschmann A., Graaf A., Müller T., Osterrieder N., Rissmann M., Rubbenstroth D., Schön J., Schulz C., Trimpert J., Ulrich L., Volz A., Mettenleiter T., Beer M., (2020) Multi-species ELISA for detection of antibodies against SARS-CoV-2 in animals. Transb. Emerg. Dis., 68(4): 1779-1785. DOI: 10.1111.
ceptului One Health, este imperativă pentru a identifica și reduce cât mai bine impactul bolii atât asupra populație umane, cât și a populației de animale (6)
În consecință, orice caz de infecție a animalelor cu SARS-CoV-2 trebuie raportat prin intermediul WAHIS (World Animal Health Information System), în conformitate cu OIE Codul de sănătate pentru animale terestre (6)(33)
This work is licensed under a Creative Commons Attribution-NonCommercialNoDerivatives 4.0 International License.

tbed.13926.
14. Hamer S.A., Pauvolid-Correa A., Zecca I.B., Davila E., Auckland L.D., Roundy C.M.,Tang W., Torchetti M., Killian M.L., Jenkins-Moore M., Mozingo K., Akpalu Y., Ghai R.R., Spengler J.R., Behravesh C.B., Fischer R.S.B., Hamer G.J., (2020) Natural SARS-CoV-2 infections, including virus isolation, among serially tested cats and dogs in households with confirmed human COVID-19 cases in Texas, USA. bioRxiv. PMID: 33330861; PubMed Central PMCID: PMC7743065.
15. Tazerji S.S., Duarte P.M., Rahimi P., Shahabinejad F., Dhakai S., Malik Y.S., Shehata A.A., Lama J., Klein J., Safdar M., Rahman M.T., Filipiak K.J., Rodriguez-Morales A., Sobur M.A., Kabir F., Vazir B., Mboera L., Caporale M., Islam M.S., Amuasi J.H., Gharieb R., Roncada P., Musaad S., Tilocca B., Koohi M.K., Taghipour A., Sait A., Subbaram K., Jahandideh A., Mortazavi P., Abedini M.A., Hokey D.A., Hogan U., Shaheen M.N.F., Elaswad A., Elhaig M.M., Fawzy M., (2020) Transmission of severe acute respiratory syndrome coronavirus 2 (SARS-CoV-2) to animals: an updated review. J. Transl. Med., 18(1): 358. DOI: 10.1186/s12967-020-02534-2.
16. Hobbs E.C., Reid T.J., (2021) Animals and SARS-CoV-2: Species susceptibility and viral transmission in experimental and natural conditions, and the potential implications for community transmission. Transbound. Emerg. Dis., 68: 1850-1867. DOI: 10.1111/tbed.13885.
17. McAloose D., Laverack M., Wang L., Killian M.L., Caserta L.C., Yuan F., Mirchell P.K., Quinn K., Mauldin M.R., Cronk B.D., Bartlett L.S., Sykes J.M., Ze S., Stokol T., Ingerman K., Delaney M.A., Frederickson R., Ivancic M., JenkindMoore M., Mozingo K., Franzen K., Bergeson N.H., Goodman L., Wang H., Fang Y., Olmstead C., McCann C., Thomas P., Goodrich E., Elvinger F., Smith D.C., Tong S., Slavinski S., Calle P.P., Terio K., Torketti M.K., Diel D.G., (2020) From People to Panthera: Natural SARS-CoV-2 Infection in Tigers and Lions at the Bronx Zoo. mBio, 11(5): e02220-20. doi: 10.1128/mBio.02220-20.
18. Michelitsch A., Wernike K., Ulrich L., Mettenleiter T.C., Beer M., (2021) SARSCoV-2 in animals: From potential hosts to animal models. Adv. Virus. Res., 110: 59-102. doi: 10.1016/bs.aivir.2021.03.004.
19. Padilla-Blanco M., Aguilo-Gisbert J., Rubio V., Lizana V., Chillida-Martinez E., Cardells J., Maiques E., Rubio-Guerri C., (2022) The Finding of the Severe Acute Respiratory Syndrome Coronavirus (SARS-CoV-2) in a Wild Eurasian River Otter (Lutra lutra) Highlights the Need for Viral Surveillance in Wild Mustelids. Front Vet. Sci., 9: 826991. Doi: 10.3389/fvets 2022.826991
20. Animals and COVID-19, 5 july, 2022. https://www.cdc.gov/coronavirus/2019ncov/daily-life-coping/animals.html
21. Arteaga F.L., Jodar M.N., Mondino M., Portu A., Boeris M., Joly A., Jar A., Mundo S., Castro E., Alvarez D., Torres C., Viegas M., Bratanich A., (2022) An outbreak of SARS-CoV-2 in big hairy armadillos (Chaetophractus villosus) associated with Gamma variant in Argentina three months after being undetectable in humans. BioRxiv. https://doi.org/10.1101/2022.0823.503528
22. Bady Maquita (2021) Confirmation of COVID-19 in a Coatimundi at an Ilinois Zoo. https://www.aphis.usda.gov/aphis/ourfocus/animalheath/sa_one_health/ sars-cov-2animals-us
23. Dali Natasa (2021) Hippos, hyenas and other animals are contracting COVID-19. www.nationalgeographic.com/animals
24. Woo Patrick C.Y., Huang Y., Lau S.K.P, Yuen K-Y., (2010) Coronvirus Genomics and Bioinformatic Analysis. Viruses, 2(8): 1804-1820. doi:10.3390/v2081803
25. Perlman S., Natland J., (2009) Review. Coronaviruses post-SARS; update on replication and pathogenesis. Nature Reviews Microbiology, 7: 439-450. doi: 10.1038/nrmicro2147
26. Shi J., Wen Z., Zhong G., Yang H., Wang C., Huang B., Liu R., He X., Shuai L., Sun Z., Zhao Y., Liu P., Liang L., Cui P., Wang J., Zhang X., Guan Y., Tan W.,
326
Vol VII - Nr. 37 (5) 2022
REVIEW
(review)
Bibliografie
Wu G., Chen H., Bu Z., (2020) Susceptibility of ferrets, cats, dogs, and other domesticated animals to SARS-coronavirus 2. Science, 368(6494):1016–1020. PMID: 32269068; PubMed Central PMCID: PMC7164390. DOI: 10.1126/ science.abb7015
27. Rivero, R., Garay, E., Botero, Y., Serrano-Coll, H., Gastelbondo, B., Munoz M., Ballesteros N., Castaneda S., Patino L.H., Ramirez J.D., Calderon A., Guzman C., Martinez-Bravo C., Aleman A., Arrieta G., Mattar S., Mattar, S. (2022). Humanto-dog transmission of SARS-CoV-2, Colombia. Scientific reports, 12(1), 7880. https://doi.org/10.1038/s41598-022-11847-9
28. Woo Patrick C.Y., Lau S.K.P., Huang Yi, Yuen Knok-Yung (2009) Review, Coronavirus diversity, Phylogeny and Interspecies Jumping. Exp. Bio. Med., 234(10): 1117-1127. doi: 10.3181/0903-MR-94
29. CDC. https://www.cdc.gov/coronavirus/2019-ncov/your-health/aboutcovid-19/antibodies.html
30. Kumar A., Pandey S.N., Pareek V., Narayan R.K., Faiq M.A., Kumari C., (2021) Predicting susceptibility for SARS-CoV-2 infection in domestic and wildlife animals using ACE2 protein sequence homology. Zoo Biol., 40(1): 79–85. doi: 10.1002/zoo.21576
31. Luan J., Jin X., Lu Y., Zhang L., (2020) SARS-CoV-2 spike protein favors ACE2 from Bovidae and Cricetidae. J. Med. Virol., 92(9):1649-1656. doi: 10.1002/ jmv.25817
32. Interim Infection Prevention and Control Guidance for Veterinary Clinics Treating Companion Animals During the COVID-19 Response.www.cdc.gov/ coronavirus/2019-ncov/community/veterinarians.html
33. World Organisation for Animal Health (OIE) (2020). Considerations for sampling, testing, and reporting of SARS-CoV-2 in animals. https://www. woah.org/fileadmin/Home/MM/A_Sampling_Testing_and_Reporting_of_SARSCoV-2_in_animals_3_July_2020.pdf
34. Animal reservoir of SARS-CoV-2: a threat to humans? (2022). https://www. academie-medecine.fr/reservoir-animal-de-sars-cov-2-une-menace-pourlhomme/?lang=en
35. Musso N., Costantino A., La Spina S., Finocchiaro A., Andronico F., Stracquadanio S., Liotta L., Visalli R., Emmanuele G., (2020) New SARS-CoV-2 Infection Detected in an Italian Pet Cat by RT-qPCR from Deep Pharyngeal Swab. Pathogens, 9(9). PMID: 32932800; PubMed Central PMCID: PMC7559392.
36. Giner J., Villanueva-Saz S., Tobias A.P., Perez M.D., Gonzalez A., Verde M., Yzuel A.P., Garcia-Garcia A., Taleb V., Lira-Navarrete E., Hurtado-Guerreo R., Pardo J., Santiago L., Pano J.R., Ruiz H., Lacasta D., Fernandez A., (2021) SARSCoV-2 Seroprevalence in Household Domestic Ferrets (Mustela putorius furo). Animals (Basel), 11(3). doi: 10.3390/ani10330667
37. Patterson E.I., Elia G., Grassi A., Giordano A., Desario C., Medardo M., Smith S.L., Anderson E.R., Prince T., Patterson G.T., Lorusso E., Lucente M.S., Lanave G., Lauzi S., Bonfanti U., Stranieri A., Martella V., Solari Basano F., Barrs V.R., Radford A.D., Agrimi U., Hughes G.L., Paltrinieri S., Decaro N., (2020) Evidence of exposure to SARS-CoV-2 in cats and dogs from households in Italy. Nat. Commun. 11, 6231. https://doi.org/10.101038/s41467-020-20097-0
38. Murphy H.L., Ly H., (2021) Understanding the prevalence of SARS-CoV-2 (COVID-19) exposure in companion, captive, wild, and farmed animals (Review). Virulence. 12(1):2777-2786. doi: 10.1080/21505594.2021.1996519
39. Garigliany M., Van Laere A-S., Clercx C., Giet D., Escriou N., Huon C., van der Werf S., Eloit M., Desmecht D., (2020) SARS-CoV-2 Natural Transmission from Human to Cat, Belgium, March 2020. Case Reports. Emerg. Infect. Dis., 26(12): 3069-3071. doi: 10.3201/eid2612.202223.
40. Natale A., Mazzotta E., Mason N., Ceglie L., Mion M., Stefani A., Fincato A., Bonfante F., Bortolami A., Monne I., Bellinati L., Guadagno C., Quaranta E., Pastori A., Terregino C., (2021) SARS-Cov-2 Natural Infection in a Symptomatic Cat: Diagnostic, Clinical and Medical Management in a One Health Vision, 11(6): 1640. doi: 10.3390/ani11061640
41. Gaudreault N.N., Trujillo J.D., Carossino M., Meekins D.A., Morozov I., Madden D.W., Indran S.V., Bold D., Balaraman V., Kwon T., Artiaga B.L., Cool K., Garcia-Sastre A., Ma W., Wilson W.C., Henningson J., Balasuriya U.B.R., Richi J.A., (2020) SARS-CoV-2 infection, disease and transmission in domestic cats. Emerg. Microbes Infect., 9(1):2322–2332. PMID: 33028154; PubMed Central PMCID: PMC7594869.
42. Halfmann P.J., Hatta M., Chiba S., Maemura T., Fan S., Takeda M., Kinoshita N., Hattori S-I., Sakai-Tagawa Y., Iwatsuki-Horimoto K., Imai M., Kawaoka Y., (2020). Transmission of SARS-CoV-2 in Domestic Cats. N. Engl. J. Med., 383(6): 592–594. PMID: 32402157. DOI: 10.1056/NEJMc2013400.
43. Barrs Vanessa R., Peiris Malik., Tam Karina W.S., Law Pierra Y.T., Brackman Christopher J., To Esther M.W., Yu Veronica Y.T., Chu Daniel K.W., Perera Ranawaca A.P.M., Sit Thomas H.C., (2020). SARS-CoV-2 in Quarantined Domestic Cats from COVID-19 Households or Close Contacts, Hong Kong, China. Emerg. Infect. Dis., 26(12):3071–3074. PMID: 32938527; PubMed Central PMCID: PMC7706951.

44. Segales J., Puig M., Rodon J., Avila-Nieto C., Carrillo J., Cantero G., Terron M.T., Cruz S., Parera M., Noguera-Julian M., Izquierdo-Useros N., Guallar V., Vidal E., Valencia A., Blanco L., Cloted B., Vergara-Alert J., (2020) Case Reports. Detection of SARS-CoV-2 in a cat owned by a COVID-19-affected patient in Spain. Proc. Natl. Acad. Sci. USA., 117(40): 24790–24793. PMID: 32948692; PubMed Central PMCID: PMC7547282.
45. Carlos R.S.A., Mariano A.P.M., Maciel B.M., Gadelha S.R., de Melo Silva M., Belitardo E.M,M., Gil Rocha D.J.P., de Almeida J.P.P., Pacheco L.G.C., Rocha Aguiar E.R.G., Fehlberg H.F., Albukquerque G.R., (2021) First genome sequencing of SARS-CoV-2 recovered from an infected cat and its owner in Latin America. Transboundary and emerging diseases. 68(6): 3070-3074, PMID: 33421326.
46. Sharuna K., Dhama K., Pawde A.M., Gortazar C., Tiwari R., BonillaAldana D.K., Rodriguez-Morales A.J., de la Fuente J., Michalak I., Attila A.Y., (2021) SARS-CoV-2 in animals: potential for unknown reservoir hosts and public health implications. Review, Vet. Q., 41(1):181-201. doi: 10.1080/01652176.2021.192.1311
47. Sit Thomas H.C., Brackman Christopher J., Ip Sin M., Tam Karina W.S, Law Pierra Y.T., To Esther M.W., Yu Veronica Y.T., Sims Leslie D., Tsang Dominic N.C., Chu Daniel K.W., Perera Ranawaka A.P.M., Poon Leo L.M., Peiris M., (2020) Infection of dogs with SARS-CoV-2. Nature. 586(7831): 776–778. PMID: 32408337; PubMed Central PMCID: PMC7606701. DOI: 10.1038/s41586-020-2334-5
48. Medkour H., Catheland S., Boucraut-Baralon C., Laidoudi Y., Sereme Y., Pingret J-L., Million M., Houhamdi L., Levasseur A., Cabassu J., Davoust B., (2022) First evidence of human-to-dog transmission of SARS-CoV-2 B.1.160 variant in France. Transbound. Emerg. Dis., 69(4):e823-e830. doi: 10.1111/ tbed.14359
49. Fritz M., Rosolen B., Krafft E., Becquart P., Elguero E., Vrats O., Denolly S., Boson B., Vanhomwegen J., Ar Gouilh M., Kadjo A,m Chirouze C., RosolenG.S., Legros V., Leroy E.M., (2020) High prevalence of SARS-CoV-2 antibodies in pets from COVID-19+ households. One Health, 11: 100192
50. Calvet G.A., Pereira S.A., Ogrzewalska M., Pauvolid-Corrêa A., Resende P.C., Tassinari W.S., Costa A. P., Keidel L.O., da Rocha A.S.B., da Silva M.F.B., Dos Santos S.A., Lima A.B.M., de Moraes I.C.V., Mendes JuniorA.A.V., Souza T.C., Martins E.B., Ornellas R.O., Correa M.L., Antonio I.M.S., Isabela M.S., Guaraldo L., Motta F.C., Brasil P., Siqueira M.M., Gremiao I.D.F., Menezes R.C., (2021) Investigation of SARS-CoV-2 infection in dogs and cats of humans diagnosed with COVID-19 in Rio de Janeiro, Brazil. PLoS ONE 16(4): e0250853. https:// doi.org/10.1371/journal.pone.0250853
51. Dias H.G., Resck M.E.B., Caldas G.C., Resck A.F., da Silva N.V., dos Santos A.M.V., et al. (2021) Neutralizing antibodies for SARS-CoV-2 in stray animals from Rio de Janeiro, Brazil. PLoS ONE 16(3): e0248578. https://doi. org/10.1371/journal.pone.0248578
52. Sailleau C., Dumarest M., Vanhomwegen J., Delaplace M., Caro V., Kwasiborski A., Hourdel V., Chevallier P., Barbarino A., Comtet L., Pourquier P., Klonjkowski B., Manuguerra J-C., Zientara S.,(2020) Case Reports. First detection and genome sequencing of SARS-CoV-2 in an infected cat in France. Transbound. Emerg. Dis., 67(6):2324–2328. PMID: 32500944; PubMed Central PMCID: PMC7300955. Doi: 10.1111/tbed.13659
53. Smith S.L., Anderson E.R., Casando-Utrilla C., Prince T., Farrell S., Brant B., Smyth S., Noble P-J. M., Pinchbeak G.L., Marshall N., Roberts L., Hughes G.L., Radford A.D., Patterson E.I., (2021) SARS-CoV-2 neutralising antibodies in dogs and cats in the United Kingdom. Current Research in Virology Science, 2: 100011.
54. Fritz M., de Riols de Fonclare D., Garcia D., Beurlet S., Becquart P., Rosolen S.G., Briend-Marchal A., Leroy E.M., (2022) First evidence of natural SARS-CoV-2 infection in domestic rabbits. Vet. Sci., 9(2), 49. doi: 10.3390/ vetsci9020049
55. Fiorito, F., Iovane, V., Pagnini, U., Cerracchio, C., Brandi, S., Levante M., Marati L., Ferrara G., Tammaro V., De Carlo E., Iovane G., Fusco, G. (2022). First Description of Serological Evidence for SARS-CoV-2 in Lactating Cows. Animals (Basel), MDPI, 12(11), 1459. https://doi.org/10.3390/ani12111459
56. Lawton Kaila O.Y., Arthur R.M., Moeller B.C., Barnum S., Pusterla N., (2022) Investigation of the Role of Healthy and Sick Equids in the COVID-19 Pandemic through Serological and Molecular Testing. Animals (Basel),12(5):614.doi: 10.3390/ani12050614
57. Pusterla N., Chaillon A., Ignacio C., Smith D.M., Barnum S., Lawton K.O.Y., Smith G., Pickering B., (2022) SARS-CoV-2 Seroconversion in an Adult Horse with Direct Contact to a COVID-19 Individual. Viruses, 2022 May 14;14(5):1047. doi: 10.3390/v14051047
58. Tanja Opriessnig, Yao-Wei Huang (2021). Third update on possible animal sources for human COVID-19. Xenotransplantation. 2021;28:e12671. https:// doi.org/10.1111/xen.12671
59. Larsen H.D., Fonager J., Lomholt F.K., Dalby T., Benedetti G., Kristensen B., Urth T.R., Rasmussen M., Lassaunière R., Rasmussen T.B., Strandbygaard B., Lohse L., Chaine M., Møller K.L., Berthelsen A-S.N., Nørgaard S.K., Sönksen U.W., Boklund A.E., Hammer A.S., Belsham G.J., Krause T.G., Mortensen S., Bøtner A., Fomsgaard A., Mølbak K., (2021) Preliminary report of an outbreak of SARS-CoV-2 in mink and mink farmers associated with community spread, Denmark, June to November 2020. Euro Surveill, 26(5): 2100009. doi: 10.2807/1560-7917
60. Chaintoutis S.C., Thomou Z., Mouchtaropoulou E., Tsiolas G., Chassalevris T., Stylianaki I., Lagou M., Michailidou S., Moutou E., Johannes J., Koenen H., Dijkshoorn J. W., Paraskevis D., Poutahidis T., Siarkou V.I., Sypsa V., Argiriou A., Fortomaris P., Dovas C. I., (2021) Outbreaks of SARS-CoV-2 in naturally infected mink farms: Impact, transmission dynamics, genetic patterns, and environmental contamination, PLoS Pathog., 17(9):e1009883. doi: 10.1371/ journal.ppat.1009883
327 Vol VII - Nr. 37 (5) 2022
Romanian Journal of Veterinary Medicine & Pharmacology
S.
Răpuntean
Răpuntean, Ghe.
Bibliografie
61. Sharunb K., Saied A.R.A., Tiwari R., Dhama K., (2021) SARS-CoV-2 infection in domestic and feral cats: current evidence and implications. Vet Q., 41(1): 228-231. doi: 10.1080/ 01652176.2021.1962576

62. Confirmation of COVID-19 in Gorillas at a California Zoo. www.science.org/ content/article/captive-gorillas-positive-coronavirus
63. Captive cougar tests positive for coronavirus (2021). www.wildlife.org/ captive-cougar-tests-positive-for-coronavirus/
64. Wang, L., Gyimesi, Z. S., Killian, M. L., Torchetti, M., Olmstead, C., Fredrickson, R., Terio, K. A., (2022). Detection of SARS-CoV-2 clade B.1.2 in three snow leopards. Transbound. Emerg. Dis. doi.10.1111/tbed.14625
65. Confirmation of COVID-19 in a Canada Linx at a Pennsilvania Zoo (2021). www.aphis.usds.gov/aphis/newroom/stakeholder-info/
66. Confirmation of COVID-19 in Hyenas at a Colorado Zoo (2021). www.aphis. usda.gov/aphis/newsroom/stakeholder-info/sa-2021/sa-11/covid-hyenas
67. Confirmation of COVID-19 in Otters at an Aquarium in Georgia, 2021. www. aphis.usda.gov/aphis/newroom/stakeholder-info/sa_by_date/sa-/sa-04/covidgeorgia otters
68. Two hippos in Belgium zoo test positive for COVID-19 (2021). https:// www.reuters.com/world/europe/two-hippos-belgian-zoo-test-positivecovid-19-2021-12-04/
69. Karikalan M., Chander V., Mahajan S., Deol P., Agrawal R.K., Nandi S., Rai S.K., Mathur A., Pawde A., Singh K.P., Sharma G.K., (2021) Natural infection of Delta mutant of SARS-CoV-2 in Asiatic lions of India. Transbound. Emerg. Dis., 69(5): 3047-3055. doi: 10.1111/tbed.14290
70. Palmer V. M., Martins M., Falkenberg S., Buckley A., Caserta L.C., Mitchell P.K., Cassmann E.D., Rollins A., Zylich N. C., Renshaw R.W., Guarino C., Wagner B., Lager K., Diel G. D., Susceptibility of white-tailed deer (Odocoileus virginianus) to SARSCoV-2 (2021) J. Virol., 95(11):e00083-21. doi: 10.1128/JVI.00083-21
71. Pickering B., Lung O., Maguire F., Kruczkiewicz P., Kotwa J.D., Buchanan T., Gagnier M., Guthrie J.L., Jardine C.M., Marchand-Austin A., Massé A., McClinchey H., Nirmalarajah K., Aftanas P., Blais-Savoie J., Chee H-Y., Chien E., Yim W., Goolia M., Suderman M., Pinette M., Smith G., Sullivan D., Rudar J., Adey E., Nebroski M., Côté M., Laroche G., McGeer A.J., Nituch L., Mubareka S., Bowman J., (2022) Highly divergent white-tailed deer SARSCoV-2 with potential deer-to-human transmission. bioRxiv. doi: https://doi. org/10.1101/2022.02.22.481551
72. Vandegrift K.J., Yon M., Surendran-Nair M., Gontu A., Amirthalingam S., Nissly R.H., Levine N., Stuber T., DeNicola A.J., Boulanger J.R., Kotschwar N., Aucoin
S.G., Simon R., Toal K., Olsen R.J., Davis J.J., Bold D., Gaudreault N.N., Richt J.A., Musser J.M., Hudson P.J., Kapur V., Kuchipudi S.V., (2022) Detection of SARSCoV-2 Omicron variant (B.1.1.529) infection of white-tailed deer. bioRxiv. doi: 10.1101/2022.02.04.479189
73. Murray Carolyn (2022) Utah mule deer diagnosed with COVID-19. www.kpcw.org/regionl/2022-03-29/utah-mule-deer-diagnosed-withcovid-19
74. Wernike, K., Fischer, L., Holsteg, M., Aebischer, A., Petrov, A., Marquart K., Schotte U., Schon I., Hoffman D., Hechinger S., Neubauer-Juric A., Blicke I., Mettenleiter T.C., Beer M., (2022). Serological screening in wild ruminants in Germany, 2021/2022: No evidence of SARS-CoV-2, bluetongue virus or pestivirus spread but high seroprevalences against Schmallenberg virus. Transbound. Emerg. Dis., 10.1111/tbed.14600.
75. Aguiló-Gisbert J., Padilla-Blanca M., Lizana V., Maiques E., Munoz-Baquero M., Chillida –Martinez E., Cardells J., Rubio-Guerri C., (2021) First Description of SARSCoV-2 Infection in Two Feral American Mink (Neovison vison) Caught in the Wild. Animals (Basel). 11: 1422.
76. Mahajan S., Karikalan M., Chander V., Pawde A. M., Saikumar G., Semmaran M., Lakshmi P.S., Sharma M., Nandi S., Singh K.P., Gupta V.K., Singh R.K., Sharma G.K., (2022) Detection of SARS-CoV-2 in a free ranging leopard (Panthera pardus fusca) in India. Eur. J. Wildl. Res., 68(5) 59. doi: 10.1007/s10344-022-01608-4
77. Robinson S., Kotwa J., Jeeves S., Himsworth C., Pearl D., Weese J., Lindsay R., Dibernardo A., Toledo N.P.L., Pickering B., Goolia M., Chee H-Y., Blais-Savoie J., Chien E., Yim W., Yip L., Mubareka S., Jardine C., (2022). Surveillance for SARS-CoV-2 in Norway rats (Rattus norvegicus) from southern Ontario. Transbound. Emerg. Dis. DOI: 10.22541/au.166214344.47276029/v1
78. Roundy C.M., Hamer S.A., Zecca I.B., Davila E.B., Auckland L.D., Tang W., Gavranovic H., Swiger S.L., Tomberlin J.K., Fischer R.S.B., & Hamer, G.L., (2022). No Evidence of SARS-CoV-2 Among Flies or Cockroaches in Households Where COVID-19 Positive Cases Resided. J. Med. Entomol., 59(4),1479–1483. https:// doi.org/10.1093/jme/tjac055
79. Grimm David (2020) Should pets be tested for coronavirus? www. sciencemag.org/news/2020/03/should-pets-be-tested-coronavirus
80. COVID-19 ELISA TEST for veterinary use: Innovative Diagnostics: https:// www.innovative-diagnostics.com
81. Chavda V.P., Feehan J., Apostolopoulos V., (2021) A Veterinary Vaccine for SARS-CoV-2: The First COVID-19 Vaccine for Animals. Vaccines (Basel). 9(6):631. doi: 10.3390/vaccines9060631.
EDUCAȚIE ȘI FORMARE:
01 octombrie 2009 – prezent; conf. univ dr.; FMV Cluj-Napoca; 01 octombrie 2006 - 01 octombrie 2009; lect. univ. dr.; FMV Cluj
pentru Siguranța Alimentelor Cluj – Biroul de Identificare
Înregistrare a Animalelor; 05 mai 2003 - 01 ianuarie 2004; veterinar - domeniul promovare și vânzări produse veterinare; SC Maravet SA; 27 mai 2000 - 27 martie 2003; veterinar - coordonarea producției și a sănătății animalelor; PIC (Pig Improvement Company) România; 15 februarie 1999 - 15 mai 2000; asist. univ. drd.; FMV Cluj-Napoca; 10 ianuarie 1996 - 15 februarie 1999; prep. univ. drd.; FMV ClujNapoca.
08 mai 2014 – 08 august 2014 (08 – 25 mai la UFL; 02 iunie – 08 august the Online PHC6313 Environmental Health Concepts); Certificate in One Health; U.S. Department of Health and Human Services (University of Florida), College of Public Health and Health Professions, Department of Environmental and Global Health, Gainesville (U.S.A.); 15 ianuarie 2011 – 30 septembrie 2011; Diplomă în Administrație Publică și Administrare în Domeniul Veterinar; FMV Cluj-Napoca; 05 ianuarie 2011 – 06 februarie 2011; Certificat de finalizare studii; Influenza Laboratory Training Program; U.S. Department of Health and Human Services (University of Florida), Global Health Laboratory, Gainesville (U.S.A.); 19 noiembrie 2006 – 09 decembrie 2006; absolvent cursul “Modernizing Agricultural Knowledge & Information Systems Project (MAKIS)”; Institutul Van Hall (Universitatea de Științe Aplicate) din Leeuwarden (Olanda); 1998 – 2002 (absolvent); Școala Doctorală; doctorat în microbiologie, diagnostic de laborator; FMV Cluj-Napoca; 01 septembrie 1998 – 30 noiembrie1998; absolvent Programul Epi-Ro-Vet Program: Rolul Epidemiologiei în Medicina Veterinară; Facultatea de Medicină Veterinară - Universitatea Tehnică din Lisabona (Portugalia); 01 octombrie 1990 - 01 iulie 1996 (absolvent); student; FMV Cluj-Napoca; 1985 - 1989 (absolvent); elev profilul mecanic-agricol; Liceul Agro-Industrial nr. 9 din Cluj-Napoca.
PUBLICAȚII: 120 de articole științifice; Prezentări orale la diverse manifestări științifice: 7; Colaborări la realizarea de cărți științifice: 10; Membru în colective de cercetare/contracte de cercetare: 13.
328
Vol VII - Nr. 37 (5) 2022
CV Conf. univ. dr. Sorin RĂPUNTEAN FACULTATEA DE MEDICINĂ VETERINARĂ (FMV) DIN CADRUL UNIVERSITĂȚII DE ŞTIINŢE AGRICOLE ŞI MEDICINĂ VETERINARĂ DIN CLUJ-NAPOCA Domenii de interes: Microbiologie/Epidemiologie EXPERIENȚĂ PROFESIONALĂ:
Napoca;
Veterinară și
01 aprilie 2004 - octombrie 2017; consilier superior; Direcția Sanitară
și
REVIEW
(review)
Susceptibility of domestic and wild animal species to SARS CoV-2 naturally infection
PORTOFOLIU
n Reviste știinţifice și de informare in domeniul sanitar și veterinar, ce oferă un conţinut editorial de actualitate la cel mai înalt nivel, realizate în parteneriat cu profesori doctori renumiţi în domeniu, KOL, având girul societăţilor, asociaţiilor și instituţiilor importante din România

Reviste științifice dedicate profesioniștilor din domeniul veterinar


Reviste științifice dedicate profesioniștilor din domeniul sanitar

n Organizare de evenimente științifice și de premiere dedicate profesioniștilor din sistemul sanitar și veterinar






n Realizare ghiduri medicale, proiecte speciale, cărți, broșuri, materiale și produse dedicate targetului dvs.
n E-mailing - creare și trimitere de newslettere personalizate
n Creaţie & DTP - servicii complete de grafică computerizată pentru realizarea de publicaţii, cărți, ghiduri, vizualuri, materiale promoționale, invitații, bannere, roll-up-uri, pliante, flyere etc. (project management, concept, layout, realizare grafică)
n Realizare website-uri.

n Realizare cursuri online dedicate specialistilor din domeniul sanitar și veterinar
www.innovationinhealth.ro









Cite this article: R.N. Mălăncuș. Comparison between the post aggressive systemic reaction and the general adaptation syndrome.
Rom J Vet Med Pharm. 2022; Vol. VII 37(5):330-332.
COMPARAȚIE ÎNTRE REACȚIA SISTEMICĂ
POST AGRESIVĂ ȘI SINDROMUL GENERAL DE ADAPTARE
COMPARISON BETWEEN THE POST AGGRESSIVE SYSTEMIC REACTION AND THE GENERAL ADAPTATION SYNDROME
OPEN ACCES JOURNAL
Corresponding author: Răzvan Nicolae Mălăncuș, E-mail: razvanmalancus@uaiasi.ro
Recieved: October 2022
Accepted: November 2022
REZUMAT
Din categoria reacțiile nespecifice, reacția sistemică post-agresivă este considerată modelul reacției organismului în toate situațiile care tind să dezechilibreze activitățile normale, considerată cheia reacțiilor nespecifice ale organismului. Totodată, sindromul general de adaptare, de asemenea o reacție nespecifică a organismului, reprezintă o altă formă de răspuns al acestuia în fața agresorilor care provin din mediul înconjurător.
Diferența prin care se manifestă stresul și reacția nespecifică în fața agresiunii ține atât de intensitatea agentului cauzal, cât mai ales de durata expunerii organismului la acțiunea acestuia.
CUVINTE-CHEIE:
stres, reacție sistemică post agresivă
ABSTRACT
From the category of non-specific reactions, the post-aggressive systemic reaction is considered the pattern of the body’s reaction in all situations that tend to unbalance normal activities, considered the key to the body’s non-specific reactions.
At the same time, the general adaptation syndrome, also a non-specific reaction of the body, represents another form of its response to aggressors coming from the environment.
The difference between the stress and the non-specific reaction to the aggression depends both on the intensity of the causative agent and especially on the duration of the body’s exposure to its action.
KEYWORDS: stress, post aggressive systemic reaction
330 REVIEW
Vol VII - Nr. 37 (5) 2022
Comparison between the post aggressive systemic reaction and the general adaptation syndrome
Șef lucr. dr. Răzvan Nicolae Mălăncuș Universitatea de Ştiinţele Vieții „Ion Ionescu de la Brad” Iaşi, Facultatea de Medicină Veterinară Iași, Aleea Mihail Sadoveanu 8, 700489, Iași
Preocupările medicinei vizează stabilirea mecanismelor de producere a bolilor și modul în care acestea pot fi combătute astfel încât, prin întreaga conduită terapeutică, se încearcă restabilirea echilibrului funcțional, complex și dinamic, întâlnit în starea de sănătate.

În condiții normale, homeostazia rămâne constantă fără un efort energetic din partea organismului, reacțiile adaptative folosind rezervele funcționale într-o manieră raționala și, totodată, economică.
În cazul presiunii crescute din partea mediului ambiant, organismul apelează la rezerve de energie prin mecanisme suplimentare (compensatorii), care mențin activitățile vitale în conformitate cu noile cerințe. Se realizează, astfel, un nou echilibru ce necesită un consum de energie sporit.10
Mecanismele compensatorii, deși funcționează similar cu mecanismele adaptive, sunt neeconomice, participând la o scădere bruscă a rezervelor funcționale ale corpului. Intervenția mecanismelor compensatorii maschează o deficiență funcțională a organismului, dând aparența de normal. Mecanismele compensatorii presupun riscul perturbării proceselor funcționale, apariția ineficienței compensației și trecerea de la starea de sănătate la boală. Momentul exact al trecerii de la normal la patologic este foarte greu de stabilit, uneori chiar imposibil.6, 10
Organismul răspunde la schimbările de mediu cu un complex de reacții adaptative, folosind aceleași mijloace funcționale atât pentru a se adapta nevoilor curente ale vieții, cât și pentru a răspunde tendințelor perturbatoare ale mediului.
Spre deosebire de agenții agresivi care pot acționa la infinit, reacțiile adaptative sunt limitate în timp. Depășirea acestor limite poate conduce la transformarea acestor reacții adaptative în adevărate verigi patogenetice.7
Din categoria reacțiile nespecifice, reacția sistemică post-agresivă este considerată modelul reacției organismului în toate situațiile care tind să dezechilibreze activitățile normale, fiind considerată cheia reacțiilor nespecifice ale organismului.
Totodată, sindromul general de adaptare, de asemenea o reacție nespecifică a organismului, reprezintă o altă formă de răspuns al acestuia în fața agresorilor care provin din mediul înconjurător.8
Dacă în sindromul general de adaptare agenții etiologi sunt descriși ca fiind exclusiv exogeni, așa numiții factori stresanți, în reacția sistemică post-agresivă agenții etiologici nu se limitează apartenenței la un anumit mediu, intern sau extern. Cele două moduri de prezentare a capacității organismului de a face față destabilizărilor produse de către acești agenți cauzatori de boală se evidențiază printr-o evoluție asemănătoare din punct
de vedere a etapelor descrise și identificate pe parcursul răspunsului furnizat de către organism.8
Dacă reacția sistemică post-agresivă se desfășoară în trei faze - faza catabolică, de tranziție și faza anabolică - asemenea este și sindromul general de adaptare sau teoria despre stres descrisă inițial de Canon și Selye, unde se observă o evoluție stadializată similară, remarcându-se 3 faze distincte: faza de alarmă, faza de rezistență și cea de epuizare.
Deși distincte din punct de vedere a genezei și a modului de evoluție și interpretare a schimbărilor întâlnite la nivelul organismului, cele două reacții sunt similare prin capacitatea de activare a principalelor sisteme energo-genetice în vederea creșterii posibilităților intrinseci de adaptare și apărare.4
Atât în reacția sistemică post agresivă, cât și în sindromul general de adaptare prima fază este dominată de activarea sistemelor simpatico-adrenergic și hipotalamo-hipofizo-adrenocortical.1
Stimularea sistemului simpatico-adrenergic conduce la creșterea concentrației adrenalinei, acest mecanism fiind rapid, energic și de scurtă durată.
Reacția catecolaminergică în stres și în reacția sistemică post-agresivă este produsă prin stimularea sistemului catecolaminergic central (centri nervoși simpatici situați la diferite niveluri ale sistemului nervos central) și a sistemului catecolaminergic periferic, reprezentat de zona medulară a glandei suprarenale și terminațiile simpatice. În sindromul general de adaptare, hidroxilaza este activată de până la 50 de ori, față de doar 5 în condiții normale.2, 5
Efectele stimulării adrenalinei sunt întărite și completate de angajarea lentă în acțiune a sistemului hipotalamo-hipofizo-corticoadrenal, cu secreții mari de hormoni glucocorticoizi. Hormonii de creștere, tireotrof, prolactina etc. interferează și ei în cele două reacții nespecifice de adaptare/ apărare, crescând activitatea metabolică și posibilitățile reactive ale organismului.3
Diferențele principalele întâlnite în cele două răspunsuri ale organismului în fața agresiunii se observă gradual începând cu cea de-a doua fază de evoluție. Dacă faza de tranziție sau intermediară se caracterizează printr-o limitare a reacțiilor catabolice cu trecerea treptată în faza anabolică, dominată de activitatea parasimpatică și hormonii anabolizanți, cea de-a doua fază a sindromului general de adaptare, faza de rezistență, este caracterizată prin hipertropia și hiperplazia glandei corticoadrenale, aceasta putându-și mări volumul cu până la 20% - ceea ce conduce la o creștere a secreției hormonale.
Concentrația predominantă a glucocorticoizilor (cortizon, hidrocortizon) susține hiperglicemia, stimulând, în același timp, o acțiune inhibitoare
331 Vol VII - Nr. 37 (5) 2022
Romanian Journal of Veterinary Medicine & Pharmacology
R.N. Mălăncuș
asupra proceselor inflamatorii. La nivel sanguin, se observă o creștere a numărului de leucocite, realizată mai ales prin creșterea neutrofilelor, dar, în același timp, se observă și scăderea numărului de limfocite și eozinofile.
Aceasta este etapa în care rezistenta organismului crește în defavoarea agresorului, dar scade în fața celorlalți agresori.6
Spre deosebire de faza intermediară descrisă în reacția sistemică post agresivă, în care se face trecerea treptată spre vindecare, în cazul teoriei despre stres, dacă organismul nu reușește să învingă agresiunea în această etapă, rezervele metabolice se epuizează, glandele limfatice încep să se atrofieze, apar ulcerații în tractul digestiv și scade numărul de eozinofile, modificări care vor conduce la o degradare continuă a posibilităților de apărare a organismului.9
Ultimele etape ale celor două modalități de răspuns a organismului în fața agresiunii sunt prezentate total distinct. În faza de epuizare a sindromului general de adaptare, ca o consecin -
Bibliografie
1. Carrol TB et al. Glucocorticoids and adrenal androgens. In: Gardner DG et al, eds. Greenspan’s Basic & Clinical Endocrinology, 9th ed. McGraw-Hill, 2011.
2. Cooper C.L. Handbook of Stress Medicine and Health, CRC Press. 1995.
3. Hall JE. Guyton and Hall Textbook of Medical Physiology. 12th ed. Philadelphia, PA: Saunders Elsevier; 2011:285–301, 177–189, 870–871, 355–360, 379–396, 955–967.
4. Koeppen BM, Stanton BA. Berne & Levy Physiology. 6th ed. Philadelphia, PA: Mosby Elsevier; 2010:346–353, 594–663, 699–705, 636–650.
5. Kumar V, Abbas AK, Fausto N, et al., eds. Robbins and Cotran Pathologic Basis of Disease. 8th ed. Philadelphia, PA: Saunders Elsevier; 2010:412–414.
ță a solicitărilor excesive și prelungite, organismul ajunge la o reducere drastică a abilităților sale reactive și în cele din urmă la moarte. Comparativ, faza anabolică a reacției sistemice post agresive se caracterizează printr-o recuperare graduală.
Deși distincte din punct de vedere evolutiv, cele două reacții se prezintă ca modalități reactive ale organismului declanșate odată cu inițierea acțiunii patogenului. Mai mult decât atât, sindromul general de adaptare poate fi văzut ca parte integrantă a reacției sistemice post agresive, fiind inclus în acest răspuns de tip nespecific. Diferența prin care se manifestă stresul și reacția nespecifică în fața agresiunii ține atât de intensitatea agentului cauzal, cât mai ales de durata expunerii organismului la acțiunea acestuia.
This work is licensed under a Creative Commons Attribution-NonCommercialNoDerivatives 4.0 International License.

6. Kumar V, Abbas AK, Fauusto N, et al. Robbins Basic Pathology. 8th ed. Philadelphia, PA: Saunders Elsevier; 2010:3–42. 2006;7:589–600.
7. Rhoades RA, Bell DR. Medical Physiology. 4th ed. Philadelphia, PA: Wolter Kluwer Health | Lippincott Williams & Wilkins; 2013:20–33, 427–470, 282–287, 451–470.
8. Strayer DS, Rubin E. Environmental and nutritional pathology.
In: Rubin R, Strayer CS, eds. Rubin’s Pathology: Clinicopathologic Foundations of Medicine. 6th ed. Philadelphia, PA: Lippincott Williams & Wilkins; 2012:293–328.
9. Tamashiro KL, Sakai RR, Shively CA, Karatsoreos IN, Reagan LP. Chronic stress, metabolism, and metabolic syndrome. Stress 2011;14: 468-474.
10. Wylie CM. The definition and measurement of health and disease. Public Health Reports. 1970;85(2): 100-4.
de la Brad” Iași – Facultatea de Medicină Veterinară 01 Octombrie 2008 - Octombrie 2012 Doctorand Teza de Doctorat: ”Utilizarea tehnicilor de imagistică medicală pentru optimizarea diagnosticului afecțiunilor gastrointestinale la câine”. University of Liverpool. Small Animal Teaching Hospital, Leahurst
01 Martie 2011 - 01 Iunie 2011 Stagiu de pregătire.
Disciplinele principale studiate: Diagnostic ecografic, Diagnostic radiologic, Diagnostic endoscopic, Fiziologie/Fiziopatologie digestivă, Microbiologie. Universitatea de Științe Agricole și Medicină Veterinară ”Ion Ionescu de la Brad” Iași – Facultatea de Medicină Veterinară
01 Octombrie 2008 - 01 Martie 2010 Master în Medicină Veterinară, specializarea Clinică și terapie veterinară. Lucrare de Disertație: ”Diagnosticul ecografic al afecțiunilor gastrointestinale la câine”.
Disciplinele principale studiate: Diagnostic ecografic, Diagnostic radiologic, Patologia animalelor exotice.
2012-prezent

Activităţi si responsabilităţi principale: Cercetare. Activități didactice cu studenții
Universitatea de Științe Agricole și Medicină Veterinară ”Ion Ionescu
Universitatea de Științe Agricole și Medicină Veterinară ”Ion Ionescu de la Brad” Iași – Facultatea de Medicină Veterinară
01 Octombrie 2002 - 01 Iulie 2008 Doctor medic veterinar. Lucrare Licență ”Diagnosticul paraclinic al hepatopatiilor la bovine”.
Vol VII - Nr. 37 (5) 2022 332 REVIEW
CV Şef. lucr.
–
dr. Răzvan Nicolae MĂLĂNCUȘ UNIVERSITATEA DE ŞTIINŢELE VIEȚII ”ION IONESCU DE LA BRAD” IAȘI
FACULTATEA DE MEDICINĂ VETERINARĂ - DISCIPLINA FIZIOLOGIE ȘI FIZIOPATOLOGIE ANIMALĂ
Comparison between the post aggressive systemic reaction and the general adaptation syndrome
Dragi colegi, am înființat Editura ”HERMANN”, în anul 2015, în primul rând cu gândul la voi, oferindu-vă o platformă de publicare independentă, contextul ”Sibiu Capitală Culturală Europeană” fiind unul evident favorabil.
Am avut mereu certitudinea că, în această nobilă profesie, gândirea medicală se formează numai prin lectura începută din liceu și, desigur, accentuată în facultate, urmând ca, mai apoi, toată viața medicul să aibă, prin citit, o reală preocupare intelectuală. Să existe o legătură între capacitatea de diagnostic și preocupările medicului veterinar către lectură? Cu siguranță! Atunci când medicul este preocupat de istorie, filosofie, eseistică, memorialistică sau poezie, fără să mai amintim muzica de calitate, teatrul și arta în general, cu siguranță diagnosticul și terapia vor avea noi reprezentări, mult mai bine calibrate în raport cu evoluția fiecărui caz.
Voi avea mereu bucuria să sprijin colegii care au un manuscris gata de publicat, fie că este unul din domeniul științific, fie din alt gen literar.
Vă invit să parcurgeți și paginile site-ului oficial al editurii www. editurahermann.com
Dr. Cristian Valentin Iosif, proprietarul Editurii ”Hermann”

PERSONALITĂȚI ALE PROFESIEI, ÎN DOSARELE SECURITĂȚII
PERSONALITIES, IN SECURITY'S FILES
SECURITATEA ROMÂNĂ
ORGANUL REPRESIV PRIN CARE PARTIDUL COMUNIST A IMPUS DICTATURA ÎN ROMÂNIA
[PARTEA A TREIA]
SECURITATEA – INSTITUȚIA SOVIETIZĂRII ROMÂNIEI
Continuând descrierea, constatăm faptul că în România ”organele” Securităţii Române, în munca lor operativă, răspundeau numai în faţa primilor secretari ai comitetelor regionale ale Partidului Muncitoresc Român (P.M.R.). Mai precis, partidul – comunist, desigur (prin intermediul prim secretarilor) dirija activitatea Securităţii Române. Existența medicinei veterinare din ţara noastră era decisă de ace ș ti lideri comuni ș ti.
În societatea care se forma, impusă de partidul unic, a existat mereu o împotrivire a populaţiei. Tinerii trebuie să ș tie acest lucru, la fel ș i generaţiile viitoare. Medicii veterinari, apropiaţi prin construcţia umanistă de ș tiinţele naturale, priveau cu consternare tabloul social oferit de om, ca fiinţă biologică. Apropiaţi mai mult de biologic, de natură, de peisajul celorlalte specii, priveau miraţi evoluţia societăţii umane spre totalitarism. Cum este posibil un astfel de model de organizare socială la o specie superioară? Cine dirijează aceste mecanisme de mutilare a sufletului unei comunităţi – pentru reuș itele unui grup – în acele vremuri, partidul comunist?
Acţiunile Securităţii Române erau, de asemenea, orientate ș i împotriva cetăţenilor străini. Erau vizate, bineînţeles, și persoanele care aveau contacte cu cetăţeni străini; era verificată corespondenţa acestora.
TRUPELE MILIȚIEI
În caz de nevoie (peste tot la nivel regional) Securitatea Română avea dreptul de a subordona trupele Miliţiei. Introducem alţi termeni: forţele
imperialiste, activităţi du ș mănoase, persoane suspecte, elemente infractoare etc. Cetățenii puteau fi arestaţi oricând, în timp ce martorii se supuneau interogatoriului. Excepţia privea liderii comuni ș ti ș i deputaţii Marii Adunări Naţionale. Organele conducătoare ale partidului – adică boșii comuniști, mai pe înţelesul noilor generaţii – erau protejaţi, aveau imunitate – Securitatea Română neputând să le atingă penajul.
GULAGUL ROMÂNESC
Apăruseră aresturile ș i închisorile. Începeau anchetele. Cel deţinut se afla la dispoziţia Securităţii Române. Luase na ș tere termenul crimă de stat. Între timp, organele Securităţii Române primeau, pe lângă salariu, ș i o primă aferentă gradului militar deţinut. Mai încasau un grad ș i, eventual, o încă o primă în situaţia în care se remarcau prin arestarea unui contra-revoluţionar important forței de ocupație.
Au existat, în medie, 120 de închisori ș i lagare de muncă în care ș i-au pierdut viaţa sute de mii de români. Cifra avansată de către dr. Florin Matrescu este de 891.500 morţi în genocidul comunist comis între actualele granițe ale României. Holocaustul Ro ș u a produs mai multe victime decât nazismul.
Familiile securi ș tilor se bucurau de privilegii. Partidul comunist i-a considerat trădători pe toți cei care nu doreau să se subjuge intereselor sale, căci de doctrină nu putem să vorbim. [1945-1954]. Agenturile serviciilor de spionaj imperialiste, serviciile de spionaj inamice – iată noi termeni. Se temeau continuu ace ș ti noi revoluţionari. Comunismul a fost impus în ţara
Vol VII - Nr. 37 (5) 2022 334 VET HISTORY - PERSONALITIES Personalities, in Security's files
Dr. Cristian Valentin Iosif Medic veterinar clinician la „Hermann VET” – Cabinet de medicină veterinară Sibiu
noastră, Securitatea Română și partidul comunist având rolul cel mai important în această ecuaţie.
OFIȚERII ANCHETATORI
Identificăm o altă temă: ofiţerii de Securitate realizau percheziţii secrete, umblau după documente, erau peste tot. Dar cel mai grav este faptul că aveau dreptul să interogheze orice martor doreau, inclusiv militari. ”Legal”. Puteau reţine o persoană pentru 48 de ore, după care decideau dacă este eliberată sau arestată în continuare. O activitate specială a Securităţii Române era racolarea de informatori. Au structurat, în acest fel, reţele de informatori.
Activitatea subversivă dusă de elemente expropriate – o altă frază tipică. Ne imaginăm tragedia acelor familii. Trădătorii clasei muncitoare – un alt termen care descrie incitarea conflictului între clasele sociale. Activităţile subversive sub paravanul cultelor, este un alt exemplu.

SECȚIILE SECURITĂȚII
Biroul 3 din secţia politici subversive din direcţiunile regionale categoria I ș i II – urmărea, printre altele, activitatea studenţilor, dar ș i a liber profesioni ș tilor.
Ș i studenţii facultăţii de medicină veterinară din Bucure ș ti erau în vizorul informatorilor. Sec-
ţia de contrasabotaj recruta informatori din toate structurile societăţii. Securiștii aveau dreptul să ancheteze un student, în calitate de martor. Aveau dreptul să efectueze percheziţii, să verifice corespondeţa.
Mult mai grav este că puteau să solicite, oricărui conducător al unei unităţi de învăţământ, informaţii cu privire la studenţi și cadre didactice. Mai mult de atât, indiferent de calitatea profesională, acea persoană putea fi dată afară din instituţie/loc de muncă – fie că vorbim despre un student, un inginer, un ţăran sau un muncitor oarecare. Ace ș ti oameni erau numiţi elemente du ș mănoase.
Biroul 3 din cadrul secţiei de sabotaj era cel care se ocupa de problemele: comerţul alimentar, zootehnie, agricultură în formă privată, sector animalier etc.
SECȚIA DE FILAJ ȘI INVESTIGAȚII
O categorie aparte în organizarea Securităţii o constituia Secţia de filaj ș i investigaţii. Cei ce lucrau acolo puteau să reţină orice persoană. Simpla opinie/părere ce transmitea faptul că o persoană se opune unei investigaţii aducea respectiva persoană la Securitate în calitate de interogat, arestat. Aveau case special amenajate în acest context.
Realizau percheziţii, arestări; organizau reţele de informatori ș i racolau permanent martori. Dacă o persoană proteja pe cineva drag, depunând mărturii false, securi ș tii aveau dreptul de a o reţine ș i acuza.
Aveau o structură de organizare formată din mai multe birouri, fiecare cu responsabilităţi precise. Securitatea avea un birou de contrainformaţii ș i în cadrul Miliţiei. Ace ș ti funcţionari puteau fi racolaţi ca informatori. Arestările se făceau pe baza informaţiilor primite. Puteau să recruteze informatori ș i colaboratori chiar dintre cei arestaţi.
SECȚIA CADRE

Cei ce lucrau acolo aveau misiuni speciale și abilitatea de a recruta oameni loiali, care erau dispu ș i să servească interesele Securităţii. Verificau întreaga familie a candidatului, chiar avizau căsătoriile sau se pronunţau cu privire la un divorţ.
Printr-o secţie operativă, realizau ascultarea telefoanelor. Puteau să pătrundă în orice birou în acest sens. Realizau fotografii, cercetări grafologice sau chiar diferite proceduri ce ţin de laboratorul chimic. Controlau staţiile de radio-emisie. Bruiau emisiile posturilor de radio anti-sovietice sau a celor pe care le considerau împotriva regimului democratic din România. Aveau informatori în toate oficiile po ș tale. Ve -
335 Vol VII - Nr. 37 (5) 2022 Romanian Journal of Veterinary Medicine & Pharmacology C.V. Iosif
Doctorul Florin Matrescu (https://florinmatrescu.wordpress.com/curriculum-vitae/)
rificau corespondenţa ș i întocmeau rapoarte în diferite situaţii.
TOVARĂȘUL ALEXANDRU DRĂGHICI
La data de 27 mai 1952, este destituit din funcţie tovară ș ul Teohari Georgescu ș i este nu -
mit tovară ș ul Drăghici Alexandru la Ministerul Afacerilor Interne. În prezidiul ș edinţei Marii Adunări Naţionale îl regăsim pe I. C. Parhon. Au decis acest lucru tovară ș ii: Gheorghiu-Dej, Al. Moghioro ș , Gh. Apostol, M. Constantinescu, E. Bodnăra ș , Chivu Stoica ș i C. Pârvulescu. (În

Vol VII - Nr. 37 (5) 2022 336 VET HISTORY - PERSONALITIES Personalities, in Security's files
anul 1946, Majestatea Sa Regele Mihai I fondase Institutul de Endocrinologie, atribuind numele profesorului – «C. I. Parhon»). În 18 septembrie 1952, Alexandru Drăghici devine ministru al Securităţii Statului. În 1956, are loc o reorganizare a Departamentului Se -

curităţii Statului. În acest fel, clasa muncitoare, ţărănimea muncitoare ș i intelectualitatea progresistă primeau un rol determinant. Interesant este faptul că se decid activităţi de monitorizare în ţări precum Anglia, Franţa, Germania Federală sau USA. Se permit recrutări din toate segmen-

337 Vol VII - Nr. 37 (5) 2022 Romanian Journal of Veterinary Medicine & Pharmacology C.V. Iosif
tele profesionale, dar ș i din rândul membrilor de partid, dar cu acordul Primului Secretar din raioane.
Prin Biroul 1 ș i Biroul 2 s-a efectuat urmărirea celor care activau în domeniul artistic, a
studenţilor ș i tinerilor în general. S-au efectuat numeroase anchete, racolări de informatori, dar ș i arestări. Direcţia “Lupta Contra Activităţii Politice Subversive” avea activitate în facultăţi. Prin Biroul 2, erau supravegheaţi studenţii, ele -

Vol VII - Nr. 37 (5) 2022 338 VET HISTORY - PERSONALITIES Personalities, in Security's files
vii, dar ș i corpul profesoral. Direcţia „Lupta cu Contrarevoluţia Economică” serviciul V, Biroul 1 – viza probleme din agricultură ș i cre ș terea animalelor.
PROFESIILE SECURIȘTILOR

Un maior de securitate este cazangiu, altul frezor. Profesiile de bază continuă în aceela ș i mod: maior – de profesie muncitor necalificat; colonel de securitate – de profesie lăcătu ș ; co -
lonel – de profesie strungar în fier; maior – de profesie ajustor mecanic; maior – de profesie tipograf/zețar. Anii trec, metodele rămân; [6 mai 1966 – locotenent colonel – profesia de bază lăcătu ș ajustor. 25 mai 1967 – maior de profesie cazangiu. Exemplele sunt numeroase].
ACTIVITATEA SECURITĂȚII
Este evident faptul că separaţia este un obiectiv ce ţine de natura premiselor, categoriile ur-

339 Vol VII - Nr. 37 (5) 2022 Romanian Journal of Veterinary Medicine & Pharmacology C.V. Iosif
mărite fiind diferite. Pe de o parte identificăm activitatea dusă împotriva du ș manului de clasă, a chiaburimii, a marilor negustori, mo ș ieri expropriați etc., pe de altă parte sunt legionarii.
În plus, evidențiem păturile sociale obișnuite, care au trăit ocupaţia sovietică ș i instalarea regimului comunist, oameni care nu neapărat s-au opus comunismului, însă nu au dorit să devină comuni ș ti, nu au fost de acord cu absurditatea regimului. Acești cetățeni nu făceau politică, însă se treziseră într-un regim incompatibil unei societăţi libere, democratice.
TERMENII TOTALITARISMULUI
Am identificat inventarea de noi definiții: posturi de radio imperialiste, democraţie populară, funcţionarii ambasadelor imperialiste, elemente capitaliste de la ţară, partide reacţionare dizolvate. În realitate, Securitatea se implica în impunerea regimului comunist dictatorial, orice cetățean putând deveni victimă: cetăţenii care aveau relaţii de familie cu membrii ai ambasadelor, fo ș ti proprietari de terenuri agricole, mici întreprinzători, intelectuali, țărani liberi etc.
DECRETUL NR. 6 DIN 14 IANUARIE 1950
Prevedea înființarea Unităţilor de Muncă –locul unde vor fi încartiruiți cei care se opun noii orânduiri. Securitatea se implică eficient. Se vorbe ș te despre durata reeducării, despre efectele reeducării în aceste unităţi de muncă. Cei care erau trimiși în astfel de locuri aveau întocmit un dosar, de către Securitate. În închisori, medicamentele de bază lipseau și medicii nu acționau în interesele pacienților. Nu se putea discuta despre o legătură medic-pacient, despre omenie, despre umanitate. Medicii, doctori ai Ministerului Afacerilor Interne (M.A.I.), erau o componentă a aparatului represiv. Nu existau tratamente pentru bolnavii cu afecțiuni cronice. La închisoarea din Aiud, medicul ș ef, cu grad de maior, fusese recunoscut de către un
Bibliografie
coleg arestat, ș ef de promoție, ca fiind unul dintre cei mai slabi studenţi în perioada facultăţii. Este foarte impresionantă atitudinea unui medic arestat politic, în refuzul său de a accepta să fie medic în Zacă, în condiţiile impuse de conducerea închisorii: „dumneavoastră puteți da ordine subalternilor ș i deținuților. Deci ș i mie, cât timp sunt un simplu deţinut. Ca medic, în exercițiul profesiunii, sunt însă suveran în hotărârile mele ș i nu-mi puteți da ordin! Căutați-vă deci pe altcineva, fiindcă eu nu accept să fiu medic în condiţiile ăstea!”. „Aici o să-ţi putrezească oasele, banditule!” - a fost răspunsul ofițerului politic.
Tipic pentru anii 1952, procesele se judecau cu ușile închise. Judecătorii realizau un rol al acuzatorului, iar procurorii foloseau demagogia de partid, susținând clasa muncitoare împotriva du ș manului burhezo-mo ș ieresc. Pe atunci, avocații aveau în regulă discursul marxist-leninist ș i ajungeau să facă rechizitoriul propriilor clienți, cerând condamnarea lor.
Cu ce seamănă tot acest tablou prezentat în articolul de față? Din păcate, cu prezentul, vizibil la Răsărit, în contextul actual politico-militar, unde confruntarea dictaturii cu libertatea a deraiat într-un război în care cel care a atacat primul poartă întreaga responsabilitate.
[Continuarea în numărul viitor]
Dr. Cristian Valentin Iosif este cercetător C.N.S.A.S. din anul 2015, cu tema de cercetare „Medicina Veterinară Românească – parcursul profesiei în totalitarism”.
This work is licensed under a Creative Commons Attribution-NonCommercialNoDerivatives 4.0 International License.
Cristian Valentin Iosif – „Medicina veterinară românească – personalități ale profesiei în dosarele securității” Vol I – Editura „Hermann”, Sibiu 2017. ISBN 978-606-9669-41-9. Colecția memorialistică. (Alte elementele de bibliografie secundară din articol sunt prezente în cartea precizată).

Vol VII - Nr. 37 (5) 2022 340 VET HISTORY - PERSONALITIES Personalities, in Security's files
CABINET
Scriitor, analist, proprietarul Editurii “Hermann”din februarie 2022, Cercetător acreditat C.N.S.A.S.
EXPERIENŢA PROFESIONALĂ
Absolvent al Școlii de Studii Postuniversitare de Medicină Veterinară, specializarea “Clinică şi Farmacie Veterinară” – studii 2 ani, promoția 1998. Absolvent al Facultăţii de Medicină Veterinară Bucureşti –studii 6 ani, promoția 1996. După absolvire, lucrează ca stagiar în cabinete bucureștene private. În paralel, înființează societatea „Hermann” şi pune bazele unui cabinet de medicină veterinară în Sibiu, astăzi cu o vechime de 20 de an i. În perioada 2000-2012 a publicat articole în presa sibiană, temele fiind diverse: de la specificul medical veterinar, la cel pe teme ecologice. Din 2 015 este cercetător acreditat C.N.S.A.S., cu tema de cercetare: „Medicina veterinară românească, parcursul profesiei în totalitarism, 1948-1989”. Cristian Valentin Iosif publică eseu, memorii, studii sociologice, etică profesională, studii de arhivă, documentaristică, note de disertație, poezie, teatru, cărți de călătorie și trăiește având convingerea că angajarea (engagement în limba franceză) este, în fapt, datoria etică a omului creator de idei de a se implica în dinamica societății căreia îi aparține și, mai ales, din care provine. Susține dizertații pe două teme: „Misiunea cercetătorului C.N.S.A.S.” şi „Etica în domeniul medical veterinar”. Desfășoară activitate de recenzie ca editor. Între 2005 şi 2017 a fost membru în comisia de Bacalaureat – Colegiul “D.P. Barcianu” din Municipiul Sibiu. A fost membru în Comisia Legislativă a C.M.V.R. în mandatul
2013-2016. Începând din 2021 publică articole în platforma ”CONTRIBUTORS.
CĂRȚI PUBLICATE: 2013 - „Dreptul de a pune condiţii” Editura Honterus, Sibiu – editura F.D.G.R. – Forumul German din România.; 2015 - „Amendament Vet” Editura ASTRA, Sibiu –Asociațiunea Transilvană pentru Literatura română şi Cultura Poporului Român.;
2015 - „Primul meu câine” la Editura Honterus Sibiu – fondul de idei fiind original, derivat din experienţa autorului; 2016 - „Medicina veterinară românească – Personalităţi ale profesiei în dosarele securităţii” – Volumul I, la Editura Hermann, Sibiu.
2017 - „Medicina veterinară românească – Personalităţi ale profesiei în dosarele securităţii” – Volumul II. la Editura Hermann, Sibiu.
2017 - „Tie Break – medicii veterinari vs. medicina veterinară”, la Editura Hermann, Sibiu.

2017 - „Este iepurele un animal de companie?”, la Editura Hermann, Sibiu.
2018 - „Etica în medicina veterinară”, la Editura Hermann din Sibiu.
2018 - „Tie Break – medicii veterinari vs. medicina veterinară”, ediția a-II-a revăzută, la Editura Hermann din Sibiu.
2019 -„Quantum Satis – şi studenții au suflet tovarășilor profesori…” Editura “Hermann”, Sibiu, 2019.
2019 -„Concesive” – volum de poezii. Editura “Hermann”, Sibiu.
2020 – ”Tunele și poduri” – teatru (dramaturgie și scenariu) - ”Editura Hermann” Sibiu.
2020 – ”VET Press, articole 2006-2009” - ”Editura Hermann” Sibiu.

2021 – ”Gigantul Gheție – o viață începută în libertate și apusă în totalitarism” - ”Editura Hermann” Sibiu. 2021 – ”Intersecţii la Camera Deputaţilor” - ”Editura Hermann” Sibiu.
2021 – ”La Revoluție” - ”Editura Hermann” Sibiu. 2021 –”Cuvinte către colegii mei” - ”Editura Hermann” Sibiu.
2021 – ”Halkidiki – o mie de kilometri la sud de Sibiu””Editura Hermann” Sibiu.
2021 – ”Neorânduiții” - ”Editura Hermann” Sibiu. 2021 – ”Sistemul concurenței” - ”Editura Hermann” Sibiu. 2021 – ”Impuls – 365 de zile între adeziune și demisie” - ”Editura Hermann” – Sibiu.
2021 – ”Principiul colegialității” - ”Editura Hermann” – Sibiu
341 Vol VII - Nr. 37 (5) 2022 Romanian Journal of Veterinary Medicine & Pharmacology C.V. Iosif CV
Dr. Cristian Valentin IOSIF
MEDIC VETERINAR CLINICIAN LA „HERMANN VET” –
DE MEDICINĂ VETERINARĂ SIBIU
REVISTĂ CREDITATĂ CU 15 PUNCTE ANUAL PENTRU ABONAMENTELE PLĂTITE

NOTĂ: Datele cu caracter personal colectate de la dvs. prin intermediul talonului de abonare sunt folosite DOAR in scopul pentru care au fost preluate, respectiv, abonarea la revistele noastre. După completare, vă rugăm să trimiteţi talonul însoţit de dovada efectuării plăţii scanate la adresa de email redactia.ihc@gmail.com. Mulţumim!

TALON DE ABONAMENT Doresc să mă
Varianta
q
- 170 RON
q
Nume:................................................................................... Prenume: ................................................................................................... Dna Dl Dra Adresă domiciliu: .................................................................................................................................................. Municipiu: ........................................................................ Sect.: ................ Judeţ:............................................................ Oraş:............ ..................................................... Comună: ...................................................................................................... Cod poştal: ................... Telefon:............................................................................. Număr atestat de liberă practică................................................................. Specialitate ........................................................................................ student rezident medic specialist medic primar Competenţă ............................................................................... Denumire instituţie: ....................................................... Domeniu de activitate: Privat Public Secţie: ................................................................................................. Funcţie: ...................................................................... Specialitate: ................................................................. Adresă instituţie: ............................................................................ .................................................... Municipiu: ....................................................Sect.: ........... Judeţ:................................. Oraş:............ ..................................................... Comună: ...................................................................................................... Cod
................... ............................ Telefon: ..........................................
........................................................................
ori transfer
abonez
digitală:
Abonament pentru 1 an (6 numere)
(cu toate taxele incluse)
Abonament pentru 2 ani (12 numere) - 300 RON (cu toate taxele incluse)
poştal:
Mobil: ...................................................... E-mail:
Web: ................................................................................................... CUI instituţie: Plătitor de TVA: da nu Factură - vă rugăm să completaţi cu coordonatele necesare emiterii facturii: Denumire persoană: ...................................................... Denumire instituţie: .................................................................. Adresa pentru primirea revistelor: Domiciliu Instituţie Data: / / Semnătură:…..………….….......… Plata abonamentului se va efectua prin ordin de plată
bancar pe coordonatele: S.C. INNOVATION IN HEALTH CENTER S.R.L SEDIUL SOCIAL: SOS. VIRTUȚII NR. 19D, SECTOR 6, BUCUREȘTI CUI: 38637290, R.C.: J40/20963/2017 CONT IBAN RON: RO91BACX0000001601177000 BANCA UNICREDIT BANK, SUCURSALA ORIZONT
!
Adeverinţa pentru abonarea la revistă se eliberează în maximum 2 zile lucrătoare de la exprimarea solicitării dvs., după efectuarea plății.
Editura Etna este înscrisă în Societatea Editorilor Români. Acreditată de Consiliul Naţional al Cercetării Știinţifice din Învăţământul Superior (CNCSIS) la poziția 241 și de Colegiul Medicilor din România.






CONTACT EDITURA ETNA Str. Anton Pann nr 18A, ap 1, Sector 3, Cod 030796, București Tel: +40727317800 E-mail: tarabic_octavia@yahoo.com

www.etna.ro
INNOVATION IN HEALTH AWARDS GALA


ORGANIZATOR